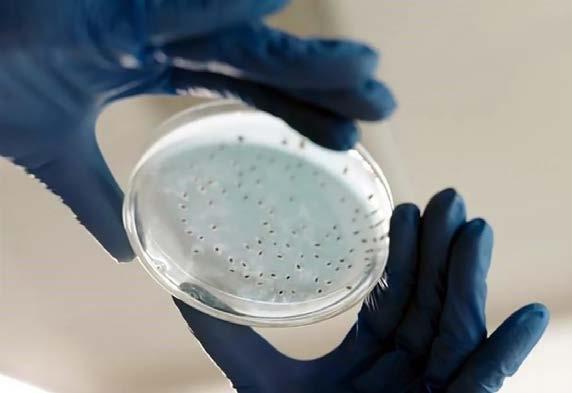

Ciudad

![]()





Ciudad

Existen otros casos de corrupción que ligan a Cepeda; iría Congreso tras investigación
TERESA QUIROZ
Zócalo | Saltillo
HOY:
14°C - 7°C
SÁBADO
TERESA QUIROZ Zócalo | Saltillo
El frente frío número 13 ingresará sobre el norte y noreste del territorio nacional. Este fenómeno interactuará con un canal de baja presión, generando vientos fuertes y chubascos en diversas regiones de Coahuila, informó el meteorólogo José Martín Cortés.
El experto señaló que durante las próximas horas se esperan chubascos en las regiones Carbonífera, Centro y Sureste, vientos de 15 a 25 km/h, con rachas de hasta 40 a 60 km/h y temperaturas mínimas de 0 a 5°C en zonas montañosas del estado.
Además, advirtió que las afectaciones climatológicas serán mayormente percibidas al centro-norte de la entidad, sin embargo, exhortó a toda la población a mantenerse al tanto del desarrollo de este sistema.
Dejará aumento al salario intactos créditos Infonavit
EDITH MENDOZA
Zócalo | Saltillo
Luego de las recientes modificaciones en la operación del Infonavit, el incremento al salario mínimo recientemente ajustado a 12%, ya no afecta a los usuarios del instituto, subrayó Gustavo Ernesto Díaz Gómez, titular del instituto en Coahuila.
“Todos los trabajadores deben sentirse seguros y protegidos, porque el 11 de noviembre, el director general Octavio Romero Oropeza anunció que todos los créditos en VSM están congelados… no van a subir, ni su saldo, ni su mensualidad para enero”, explicó el funcionario. z Negocios
Será desde el pleno de la 63 Legislatura donde se exija al Alcalde de Torreón, Román Alberto Cepeda, transparente el programa Iluminemos Torreón y a la Fiscalía Anticorrupción del Estado de Coahuila siga de oficio El punto de acuerdo donde se haga extensiva la solicitud de información y el llamado a la Fiscalía estará a cargo del legislador morenista Antonio Attolini, quien en entrevista en la mesa de análisis La Resistencia, en Tele Saltillo, retó al Edil lagunero a esclarecer los hechos que lo involucran en temas de corrupción y desvío de recursos.
“El derecho a la transparencia no está al contentillo del sujeto obligado, entonces vamos a solicitar al Ayuntamiento de Torreón que lo que el Alcalde se rehúsa a entregar, pues que lo entregue y que presente toda la documentación en versión electrónica, que pueda justificar la auditoría que requiere el programa Iluminemos Torreón”, dijo. Lo anterior tras recordar cómo Román Alberto Cepe-

Si a Román no se le pone un alto, el mensaje para los 37 alcaldes restantes es que pueden robar, mentir, traicionar, abusar y hacer lo que les dé la gana”. Antonio Attolini Diputado local por Morena Exigencia directa Antonio Attolini instó a Román Alberto Cepeda a devolver a los torreonenses los 4 millones de pesos gastados en la escultura del águila instalada sobre el Giro Independencia, para que sean invertidos en obras que verdaderamente beneficien a los torreonenses.
“Alcalde, le pasaré la cuenta para que deposite los 4 millones de pesos que vale ese pollo emplumado y escríbanme a qué colonia le podemos inyectar ese dinero”, señaló.
da se negó a dar explicaciones respecto a la investigación que lo involucra en un desvío de recursos de más de 3 millones de pesos, presuntamente destinados para la compra de focos ahorradores.
“Le voy a solicitar a la Fiscalía, dado que este es un caso público y notorio, haga una investigación de oficio al asunto presentado por Periódico Zócalo para poder deslindar responsabilidades, que no se necesite presentar
una denuncia, sino que el Congreso se lo pida”, señaló el diputado.
Existen antecedentes
El también torreonense recordó otros señalamientos donde se involucra a Román Alberto Cepeda en actos de corrupción como de la casa cuna, ahora Casa Nana, edificio que consideró un monumento a la corrupción, ya que sirvió para inflar los precios, retrasar la obra y simular eventos


z Desde el Congreso estatal, el diputado señaló que se exigirá una investigación sobre el caso a la Fiscalía Anticorrupción.
de recaudación (13) donde se invirtieron 40 millones de pesos y recaudaron menos de 4 millones de pesos.
El viaje de Bruselas, Bélgica, donde presuntamente el Alcalde de Torreón atraería una inversión para proyecto de drenaje pluvial importante, y gastó 700 mil pesos en vuelos, además de acusarlo de presuntamente robarse la elección de la Alcaldía, en la que ganó con una discrepancia de 40 mil votos.

Ciudad 6C
Seguridad


Se ponderará profesionalización Inicia en el estado homologación judicial
REDACCIÓN
Zócalo | Saltillo
Ayer, el Congreso local recibió la iniciativa para la homologación constitucional de la normatividad en materia judicial, en cumplimiento al mandato del Artículo Transitorio de la Reforma Judicial Federal, pu-
blicada el pasado 15 de septiembre del año en curso en el Diario Oficial de la Federación, la Constitución de Coahuila incluirá los nuevos lineamientos marcados por el Congreso de la Unión. Los cambios, que serán discutidos, y en su caso aprobados por el pleno de la Legis-
latura estatal, prevé 10 puntos principales, entre los que destacan las Elecciones Libres para Cargos Judiciales, es decir, constitucionalizar el derecho a ser electo y a elegir los cargos judiciales mediante elecciones libres, basadas en el voto universal, directo, libre y secreto.
15% de ajustes negativos a fondos y participaciones federales
Aplica 4T tijera de 150 mdp a Saltillo
ARTURO ESTRADA ALARCÓN
Zócalo | Saltillo
Finalmente, la tijera federal terminó por pegar a Saltillo. A causa de recortes a diversos fondos, de hasta 15%, el Gobierno municipal cerrará 2024 con un déficit de 150 millones de pesos en los ingresos federales presupuestados. De acuerdo con el tesorero Juan Carlos Villarreal Garza, se están tomando medidas para cumplir con todas las obligaciones, metas y dejar finanzas sanas a la gestión entrante.
z Página 2A



palaciorosa@redzocalo.com

ROMÁN
COMPLEJO DE NARCISO
Amigos del PRI están sentidos con el alcalde de Torreón, Román Alberto Cepeda, por el desaire que hizo al secretario de Gobierno, Óscar Pimentel González, durante su tercer informe, pues dicen que el funcionario estatal llevaba preparadas unas palabras y simplemente no lo dejaron hablar.
Otro motivo de molestia, es que no se le dio importancia al apoyo que el Gobierno del Estado ha tenido con Torreón, ya que Cepeda González se colgó todas las medallas en un acto de egocentrismo que rayó en la ridiculez.
A otros simplemente no les extraña. Román nunca se ha caracterizado por ser leal ni por trabajar en equipo.

DE ROBÁN PARA ROBÁN
No sólo a los organismos de la sociedad civil les ha prendido las alarmas que, la “autoentrega-recepción” del Alcalde de Torreón, será de sí para sí mismo.
Al respecto, el aguerrido diputado lagunero por Morena, Antonio Attolini Murra, ya levantó la ceja, se arremangó la camisa y con voz profunda señaló la acción.
Palabras más, palabras menos, Attolini advirtió que no va a permitir que se consume el acto de impunidad con ese proceso opaco y fraudulento; “Robán le va a entregar a Robán; ilógico pensar que habrá justicia”.
Aquí el consejo al diputado moreno es que no quite el dedo del renglón y haga lo propio en el Congreso, ante la Autoría Superior y en la Fiscalía Anticorrupción, en alguna ha de pegar el chicle.

MANOS A LA OBRA
Bajo el compromiso de institucionalidad, en el Congreso de Coahuila se recibió la iniciativa para la homologación constitucional de la normatividad en materia judicial, a fin de iniciar los trabajos pertinentes. Para la diputada presidenta del Legislativo estatal, Luz Elena Morales Núñez, no sólo se limita a dar cumplimiento, sino que ponderará la carrera y profesionalización judicial, asegurando que las personas a elegir cuenten con el perfil idóneo para fortalecer un Poder Judicial profesional, eficiente y de excelencia.
Destacó que con esta acción Coahuila se reafirma como una entidad de avanzada “que prioriza la seguridad, la competitividad, el estado de derecho y el desarrollo tanto económico como social”.

MARÍA BÁRBARA CEPEDA
LA MÁS APAPACHADA
Le fue de súper lujo a la secretaria de Vinculación Ciudadana, Proyectos de Innovación Social e Inversión Pública, María Bárbara Cepeda Boehringer; durante su comparecencia ante el Congreso del Estado, como parte de la glosa del Primer Informe de Manolo Jiménez. Y no sólo por los resultados, que han sido muchos y en muy poco tiempo, como lo reconocieron los legisladores; sino porque a los diputados de todas las bancadas les dio gusto volver a saludar a su excompañera, por lo que estuvo bien arropada y mejor recibida. En cuanto a los hechos, en sólo 10 semanas concretó la vinculación con acciones y programas con 26 empresas.

¡SANTOS RECORTES!
Ayer, el tesorero de Saltillo, Juan Carlos Villarreal Garza, dio la noticia de que los embates federales a las finanzas de la ciudad causaron mella, por un total de 150 millones de pesos. Un mundo de dinero, algo así como para comprar 184 patrullas totalmente equipadas, por poner un ejemplo.
Estos recortes llegan en mal momento, al finalizar la gestión, por lo que el equipo de la Tesorería está trabajando a todo vapor para realizar una reingeniería financiera, con la intención de que no se afecten las metas planteadas por el alcalde Chema Fraustro, como no dejar adeudos a proveedores y contratistas, así como dejar un dinerito a Javier Díaz para que arranque la gestión sin contratiempos.
Entre lo malo, lo bueno es que Juan Carlos ya veía venir el recorte, claro que no de ese tamaño, por lo que ya estaba tomando previsiones. En fin, seguimos en los tiempos estelares de la 4T.

“MARCA REGISTRADA”
Al súper delegado de Bienestar, Américo Villarreal Santiago, se le hizo fácil felicitar en sus redes sociales a un grupo de pequeños deportistas tamaulipecos, empleando el eslogan “somos más los buenos”. Quizá por tratarse de un foráneo, no sabe que esa frase es la que siempre usa en sus campañas políticas Jaime Bueno Zertuche, quien actualmente ocupa la dirección del Instituto Estatal de Educación Abierta, y no tiene mucha ciencia del porqué es su frase de guerra.
Así que la publicación de Américo júnior fue muy popular entre la clase política, pero no por las razones que él hubiera deseado.

REGRESO FORMAL
¿Se acuerdan del regreso de la Delegación Saltillo de la Profeco? Sí, la misma que fue anunciada ocho meses atrás, y que comenzó a operar a inicios de noviembre sin mobiliario; pues finalmente hoy tendrá su inauguración formal, encabezada por el titular de la Procuraduría del Consumidor en el estado, Galio Vega Ábrego.
Uno de los principales impulsores de esta oficina, junto con el alcalde Chema Fraustro, fue el diputado local, Alberto Hurtado; quien es muy amigo de Galio Vega. Así que esta se la damos por buena al legislador de Morena. Ojalá la Profeco jale bien este sexenio.

AL DEDILLO
La líder indiscutible del PAN en Coahuila, Elisa Maldonado, por fin dio luces sobre el proceso de “renovación” de la dirigencia estatal, pues la convocatoria saldrá para los últimos días del año, en plenas fiestas, como para agarrar a la gente en otras ocupaciones. Quizá no vaya a ser un traje a modo, pero así lo parece a la distancia. De entrada, la convocatoria será exclusiva para mujeres, por indicaciones del Comité Ejecutivo Nacional. Y antes de que las diputadas albiazules Elizabeth Aldrete, Edith Hernández y Blanca Lamas se apresten a apuntar, deben tomar en cuenta las letras chiquitas. De entrada, Maldonado Luna tiene opción de presentarse a la reelección y la ganadora de preferencia deberá llevar “la luna” en alguna parte del nombre.
Ordena el ICAI al Municipio entregar información; Ayuntamiento se lava las manos
KATHIA TORRES Zócalo | Torreón
A pesar de las múltiples solicitudes y las órdenes del Instituto Coahuilense de Acceso a la Información Pública, el Municipio de Torreón persiste en ocultar el gasto público destinado al concierto de Julio Preciado y Los 2 Carnales.
A través de diversas solicitudes de información, Grupo Horizonte Lagunero ha intentado conocer el monto exacto que le costó al erario público contratar a estos reconocidos artistas para la celebración de la Independencia de México y el 117 aniversario de la ciudad, sin embargo, las respuestas del Municipio han sido evasivas y contradictorias.
El 21 de agosto del 2024, a través de las redes oficiales del Ayuntamiento, se dio a conocer que el dueto originario de San Pedro de las Colonias y el solista de regional mexicano, estarían presentándose en la explanada de la Plaza Mayor, posterior a la ceremonia del Grito de Independencia. Desde ese momento, Horizonte Lagunero a través de solicitudes de información realizadas en la Plataforma Nacional de Transparencia, cuestionó al Municipio sobre el gasto que representaría la presentación de los artistas, sin que hasta el momento se obtenga una respuesta del monto efectuado.

En la primera solicitud de información con folio 051260800036324, la Tesorería Municipal, a través de la Dirección de Servicios Administrativos, aseguró que la información “se encuentra debidamente publicada en la página oficial del Ayuntamiento” torreon.gob.mx en la columna denominada, Contratos y Licitaciones, bajo el nombre Celebración del Grito de Independencia el 15 de Septiembre de 2024, que Servirá de Marco para la Celebración de los 117 Años de la Fundación de Torreón, Coahuila de Zaragoza, con el código CC/ SEC.PART/075/2024, por lo que fácilmente podría localizarse. Sin embargo, al buscarlo, los enlaces proporcionados no funcionan, permaneciendo así por lo menos desde el 3 de septiembre cuando se recibió la primera respuesta por parte del Gobierno municipal y hasta hoy en día. Ante la negativa de respuesta, se abrió una queja ante el Instituto Coahuilense de Acceso a la Información Públi-
Es segundo lugar nacional Llega NL a 10 mil casos de dengue
AGENCIA REFORMA
Zócalo | Monterrey, NL.
En una temporada atípica de dengue, Nuevo León rebasó esta semana los 10 mil casos.
Durante la semana 48 epidemiológica, del 25 de noviembre al 2 de diciembre, el estado sumó 383 casos y pasó de tener 9 mil 671 a 10 mil 054. De ellos, 6 mil 225 son casos de dengue no grave; 3 mil 472 de dengue con signos de alarma, y 357 de dengue grave.
El número de casos en esta última semana que registró la Secretaría de Salud federal sigue una tendencia a
la baja desde la semana 47, que comprendió del 18 al 25 de noviembre. Según datos del Gobierno federal, el número de decesos en Nuevo León se mantuvo en 12. Nuevo León permanece en el segundo lugar a nivel nacional en número de casos reportados, sólo debajo de Jalisco, que tiene 18 mil 943 en total.
ca con número de expediente 503/2024.
El propio Instituto ordenó a Tesorería y a la Dirección de Servicios Administrativos dar respuesta conforme a la ley. Tesorería Municipal contestó el 4 de octubre de manera contradictoria, aseverando que, “El Municipio de Torreón, Coahuila, no tiene realizado o celebrado contrato alguno con los artistas señalados, por lo que no es posible dar contestación”, a pesar de que el concierto sí se llevó a cabo y fue ampliamente difundido.
No conformes con la respuesta, Horizonte Lagunero presentó una segunda solicitud con folio 051260800068624, a la que el Municipio respondió nuevamente señalando que la información estaba disponible en su sitio web.
Sin embargo, al igual que en la primera ocasión, los enlaces proporcionados resultaron inoperantes, impidiendo el acceso a los datos solicitados.

z Según datos del
Desde que inició la temporada de dengue en mayo, la semana con el mayor número de contagios en Nuevo León ha sido la 43, del 21 al 27 de octubre, en la que se registraron mil 079. Los 10 mil 054 casos de la enfermedad acumulados durante este año en el estado representan un incremento del 12,567% en comparación con el mismo periodo del 2023, cuando se registraron 80 casos, de acuerdo con la información de Salud federal.

No dejarán deuda a próxima Administración Reajusta Saltillo gasto tras recorte de Federación
“Por instrucciones del alcalde José María Fraustro, Saltillo no va a tener deuda pública y estamos esperando que ya los recortes paren, pues la Federación ha dejado recortado el 15% de lo que le corresponde al Municipio. Estamos haciendo ajustes, una reingeniería financiera para salir muy bien en esta Administración”, dijo el tesorero municipal.
Juan Carlos Villarreal, destacó que se están terminando de pagar los proyectos del Tercer Maratón de Obras, al tiempo que ya se tiene listo el pago de los aguinaldos y las prestaciones para los trabajadores municipales, incluyendo la Policía, Bomberos y Protección Civil.
“Hemos estado en reuniones con el equipo de transición del Alcalde electo, Javier Díaz, viendo cómo dejamos la Administración, con finanzas sanas, con las calificaciones más altas de las certificadoras internacionales más importantes”, agregó.
n Arturo Estrada Alarcón
Alista SRE estrategia
AGENCIA REFORMA
Zócalo | Ciudad de México
La presidenta Claudia Sheinbaum anunció que pedirán a su futuro homólogo de Estados Unidos, Donald Trump, que, en caso de deportaciones, su Gobierno envíe a los migrantes directamente a sus países de origen.
La Mandataria federal explicó que actualmente existe un acuerdo con el presidente Joe Biden para que su Gobierno se haga responsable de repatriar a los viajeros en situación irregular, pero no a territorio mexicano, sino a los países de donde fueron expulsados.
“Hay un acuerdo actual con
la Administración del Presidente Biden en donde, para muchas de las nacionalidades, ellos directamente los envían vía aérea a sus países de origen. Ahí en donde no tienen una relación directa (EU con algunas naciones) hay un acuerdo también para que contribuyan desde México a enviar a las personas a sus países de origen”, indicó.
La titular del Ejecutivo federal confirmó que el próximo martes sostendrá una reunión con las y los gobernadores fronterizos, con la finalidad de alistar un plan, en caso de que el republicano cumpla con sus amenazas de deportar a los connacionales.

z La futura Administración Trump preparó una lista de países a los que podría enviar a los migrantes deportados si sus países de origen se rehúsan a aceptarlos.
Dejará la política Enrique Alfaro Es Máynez líder
En una elección en la que fue candidato único, Jorge Álvarez Máynez fue designado ayer por los órganos colegiados de Movimiento Ciudadano como su coordinador nacional por los próximo tres años.
En su discurso de toma de protesta en la quinta Convención Nacional Democrática del partido, Álvarez Máynez sostuvo que MC se encuentra su mejor momento, y delineó lo que será la agenda durante su administración.
Mientras tanto, en su último acto como Gobernador de Jalisco, Enrique Alfaro reiteró que se retira de la política y aseguró que se tomará un año sabático en España, mismo en el que se preparará para cumplir uno de sus sueños: ser entrenador de las Chivas. n Agencia Reforma

Llama a valorar legitimidad
AGENCIA REFORMA
Zócalo | Ciudad de México
Consejeras del Instituto Nacional Electoral defendieron ayer los 13 mil 205 millones de pesos solicitados para la elección judicial de 2025, al asegurar que garantizar un proceso electoral legítimo requiere de un presupuesto no austero. Con la ausencia de la consejera presidenta, Guadalupe Taddei, quien no llegó por haber dado positivo a Covid-19, Norma Irene de la Cruz y Rita Bell se reunieron con la Comisión de Presupuesto de la Cámara de Diputados para analizar el costo de la elección. De la Cruz cuestionó a los legisladores de Morena sobre sus exigencias de reducir a la mitad el presupuesto para los comicios, pues, dijo, está en juego la legitimidad del

la bancada panista.
Pasan de los gritos a los jaloneos en el Pleno de la Cámara alta
AGENCIA REFORMA Zócalo | Ciudad de México
El coordinador de Morena en el Senado, Adán Augusto López, buscaba pleito y encontró motivo.
Un grito aislado que desde su escaño había proferido por la mañana el senador panista
Mario Humberto Vázquez desató una bronca la noche de ayer.
“Yunes las había dado”, dijo el panista desde su escaño, en alusión al chapulineo de Mi- guel Ángel Yunes a la bancada de Morena para darles la mayoría calificada.
Yunes Márquez, que todavía como panista votó en favor de la reforma judicial desde un escaño morenista, no se encontraba en el Pleno, pero alguno de sus correligionarios le puso al tanto de lo que habían dicho sobre él.
La trifulca estalló horas después, en el Pleno, cuando un pelotón de senadores morenistas, encabezado por su jefe, Adán Augusto López, se acercó a la bancada panista.
Yunes Márquez le exigió a gritos a Vázquez que se disculpara, pero éste se rehusó.
“Llegaron al grupo y amenazaron con madrearme”, contó Vázquez.
“Aquí o donde te vea te voy a partir tu madre”, amenazó Yunes, descompuesto, rodeado por los suyos.
“Lárguense de aquí, lárguense de aquí”, gritaba Lilly

Foto: Zócalo Agencia Reforma

z Los legisladores de oposición pidieron aceptar el presupuesto que pide el Instituto.
proceso. “Nos dicen: '¿Qué le pueden bajar?'. No, Congreso de la Unión, ustedes díganos cuantos recursos consideran indispensables para que el INE esté en condiciones para organizar un proceso con los estándares de calidad que la ciudadanía mexicana está acostumbrada”, expuso la consejera.
El Covid-19 sigue cobrando vidas y durante este 2024 en el país han muerto 683 personas según el último reporte de la Secretaría de Salud federal. Recientemente en México, la Cofepris autorizó el uso y comercialización de nirmaltrevir y ritonavir, medicamento antiviral de la farmacéutica Pfizer para el tratamiento de esta enfermedad en personas con síntomas de leves a moderados. En particular este medicamento es recomendado para personas de 60 años o más, o con alguna comorbilidad. n Agencia Reforma

del
Yo asumo mi responsabilidad y sostengo lo que le dije al senador: ‘pídale una disculpa, es un asunto de caballeros’”. Humberto Vázquez Senador del PAN

Téllez, que miraba indignada los escarceos. Otro expanista, Luis Fernando Salazar, se abalanzó y tomó por la espalda a Vargas, que le alzaba la voz a López Hernández. El tabasqueño también buscó golpear a Vargas, pero al final lo contuvieron.
El senador Manuel Velasco, coordinador de la bancada del PVEM, se interpuso y alejó a Vargas, evitando que volaran los golpes.
“Manuel ayudó a que no le rompieran la madre a Enri-
que”, contó un senador que atestiguó la trifulca.
“Yo nunca había visto algo así”, dijo uno de los senadores presentes.
El presidente del Senado, Gerardo Fernández Noroña, se vio obligado a anunciar un receso y se acercó al punto de la gresca.
Cuando se reanudó la sesión, Vázquez pidió desde su escaño la palabra para denunciar que había sido sujeto de una “agresión física y verbal” a manos de Yunes Márquez y de López Hernández.
El panista comunicó al Pleno que interpondría una denuncia formal en contra de los morenistas.
“Yo asumo mi responsabilidad y sostengo lo que le dije al senador: ‘pídale una disculpa, es un asunto de caballeros’. No me voy a doblar, no le tengo miedo a nada. Que el señor vaya, me denuncie y que me digan a dónde tengo que presentarme”, desafió el tabasqueño.
Se reúne IP con Sheinbaum
AGENCIA REFORMA
Zócalo | Ciudad de México
La inseguridad en México, especialmente en Sinaloa, el cobro de piso por parte del crimen organizado, las deportaciones masivas de migrantes de Estados Unidos, la continuidad del T-MEC y los retos de crecimiento en materia económica, fueron las preocupaciones que expresaron ayer integrantes del Consejo Mexicano de Negocios a la presidenta Claudia Sheinbaum. Fue una reunión de casi tres horas, a la cual acudieron 54 de 60 integrantes del organismo que agrupa a los inversionistas más ricos del país, entre ellos el presidente del Consejo de Administración de Femsa, José Antonio Fernández; y Agustín Coppel,

z La presidenta Sheinbaum habló sobre su estrategia de seguridad con el empresariado mexicano. director de Coppel, quienes habían mantenido su distancia del Gobierno federal en la gestión del expresidente López Obrador. Las gentes están cobrando derechos de piso, eso es algo que tiene que eliminarse porque es un impuesto. La Presidenta dijo que están actuando, (pero) va a tardar tiempo”, aseguró Claudio X. González, de Kimberly Clark.
zocalo.com.mx/seccion/opinion
@LeonKrauze

Elreciente intercambio entre Donald Trump y Claudia Sheinbaum ofrece una visión reveladora de las dinámicas que definirán la relación bilateral entre Estados Unidos y México en los próximos años. Más allá de la retórica, esta interacción proporciona un esquema de la estrategia de Trump y subraya la posición precaria en la que se encuentra el Gobierno mexicano, sobre todo si Trump, como todo parece indicar, pone en práctica su agresiva y amplia agenda de campaña en función de México.
Trump ha comenzado el proceso de transición siguiendo su estrategia típica. Maestro en fabricar crisis, Trump apuesta por inventar o exagerar un problema, presentarlo como una amenaza existencial y luego “resolverlo” para reforzar su imagen. La situación en la frontera es un ejemplo claro.
Las aprehensiones de migrantes en la frontera sur de Estados Unidos están en su nivel más bajo en cuatro años. Sin embargo, Trump se ha inventado una renovada urgencia y anunció un supuesto acuerdo con Sheinbaum para abordar una crisis inexistente.
Esta dinámica se repetirá ad nauseam durante los siguientes cuatro años.
México será el villano conveniente, el chivo expiatorio perpetuo. Trump exigirá, amenazará y aplicará castigos según lo considere necesario. Cuando se hagan concesiones –y las habrá– anunciará “acuerdos” que lo pinten como el vencedor y al Gobierno mexicano como un aliado sumiso.
¿Hasta dónde y cómo estará dispuesto a llegar el Gobierno mexicano? La historia reciente no da para el optimismo. Durante el primer mandato de Trump, el presidente López Obrador cedió a las exigencias, particularmente en temas de migración. Estas políticas tuvieron consecuencias humanitarias graves. Nada indica que Trump, figura transaccional por excelencia, vaya a moderarse.
En este primer intercambio, la presidenta Sheinbaum parece operar bajo la esperanza de que Trump no procederá realmente con su agenda punitiva contra México. Es una apuesta arriesgada. Nada en la conformación del equipo, o en las declaraciones de Trump durante y después de su triunfo electoral, justifican la apuesta por la moderación.
Su equipo de inmigración apoya de manera unánime estrategias punitivas, y sus asesores comerciales ven los aranceles como herramientas esenciales para la confrontación con China, México, Vietnam y cuanto actor internacional se oponga al proteccionismo del “America First”. Un ejemplo: de acuerdo con Axios, Trump le negó el puesto de representante comercial a su antiguo asesor Robert Lighthizer porque Lighthizer “tiene demasiado miedo de pensar en grande”. Si “el personal es la política”, el equipo de Trump está diseñado para la confrontación. En México también parece haber la esperanza de llegar a acuerdos preliminares que minimicen fricciones mayores. Quizá, el Gobierno calcula conceder en algunas áreas puntuales con bajos costos políticos en México –como lo hizo con los migrantes el sexenio pasado, ante la vergonzosa indolencia de la opinión pública mexicana– para sortear confrontaciones en otras esferas de la relación bilateral. Esto también parece ingenuo, sobre todo porque este Trump no es el mismo de 2016. Tiene menos restricciones, mucho más poder y un mandato claro –al menos en su opinión– para imponer una relación punitiva y dominante con México en varias esferas. Esperar moderación de Trump es no entender su persona política. No tiene incentivos para suavizarse.

Las políticas duras de inmigración y comercio son populares en Estados Unidos: una encuesta del Pew Research Center de 2023 encontró que 54% de los estadunidenses apoya una mayor aplicación de las leyes de inmigración en la frontera sur. Trump hizo campaña desde un discurso primordialmente nativista y xenófobo. El electorado lo recompensó con la victoria. ¿Qué gana ahora siendo conciliador? Por ahora, el Gobierno mexicano haría bien en advertir un cambio que podría servirle.
A diferencia del 2016, México está bajo los reflectores. La prensa estadunidense está escrutando las respuestas y políticas de México como nunca. Los acuerdos y errores tendrán cobertura, y los pasos en falso serán costosos.
En este contexto, las conferencias matutinas, que definen la comunicación política en México, pueden ser un arma de doble filo. Ofrecen una plataforma para moldear la narrativa, pero también dejan espacio para errores e inconsistencias. Es fundamental que el Gobierno de Sheinbaum use esta plataforma de manera estratégica y prudente.
El Gobierno mexicano deberá avanzar con cautela, navegando una delgada línea entre mantener la soberanía y apaciguar las demandas de Trump desde un firme compromiso con la verdad, la dignidad, y ahora sí, la protección de los más vulnerables.


“En tiempos de Inteligencia Artificial, la tragedia del Manchester City revela que el planeta aún tiene reservas para lo inesperado”.
Conocí a un editorialista que aceptaba publicar cualquier día de la semana menos el lunes, cuando no se puede competir con los resultados del futbol. Había contraído la fiebre de quienes piensan que el destino se decide en el césped. De vez en cuando esta columna se ocupa del futbol, no en plan deportivo, sino para explorar las pasiones humanas. Jorge Valdano lo acaba de resumir en un artículo: “El futbol no se lleva bien ni consigo mismo ni con la sociedad, pero sigue siendo el primer productor mundial de conversaciones y emociones”. En tiempos de la Inteligencia Artificial vale la pena reflexionar
en una actividad impredecible que aún nos distingue de las máquinas. El artículo de Valdano abordaba el inaudito fracaso del Manchester City, comandado por el más brillante de los estrategas: Pep Guardiola. En siete partidos, esa escuadra triunfal perdió seis y empató otro que iba ganando 3-0. Millones de hinchas se sumieron en la tristeza que sólo entiende quien sabe, como Martín Kohan, que “un partido es cuestión de vida o muerte, que se puede llorar de emoción por la ventura de un penal atajado o bien llorar de bronca y desconsuelo por la desventura de un gol que no debió ser pero fue, porque en eso va la vida, materia de las preocupaciones
Capitolio GERARDO HERNÁNDEZ
gerardo.espacio4@gmail.com / X: @espacio4mx
La época de los informes de Gobierno turbulentos quedó atrás, al menos hasta que las oposiciones y otros agentes permanezcan aletargados y alineados al poder. La memoria de los altercados dentro y fuera de los recintos donde los gobernadores presentaban el estado de la Administración ante el Congreso estatal se desvanece, pero conviene recordarla para entender el momento actual. Resulta irónico que el Ejecu- tivo que más obra realizó (Óscar Flores Tapia), no obstante haber heredado una deuda por 500 millones de pesos, haya sido defenestrado poco antes de rendir su último informe y de transferir la estafeta al sucesor ya electo. Era cuando el Presidente de la República ponía y quitaba gobernadores a su arbitrio. En el caso de Flores Tapia, político de origen humilde, sin embargo, el tiempo demostró que la intriga urdida en Los Pinos, donde entonces despachaba José López Portillo, se basó en infundios. Flores Tapia murió en la medianía, no en la opulencia, característica de la generación que el expresidente Enrique Peña Nieto ostentó como el “nuevo PRI”. Gobernadores de su edad que treparon al poder para improvisar fortunas y acumular propiedades en un entorno social de penuria y privaciones cada vez mayores.
“De la forma como se llega al poder se gobierna”. La frase del político colombiano, Sergio Fajardo, define a los rapaces. Cuando el PAN era oposición y sus diputados interpelaban a voz en grito al Gobernador, y con pancartas denunciaban reformas antidemocráticas, la corrupción, la megadeuda y la impunidad, no hacían más que cumplir un deber frente a sus electores y la ciudadanía en general.
Primero, como partido minoritario; y segundo, como representantes populares. Esa
supremas”.
El calvario llevó a Pep a arañarse la cara hasta hacerse sangre y duró lo suficiente para servir de enseñanza. El desplome fue algo tan inesperado como descubrir que el agua seca las plantas. Obviamente había ciertas explicaciones más o menos racionales, comenzando por la lesión de Rodri, ganador del más reciente Balón de Oro y emblema del futbol de alto rendimiento: es el mejor del mundo pero no puede jugar porque el exceso de partidos le destruyó los ligamentos. A esta ausencia se agregan otras que han convertido al City en un sanatorio donde sobran balones. Para colmo, el prometedor canterano Palmer se fue al Chelsea, Grealish permaneció en el plantel siendo inútil y Foden, mejor jugador de la Premier en la temporada pasada, perdió la puntería. Estos razonamientos tienen que ver con la lógica, pero lo interesante es lo contrario: en una época que las computadoras entienden mejor que nosotros, el futbol sigue siendo ilógico. Pasemos a la importancia de perder partidos.
Cuando Guardiola entrenaba al Barcelona con un éxito sin precedentes aceptó protagonizar la publicidad de un banco catalán. La campaña no abordaba temas deportivos sino de filosofía de vida. La ciudad fue tapizada con aforismos del joven técnico; uno de ellos decía: “La derrota enseña más que el triunfo”. El filósofo Rafael Argullol comentó con ironía esta propagación del saber: “Guardiola es Sócrates y el banco es Platón”. Vale la pena volver a aquella frase: ¿qué enseña el fracaso? Daniel Titinger es hincha de la U de Lima. Cuando su equipo estaba al borde del descenso, el estadio se llenó más que nunca: “La cercanía del fracaso nos hizo más fuertes”, comenta Titinger, que dedicó un libro al más triste de los poetas, César Vallejo, y otro a Julio Ramón Ribeyro, cuyo diario lleva el título de La Tentación del Fracaso. A pesar de las apariencias, no estamos ante un enamorado de la derrota: sus palabras tocan un punto neurálgico del futbol. Manchester fue sede de la revolución industrial. ¿Puede esa gente laboriosa tener ataques de nervios? Claro: a la

actitud le permitió ganar las principales alcaldías, ser contrapeso en la Legislatura, incomodar al Gobierno y haber estado a un paso de la Gubernatura en 2017. Las denuncias de fraude y la convocatoria para impugnar el resultado movilizaron legiones en todo el estado. Pues había liderazgo y causas compartidas por las mayorías. Sin embargo, ese PAN dejó de existir para dar paso al conformismo, la componenda y los arreglos cupulares. Acción Nacional abdicó de las banderas que sustentaban sus luchas y lo identificaban con sectores cuyo voto permaneció fiel elección tras elección, hasta que el poder lo embriagó. Ese sufragio también lo perdió: el de la clase media emigró, en parte, al PRI; otro segmento pasó al abstencionismo y la mayoría lo tiene ahora Morena. Basta revisar la estadística electoral reciente para corroborar la caída de las siglas tradicionales y la consolidación de la ola guinda. Coahuila es hoy el único estado del país donde el PRI representa la fuerza mayoritaria. El vacío dejado por el PAN aún no ha sido ocupado. Esa situación, aunada a la atonía del empresariado, antes crítico, favorece al Gobierno y facilita el control político. En sentido contrario, y pese al predominio que ejerce en el plano federal, Morena ha sido incapaz de constituirse en factor de equilibrio y de atraer a los escépticos. La falta de liderazgos (después de Armando Guadiana no ha surgido otra figura relevante), la desconexión de la dirigencia nacional y la ausencia de una estrategia para aprovechar el impulso de la presidenta Claudia Sheinbaum, como sucedió en estados donde el PRI era, en apariencia invencible, explican el fracaso de Morena en elecciones locales. Su desempeño en el Congreso local ya lo asemeja al PAN.
hora de los goles todo inglés es un latinoamericano sin control. “Hay que fracasar mejor”, dijo Samuel Beckett para recordar que en literatura no hay obra perfecta; todo surge de la inseguridad. En cambio, el futbol es competitivo y sus protagonistas valen tanto como su último triunfo, pero también nos invita a probar, e incluso a saborear, la amarga hiel del fracaso. El verdadero aficionado ama al equipo que pierde y espera que el próximo partido le depare un milagro: “La fe en unos colores resulta idéntica al fenómeno religioso, y solo funciona correctamente cuando se conjuga con un fracaso monumental, inapelable”, escribe Enric González, hincha del Espanyol de Barcelona, que algo sabe de derrotas.
El City se había convertido en un mecanismo para ganar y su contundencia comenzaba a ser posthumana. Pero por fortuna, el planeta aún tiene reservas para lo inesperado. No me refiero a la Amazonia sino a los estadios. La tragedia del Manchester City remite a lo que el futbol debe ser: el extraño lugar donde nos gusta sufrir.

La Comisión Nacional de Salarios Mínimos (Conasami) acordó al filo de la medianoche de este martes un incremento del 12% sobre el salario mínimo para 2025. El sueldo básico, que perciben alrededor de 8.5 millones de mexicanos, pasará de 374.89 a 419.8 pesos diarios en la frontera norte y de 248.93 a 278.80 pesos diarios en el resto del país a partir del 1 de enero del próximo año. En la conferencia matutina del Palacio Nacional, el secretario del Trabajo, Marath Bolaños, celebró el apoyo de los empresarios y de sindicatos para avalar unánimemente este nuevo aumento salarial: “Con este incremento, enviamos un impulso para el resto de los salarios, es una política de ingreso salarial desde abajo”, indicó el funcionario. Se informó, que tras una negociación de poco más de una semana, empresarios, sindicatos y el Gobierno federal llegaron al consenso de elevar en un 12% el salario mínimo en México. José Luis Carazo, vocero del sector obrero de la Conasami, definió esta nueva alza en el salario mínimo como una primavera laboral. “A dos meses de haber asumido la Administración de este país, las muestras es que este panorama laboral extiende sus alas para seguir abrazando a los trabajadores”, aseveró de una manera explosiva y cariñosa, el
tal Carazo. Por otra parte, Francisco Cervantes, presidente del Consejo Coordinador Empresarial, reconoció la solidaridad empresarial para avalar esta nueva alza salarial en beneficio de casi 9 millones de trabajadores. Las autoridades mexicanas han reiterado que los aumentos al salario mínimo no tienen efectos negativos en la inflación. En un comunicado, la Comisión Nacional de los Salarios Mínimos, la Conasami, explicó que los ajustes realizados no han impactado a las empresas porque el porcentaje de la masa salarial adicional es mucho menor al crecimiento del salario mínimo en términos reales. El porcentaje de aumento salarial va en línea con la propuesta inicial de la presidenta Sheinbaum. La iniciativa fue secundada desde hace semanas por la patronal mexicana, Coparmex. Los salarios mínimos profesionales, donde se encuentran salarios de oficios como albañil, mecánico, soldador, entre otros, también se incrementaron 12% para 2025. La Zona Libre de la Frontera Norte, abarca los 43 municipios de esa zona y que están ubicados en los estados de Baja California, Sonora, Chihuahua, Coahuila, Nuevo León y Tamaulipas.
El incremento supone el primer aumento del salario básico en el sexenio de Shein-
baum y una continuación de la política salarial del sexenio anterior. Durante el Gobierno anterior, el salario mínimo alcanzó inéditos aumentos, por encima del 20 por ciento. En 2019, el salario mínimo era apenas de 88 pesos diarios. Con este incremento de casi 300 pesos diarios se avanza en el objetivo de que un trabajador que gana el mínimo pueda costear a plenitud las necesidades alimentarias básicas para una familia de cuatro integrantes, con dos adultos trabajadores y dos menores.
La Presidenta de México, Claudia Sheinbaum, ha refrendado su compromiso de que continuarán los aumentos sobre este salario para que un trabajador pueda comprar más de dos canastas básicas alimentarias… ¿alcanzará?
Entre los compromisos de Sheinbaum Pardo para el fin de su sexenio está el de fijar un salario mínimo equivalente a 2.5 canastas básicas, sin embargo, el alza al salario mínimo que se anunció este año es menor respecto a los aumentos realizados por la Administración de Andrés Manuel López Obrador. Como referencia, en 2024 el incremento fue del 20 por ciento.
Así, veremos si esta algarabía de Carazo, es la alegría de un trabajador.
Buen fin de semana, la frase: “El tiempo es el que demuestra quién vale”.
¡Ánimo!

Esquina del Águila RICARDO TORRES gpcjudicial@hotmail.com / @Ricardo Torres_1

‘Más si osare un bienintencionado’
Bastante curiosa resulta la declaración de la presidenta Claudia Sheinbaum cuando, desesperada, intentó contestar, desdeñar y tranquilizar a la vez, a los mexicanos, ante la pregunta de una reportera, respecto a la posibilidad de que Estados Unidos invada México: “No va a haber una invasión, no es un escenario que tengamos en mente. Y de todas maneras tenemos nuestro Himno Nacional”, señaló. Y es que, aunque usted no lo crea, en días pasados, la revista Rolling Stone filtró la posibilidad de que Estados Unidos invada México, ya que según dicen, un grupo de legisladores republicanos cercanos a Donald Trump, se encuentran ya, incluso analizando el costo financiero de dicho asalto a nuestra nación,
una vez que tomen las riendas de aquel país. Además de lo anterior, debemos recordar que, durante los trabajos de transición, el mismo Trump, declaró que le exigiría al Gobierno mexicano detener el flujo de fentanilo a Estados Unidos en sólo unos meses o, de lo contrario, nos enviaría al Ejército de ese país, para que, mediante operaciones encubiertas limitadas y ataques con drones o aviones, destruyeran todos los laboratorios y la infraestructura de los cárteles mexicanos, lo que a la fecha sigue reafirmando.
Además, durante su campaña, Trump declaró la guerra a los cárteles y prometió acabar con ellos cuando dijo: “Cuando regrese a la Casa Blanca, los capos de la droga y los traficantes crueles nunca volverán a dormir tranquilos”, y para ello

¡Son tres periodistas muertos con Claudia!
Como todos saben, un sexenio tiene 72 meses. Y, como seguramente también recuerdan, en el sexenio de López Obrador fueron asesinados nada menos que 81 periodistas. Es decir, que en la gestión de AMLO resultaron masacrados, a tiros, poco más de un periodista mexicano por mes. Claro, crímenes que nunca han sido y nunca serán investigados ya que, en los gobiernos populistas de Morena, “el mejor periodista es el periodista muerto”, como dicen los propios “morenistas”. ¿Pero qué creen?
Sí, resulta que en la aún breve gestión de la espuria Claudia Sheinbaum –Gobierno de apenas 65 días– se han cometido cuatro atentados contra periodistas, de los cuales tres resultaron fatales. Sí, según la estadística, el de “la señora Presidenta” ya es un Gobierno doblemente peligroso para el ejercicio del periodismo.
Lo peor, sin embargo, es que para la llamada “prensa nacional”, poco o nada importa la vida de los periodistas mexicanos que han sido asesinados en los últimos dos meses; curiosamente los primeros dos meses de la gestión de la espuria Claudia Sheinbaum. Y tal desdén informativo no tiene otra explicación que la complicidad o sumisión de la prensa, la radio, la televisión y las plataformas digitales. Y es que, por ejemplo, apenas el miércoles 3 de diciembre, en la capital de Nuevo León –en el límite de Monterrey con el municipio de San Pedro Garza García– manos criminales asesinaron al periodista de origen argentino, Adriano Bachega Olvera, editor en jefe del Diario Digital Online, cuando viajaba a bordo de su vehículo sobre una de las más concurridas avenidas de esa capital. Según la información oficial, dos vehículos en los que viajaban sujetos armados cerraron el paso al auto del periodista y dispararon en su contra, lo que provocó que Adriano perdiera la vida de forma instantánea, en el lugar. Lo ridículo del tema es que el crimen se cometió a metros del C-5 de la Policía de Monterrey pero aun así, ninguna autoridad logró detener a los presuntos responsables del crimen. Con un idéntico “modus operandi”, el domingo 1 de diciembre, en el municipio de Montemorelos, Nuevo León –la llamada región citrícola del estado– sujetos armados balearon a la pe -
propuso en su plataforma de campaña un plan en torno a siete grandes acciones, entre las cuales prometió desplegar todos los activos militares necesarios, incluida la Marina, contra los cárteles mexicanos y designarlos como organizaciones terroristas extranjeras, lo que ha sido la excusa perfecta para que ese país se permita invadir a otras naciones. Por último, debo mencionar también que, el exsecretario de Defensa Mark Esper, reveló en su libro A Sacred Oath, que Trump le había pedido en 2020 que lanzara misiles contra México para destruir los laboratorios de droga, asegurando que este, literalmente le dijo: “podríamos simplemente disparar algunos misiles Patriot y destruir los laboratorios, en silencio. Nadie sabría que fuimos nosotros”. Así pues, con todos estos antecedentes las posibilidades de que Trump intente realmente hacerlo, cada vez lucen menos descabelladas. Con esa curiosa declaración por parte de nuestra Presidenta, nos deja ver que has-
riodista Victoria Monserrat García.
De acuerdo con la información, García Álvarez viajaba a bordo de su camioneta sobre el bulevar Capitán Alonso de León, rumbo a su centro de trabajo –tras realizar la cobertura del encendido del árbol de Navidad en la Plaza Principal de Montemorelos– cuando dos vehículos la interceptaron y, de uno de ellos le dispararon en repetidas ocasiones.
A pesar de la agresión –y de que la alcanzó una bala en un brazo– la periodista continuó manejando hasta llegar al destacamento de la Policía Ministerial local, donde recibió ayuda.
Pero hay más: en Colima, la tarde del miércoles 30 de octubre, manos criminales asesinaron a balazos a la periodista de espectáculos Patricia Bunbury, quien se convirtió en la segunda víctima perteneciente al gremio periodístico, en el sexenio de la presidenta Sheinbaum Pardo. El informe oficial señala que la periodista se encontraba en un local de comida, ubicado en la calle Gabino Barrera 461, en la colonia La Atrevida, cuando llegó un sujeto armado y le disparó a quemarropa.
Tampoco es todo. Resulta que la noche del martes 3 de diciembre, sicarios no identificados asesinaron a balazos al periodista Mauricio Solís, en Uruapan, Michoacán. El asesinato ocurrió minutos después de que el periodista había entrevistado, en vivo, al Alcalde de Uruapan, Carlos Manzo.
Mauricio Solís era un joven periodista, director del portal Minuto x Minuto, además de que era colaborador de distintos medios críticos sobre la situación de violencia que se vive en el estado de Michoacán. En este caso tampoco nadie investigó nada. Y por eso las preguntas.
¿Escucharon en alguna de las “mañaneras” de “la señora Presidenta” una alusión a esos crímenes? ¿A quién le importa que siguen impunes los “mataperiodistas”? ¿Hasta cuándo el ejercicio del periodismo en México será la profesión más peligrosa del mundo?
En efecto, si sigue la tendencia como hasta ahora, el de Claudia Sheinbaum será no sólo el peor Gobierno de la historia mexicana, sino que el mundo dará cuenta de que México es campeón del riesgo para el ejercicio del periodismo.
Ola criminal que no se cometen ni las guerras más violentas. Por eso volvemos a preguntar: ¿hasta cuándo? Al tiempo.
ta hoy, con poca seriedad se está tomando las afirmaciones del próximo Presidente de los Estado Unidos, ya que, en días pasados había calificado los reportes al respecto como “toda una película” haciendo hincapié en que México iba a defender siempre su soberanía; sin embargo, esta vez no sólo insistió en que tendrá una buena relación con el próximo Presidente, sino que también aludió al Himno Nacional, haciendo la faramalla de que, de darse esa posibilidad, los mexicanos le haremos frente. En resumen, quizá el mejor de los escenarios sea que la Presidenta desconozca hasta hoy las ganas que tiene Trump de meter en cintura a los cárteles mexicanos, y por tal se atreve a referirse con tanta ligereza a nuestro Himno Nacional Mexicano, ya que el peor pudiera ser que, esté decidida a que seamos los mismos ciudadanos quienes terminemos defendiendo la soberanía de los cárteles mexicanos ante la inminente intervención estadunidense.

Registran casos entre menores de edad en cuatro hospitales
AGENCIA REFORMA
Zócalo | Ciudad de México
La Secretaría de Salud (SSa) reportó la muerte de 13 menores de edad por el brote de la bacteria Klebsiella oxytoca en hospitales públicos y una clínica privada del Estado de México.
La institución federal explicó que el brote se registró desde noviembre en tres hospitales públicos y la clínica privada en pacientes pediátricos, que van desde los 0 hasta los 14 años.
“Hasta el momento de 20 casos identificados, en 15 de ellos se identificó el agente Klebsiella oxytoca MDR (casos confirmados), cuatro continúan como probables y uno descartado”, dijo la SSA.
“De los 20 casos, se registraron 13 defunciones de pacientes que poseían comorbilidades, por lo que se encuentran en proceso de dictaminación
AGENCIA REFORMA Zócalo | Ciudad de México
La Suprema Corte de Justicia de la Nación (SCKN) rechazó atraer la revisión de una sentencia que declaró ilegal el proceso de creación de los libros de texto que el Gobierno empezó a utilizar en el ciclo escolar 2023-2024. Por tres votos contra uno, la Segunda Sala de la SCJN rechazó ejercer su facultad de atracción para revisar el amparo concedido por la jueza federal Yadira Medina a la Unión Nacional de Padres de Familia (UNPF), en agosto de 2023. La ministra Yasmín Esquivel había propuesto atraer el caso, por considerar que es de relevancia jurídica excepcional, pero los demás integrantes de la Sala no estuvieron de acuerdo, por lo que ahora, el recurso de revisión de la Secretaría de Educación Pública (SEP) contra la sentencia de primera instancia será
casos identificados, de los cuales 15 fueron confirmados por la bacteria
7
niños permanecen hospitalizados y bajo observación
para determinar si la causa de muerte está asociada a la ITS por Klebsiella oxytoca MDR. “Asimismo, siete pacientes se encuentran hospitalizados y reciben atención médica continua y oportuna por parte de los servicios de salud del Estado de México”. El 3 de diciembre, el Gobierno federal emitió una alerta epidemiológica por los contagios en esa entidad, los cuales son por infección del torrente sanguíneo, relacionado a posible contaminación de nutrición parenteral.

z
resuelto por el Décimo Tribunal Colegiado en Materia Administrativa.
Está por verse si este tribunal entrará al fondo del asunto, o si desechará el amparo, por considerar que los libros del año pasado ya fueron rebasados por los del ciclo 20242025. El caso es relevante porque la sentencia de la jueza fija criterios sobre las obligaciones legales de las autoridades educativas federales en el proceso de creación de estos libros, que se basan en el Plan de Estudios La Nueva Escuela Mexicana, criticado por su contenido ideologizado y favorable al actual Gobierno.
Atienden emergencia en Cocula Fallecen 3 por inhalar gases tóxicos en mina
Dos trabajadores y un contratista de la empresa minera Media Luna, que opera en el municipio de Cocula, al norte de Guerrero, murieron ayer por inhalar gases tóxicos.
La empresa canadiense Torex Gold Resources informó que las víctimas tuvieron contacto con monóxido de carbono durante el turno matutino de la mina subterránea “El Limón Guajes” (ELG Underground), ubicada en la comunidad de Nuevo Balsas. De acuerdo al reporte de la empresa, un cuarto empleado de la mina que también estaba en el área se intoxicó y actualmente se encuentra hospitalizado. n Agencia Reforma


Foto: Zócalo Agencia Reforma
z Los cuerpos estaban vestidos con ropa interior y descalzos, uno llevaba sudadera negra y el otro playera azul marino.
Zócalo | Monterrey, NL.
Los cuerpos de dos hombres
ejecutados fueron hallados en la parte baja de un puente del Anillo Periférico, en Cadereyta, Nuevo León.
A las 8:30 horas se reportó la movilización de ministeriales y soldados en la avenida Roble y la parte baja del paso a nivel, a la altura del fraccionamiento Valle del Roble.
En la zona, autoridades encontraron a 200 metros al oriente y pegado a la pared norte del puente, los cuerpos de dos hombres no identificados.
Ambos estaban vestidos con ropa interior y descalzos, uno llevaba sudadera negra y el otro playera azul marino.
Uno de los cadáveres tenía todas las piernas tatuadas.
Peritos y detectives de la Fiscalía General de Justicia recababan indicios e información para establecer si en el área donde los localizaron también los asesinaron.
En tanto personal del Ejército resguarda el perímetro para brindar seguridad.

Aseguran armas largas, cartuchos y vehículos abandonados en la zona
AGENCIA REFORMA
Zócalo | Madera, Chih.
Un comando que se desplazaba en al menos 30 vehículos incendió 13 viviendas en la comunidad La Norteña, municipio de Madera, Chihuahua.
La Fiscalía de Distrito Zona Occidente informó que inició una carpeta de investigación por el hecho violento ocurrido alrededor de las 3:00 horas de ayer.
La dependencia precisó que en total 15 viviendas resultaron dañadas en la localidad, 13 siniestradas y dos por destrozos en los accesos y en su menaje.
El reporte policial señala también que tras la inspección detallada en cada uno de los inmuebles no se localizaron personas sin vida o lesionadas, derivado de los incendios, estableció la Fiscalía. Durante los recorridos por la zona también se localizó un arma larga calibre .223, una pechera portacargadores

y 5 cargadores de arma larga calibre .223, con un total de 97 cartuchos útiles, los cuales fueron asegurados.
También se encontraron cuatro vehículos quemados: dos pick up, un sedán y una motocicleta.
En un recorrido por la brecha de La Norteña a El Arco se localizaron otros dos vehículos abandonados, uno con impactos de arma de fuego y otro incinerado.
“Las entrevistas realizadas por agentes investigadores a
lugareños, coinciden en señalar que aproximadamente a las 3:00 horas escucharon detonaciones y observaron a personas incendiado domicilios”, detalló la Fiscalía.
“Dieron a conocer que los sujetos llegaron a bordo de aproximadamente 30 vehículos y se hallaban fuertemente armados, desconociendo de quienes se trataba”.
Descuartizan a mujer El cuerpo descuartizado de una mujer fue localizado las
primeras horas de ayer en Ciudad Juárez. El hecho se registró en el cruce de las calles Jaime Nunó y Vicente Suárez en la colonia Zaragoza. Al lado de los restos de la víctima, quien no ha sido identificada, se dejó un mensaje de advertencia contra vendedores de cristal en colonias de la zona donde se les avisaba que llegó “La Barredora” a quienes se dedicaban a consumir y vender esas sustancias.

La Laguna, Centro, Carbonífera y Norte
Reitera Manolo
Jiménez que ante aumento en flujo migratorio, el estado se preparó para atender cualquier contingencia
JESÚS CASTRO
Zócalo | Saltillo
Coahuila está listo para recibir las posibles caravanas migrantes que vienen del sur del país y a los paisanos que durante la temporada decembrina regresan de Estados Unidos a México, dio a conocer el gobernador Manolo Jiménez Salinas. Ante el posible aumento en el flujo de migrantes, previo a la toma de posesión de Donald Trump como presidente de Estados Unidos, pero, además, porque también en este mes aumentan su paso por Coahuila, el Mandatario estatal dijo que están preparados para cualquier escenario. “Tenemos el tema de migración, hay que irlos monitoreando. (…) Lo más seguro es que se vayan dividiendo, pero hay que estar preparados en el tema migratorio”, insistió y manifestó que está en constante comunicación con el Gobierno de Texas y de Estados Unidos, sobre quienes dice, saben que Coahuila hace un esfuerzo extraordina-

Fotos: Zócalo Archivo
z El Gobernador reiteró que los operativos para frenar caravanas de indocumentados a la frontera con Estados Unidos y el operativo Paisano serán reforzados.
Hay dos caravanas y ya con la experiencia que se tiene, con los operativos que existen, (…) tuvimos acuerdos interesantes para prever posibles escenarios”.
Manolo Jiménez Salinas Gobernador
rio en materia de seguridad y migración, para evitar el cierre de fronteras. Asimismo, el Gobernador refirió que, en esta temporada de fiestas decembrinas e inicio de año, también están en es-


pera de la llegada de paisanos que eligen entrar a México por Coahuila, por tener las carreteras más seguras del país.
“Vienen nuestros paisanos, se acordó que estemos bien

Elementos del Ejército Mexicano lograron ayer el decomiso de más de 100 kilos de pirotecnia y detuvieron a un hombre que pretendía ingresar de contrabando el producto a Piedras Negras, procedente del sur del país. La detención y la incautación se realizó en el punto de inspección ubicado en Allende en el kilómetro 53 de la carretera federal 57. n Armando Valdés
Alista Sheinbaum reunión con estados fronterizos
La presidenta Claudia Sheinbaum anunció una reunión con los gobernadores de estados fronterizos del norte –Baja California, Sonora, Chihuahua, Coahuila, Nuevo León y Tamaulipas– para afinar el plan contra deportaciones masivas migrantes ante el amago del Presidente electo estadunidense, Donald Trump, a la par de que reiteró que pedirá al país vecino que los deportados sean enviados a sus países de origen.
Cuidarán a paisanos con operativo
n El Gobernador reiteró que además de reforzar los operativos para frenar la inmigración ilegal a Estados Unidos por Coahuila, la entidad redoblará esfuerzos para vigilar y proteger a los paisanos que regresan a México estas vacaciones y eligen las carreteras y la seguridad que destacan a la entidad para llegar a sus destinos al interior del país.
coordinados en los operativos que hacemos para que no haya abusos contra quienes eligen Coahuila para pasar por aquí rumbo a su destino”, declaró el Gobernador.
Con información de: Agencia Reforma

z La droga fue asegurada tras haber sido localizada en un predio en el
LUIS DURÓN Zócalo | Saltillo
Elementos de la Policía Estatal lograron ayer el aseguramiento histórico de 100 kilos de mariguana, en un predio ubicado en el ejido Pozuelos de Abajo, en Frontera; este es el segundo decomiso importante que logran las fuerzas de seguridad estatales este año. Personal de la Policía Estatal localizó la droga en un predio ubicado en el mencionado poblado, se trataba de varios paquetes envueltos en cinta canela. En total se aseguraron 100 kilos de la droga y no hubo personas detenidas. La droga fue puesta a disposición del Ministerio Público federal, donde se llevarán a cabo las investigaciones para determinar la procedencia y el destino de la hierba.
Este es el segundo decomiso más grande de droga que se realiza en Coahuila en lo que va del año, en agosto, personal de la Policía Estatal localizó y aseguró un camión con 400 kilos de metanfetaminas.
Piden castigar a madre
ELVIA ZAMORA Zócalo | Múzquiz
Agentes de Investigación Criminal de la FGE cumplimentaron ayer la aprehensión de Job Nazario “N”, por el delito de feminicidio de su bebé María Alicia, de tan sólo 6 meses, mientras una de sus hijas exigió que también se castigue a la madre de la menor por la violencia que se vivía al interior de su hogar en Múzquiz. La audiencia inicial de vinculación inició ayer por la tarde, y el imputado podría alcanzar una pena de hasta 80 años de cárcel. Por esta razón, Roxana Gallegos, hija de Job, solicitó la intervención de las autoridades en el caso, y señala como responsable a Blanca Nohemí, madre de la bebé, pues asegura que ella es la violenta.

z Job Nazario “N” será procesado por feminicidio; su hija pide que la madre de la bebé también sea castigada por abuso.
“¿Cómo es posible que suelten a la verdadera culpable del asesinato de mi hermanita? Si pudiera ir a testificar yo y mi hermana todo lo que nos hacía a mí y a sus propios hijos. Llegó a desmayar a golpes a mi hermano de 2 años; quiso asfixiar a su bebé de 3 meses de nacida; se tiró de las escaleras embarazada por un pleito con mi papá”, recordó en redes con comentarios de amigos cercanos a la familia.


Asesinan a 14 en nueva jornada violenta; alerta desabasto en tiendas por crimen organizado
AGENCIA REFORMA
Zócalo | Culiacán, Sin.
En medio de constantes patrullajes, ajustes a la estrategia anticrimen y la presencia del secretario de Seguridad federal, Omar García Harfuch, Sinaloa sumó ayer 14 personas asesinadas.
El repunte de violencia también ocurre a dos días del aseguramiento histórico de más de una tonelada de pastillas de fentanilo en Ahome y Guasave, droga relacionada con los “Chapitos”, facción del cártel de Sinaloa que pelea el control de esa organización con los “Mayitos”.
Sinaloa reporta en los primeros cuatro días de diciembre 35 personas asesinadas, según el informe diario de seguridad.
El martes pasado fueron localizadas siete personas asesinadas en el pueblo Las Mulas, perteneciente al municipio de San Ignacio, a 183 kilómetros al sur de Culiacán.
Entre los asesinatos de ayer destacó el hallazgo de una persona envuelta en una cobija en la colonia Prados del Sur de Culiacán.
Los reportes al 911 incluyeron en la capital sinaloense una serie de balaceras en Valles del Sol, Villas Satélite, Las Quintas y la presencia de hombres armados en la colonia Aeropuerto. El Gobierno federal ha realizado ajustes en su estrategia de seguridad en Sinaloa, gobernada por el morenista Rubén Rocha, luego que las incursiones militares en la entidad no frenaron los hechos de violencia y han provocado reclamos de distintos sectores sociales y económicos de la entidad.
Desde septiembre que inició la guerra entre los “Chapitos” y los “Mayitos”, se han enviado distintos destacamentos y fuerzas especiales del Ejército.
Para noviembre, según información oficial, el estado de fuerza era de 11 mil efectivos del Ejército y Guardia Nacional, así como ocho aeronaves.
Sin embargo, la ola de violencia cobró la vida de 188 personas en octubre y 175 en noviembre, cifras mayores a los 144 de septiembre, aún en la gestión del presidente Andrés Manuel López Obrador y cuando inició la pugna entre integrantes del cártel de Sinaloa. Con la violencia desatada, Omar García Harfuch fue enviado desde el martes al estado para evaluar los operativos.
“Hay cosas que están fuera de nuestro alcance, que son los hechos ilícitos que hagan los delincuentes, lo que está a nuestro alcance es evitar que queden impunes, esa es la instrucción”, justificó ayer el secretario en

z Estar en Culiacán durante los últimos meses es sentirse encerrado y con miedo, relataron habitantes. Desde que se desató la narcoguerra en septiembre pasado, permea el miedo a salir a la calle
Hay cosas que están fuera de nuestro alcance, que son los hechos ilícitos que hagan los delincuentes, lo que está a nuestro alcance es evitar que queden impunes”.
Omar García Harfuch Secretario de Seguridad federal


Pega inseguridad a comercios

Elementos federales detuvieron a Adrián “N”, alias “El Gallero”, identificado como el cocinero que elaboraba pastillas de fentanilo en una célula del cártel de Sinaloa, encabezada por Javier Alonso Vázquez, “Tito”. Los hechos ocurrieron cuando los uniformados realizaban un recorrido sobre la carretera Los Mochis-Navojoa detectaron una camioneta, cuyo conductor, al notar la presencia de las autoridades, intentó evadirlos, por lo que le marcaron el alto. Al detener la unidad, los efectivos inspeccionaron el vehículo y localizaron en el descansabrazo una bolsa de plástico con un kilo de pastillas de fentanilo.
personas asesinadas en lo que va de diciembre
25%
cayeron las ventas de los pequeños negocios desde septiembre 35
La inseguridad y la violencia pueden generar desabasto, lo advertimos oportunamente, por lo que solicitamos con urgencia que se fortalezcan las medidas de seguridad en las carreteras”. Cuauhtémoc Rivera Presidente de Anpec
conferencia de prensa. “No es de la noche a la mañana, pero vamos a trabajar todos los días para que disminuya la violencia y no van a parar las acciones como las de ayer (decomiso de fentanilo)”.
Pidió información, no apoyo: SSP El secretario de Seguridad y Pro-

La Alianza Nacional de Pequeños Comerciantes (Anpec) expresó su preocupación por los hechos de violencia en los que comerciantes de Sinaloa están sumergidos desde hace meses y que afectan sus actividades, al propiciar desabasto de mercancías y productos básicos.
En una carta dirigida a autoridades de Sinaloa, la Anpec resaltó que el miedo de transportistas y proveedores impacta en los comercios y en las familias que dependen de ellos.
“Muchos de nosotros hemos experimentado dificultades para recibir mercancías debido al temor de los transportistas y proveedores, lo que deriva en un desabasto que impacta directamente en los comercios comprometiendo la disponibilidad de productos básicos y esenciales y, por ende, en las familias que dependen de ellos”, señaló Cuauhtémoc Rivera, presidente de Anpec.
Refirió que esta temporada decembrina es fundamental para la recuperación económica de muchos pequeños negocios, pero la falta de condiciones seguras para el transporte y distribución de mercancías amenaza con limitar la capacidad para satisfacer la demanda.
“La inseguridad y la violencia pueden generar desabasto, lo advertimos oportunamente, por lo que solicitamos con urgencia que se fortalezcan las medidas de seguridad en las carreteras, centros urbanos y comunidades rurales para garantizar el libre tránsito de mercancías y la integridad de quienes participan en las cadenas de suministro”, exigió Rivera.
tección Ciudadana (SSPC) federal, Omar García Harfuch, lleva dos días de detenciones y operativos para asegurar droga en Sinaloa sin el apoyo de la Secretaría de Seguridad Pública estatal, reveló su titular Gerardo Mérida.
En conferencia de prensa, dijo que la dependencia federal sólo pidió información al Gobierno estatal, y que las reuniones de García Harfuch en la entidad desde el lunes sólo han sido con autoridades federales. “(Harfuch) Se está reuniendo
con autoridades de Sinaloa a nivel federal, tendrá que hacerlo en algún momento con las del estado, la estrategia la traen implementada desde Ciudad de México, en esta situación de inicio únicamente nos pidieron información, que ya fue proporcionada en tiempo y forma, el apoyo directo aún no lo han pedido”, expresó Mérida Sánchez. “Van en segundo día de trabajo, en su momento creo que vamos a tener que hacernos presentes por alguna situación del manejo que tengamos que
“El Gallero” está vinculado con una célula delictiva dedicada a elaborar pastillas de fentanilo en Culiacán, además de estar relacionado con el aseguramiento de más de una tonelada de fentanilo ocurrido en días pasados en el estado. n El Universal
hacer, porque esta situación, la presencia de su trabajo no va a ser de forma permanente, tienen que dejarnos una línea, una forma, el cómo se pudo hacer y el cómo se tiene que seguir haciendo. “No debemos de desesperar, estamos conscientes de lo que se está trabajando, cómo se está trabajando y cómo debemos participar, sí tenemos que participar en ese sentido”.
A nivel estatal, se reportó que Harfuch sólo se ha reunido con el Mandatario morenista, Rocha Moya.
Operativos
Durante los días de operativos federales en la entidad, se informó sobre el decomiso en Ahome (Los Mochis), al norte de Sinaloa, de 800 kilos de fentanilo, tres vehículos y precursores químicos, así como otro decomiso más en la misma ciudad de 11 bultos con aproximadamente 300 kilos de precursores químicos de fentanilo.
Desalojan a alumnos y mandan a clases virtuales
La escuela primaria Niños Héroes, ubicada en la colonia CNOP, de Culiacán está siendo usada en forma temporal como campamento militar.
A través de un comunicado que circuló entre padres de familia de dicho plantel, se les notificó que las actividades académicas seguirán en forma virtual, dado que el edificio escolar será ocupado durante todo diciembre por elementos militares.
Se intentó en repetidas ocasiones tener una respuesta oficial de las autoridades educativas pero estas guardaron silencio ante la versión de los padres de familia de dicho plantel, donde ya se observan elementos de las fuerzas federales. n Agencias
Editor: Javier Zuazua

z La aparición de Newsom en la frontera supone una forma de
dos liberales.
Impulsan asociación militar entre CalGuard y México
EFE
Zócalo | San Diego, Cal.
El Gobernador de California, el demócrata Gavin Newsom, visitó ayer la frontera con México para anunciar el refuerzo de la seguridad de la región con el que pretende detener el flujo de fentanilo hacia Estados Unidos y el de las ganancias y armas hacia México.
En una conferencia cerca del muro fronterizo, Newsom explicó que el estado ha “intensificado” la iniciativa que involucra a la Guardia Nacional de California, (CalGuard, en inglés), para luchar contra el narcotráfico.
En junio pasado California aumentó el despliegue de sus soldados destinados a interceptar fentanilo y otras drogas, al pasar de 155 miembros de CalGuard, asignados a esta labor, a casi 400. Sólo en 2023, el Grupo de Trabajo Antidrogas de la Guardia Nacional de California incautó 62 mil 224 libras de fentanilo en todo el estado, la mayoría de decomisos se realizó en los puertos de entrada.
El Gobernador además dijo que está impulsando una asociación militar entre CalGuard y México en el marco del Programa de Asociación Estatal federal ya existente.
Destacó la vasta experien-

elementos de la Guardia Nacional de California desplegados
cia y el éxito de los soldados californianos en el apoyo a las autoridades civiles en operaciones antinarcóticos, de respuesta a emergencias y de socorro en casos de desastre, como se demostró en Ucrania, durante el inicio de la invasión más reciente de Rusia en 2022.
Acelerar flujo Newsom también destacó el inicio de la construcción de un nuevo puerto de entrada en la frontera que ayudará a aliviar las demoras en los puertos y acelerará el flujo de bienes comerciales.
El demócrata pidió al Gobierno del presidente Joe Bi-

den que asegure más recursos federales para este proyecto de construcción en el este de Otay Mesa, que costará cerca de 800 millones de dólares.
“California está demostrando que podemos construir sólidas alianzas internacionales con México, nuestro principal socio comercial, para hacer crecer nuestra economía y crear empleos, al mismo tiempo que priorizamos la seguridad y el bienestar de nuestras comunidades”, indicó.
Aprovechó la oportunidad para cargar contra el presidente electo Donald Trump y advertir que la imposición de aranceles a México causaría "un gran daño" a la economía del país y de estados como California.
“No crean por un segundo que esto no los va a impactar”, dijo en un mensaje a los constituyentes.
Mueren 48 civiles más
EFE Zócalo | Los Ángeles, Cal.
Un potente terremoto de magnitud 7.0 sacudió ayer el norte de California, lo que provocó una alerta de tsunami que se extendió hasta el estado de Oregón, informó el Servicio Geológico de Estados Unidos (USGS por sus siglas en inglés), pero la cual por la noche fue desactivada.
El sismo ocurrió a las 10:44 horas a una profundidad de 10 kilómetros en el noroeste de Petrolia, una ciudad del condado de Humboldt.
A esta sacudida le siguió a los tres minutos una réplica de magnitud 5.8 a 9 kilómetros de Cobb, en el norte de California, y otras tres de 3.3; 3.7 y 4.2 respectivamente, según los datos de USGS. Las autoridades emitieron una alerta de tsunami para las zonas costeras del norte de California y el centro de Oregón. Los residentes del área de la Bahía de San Francisco recibie-

z Negocios por
ron alertas de tsumani y en su momento les fue solicitado estar atentos a posibles órdenes de evacuación. Hasta el momento no se han reportado posibles víctimas o daños.

El próximo 24 de diciembre el papa Francisco dará oficialmente inicio al Jubileo para, durante todo el año siguiente, ofrecer el perdón de los pecados a todo aquel que peregrine a Roma, mientras el Vaticano espera la llegada de al menos 30 millones de fieles a lo largo de este evento.
Por eso, las autoridades romanas se afanan ahora, in extremis, en arreglar el muchas veces maltrecho y agujereado suelo de la ciudad y de los alrededores de la Santa Sede, en un intento considerado de evitar sustos y tropezones entre los peregrinos.
Pero la pavimentación tradicional romana es, como todo en esta urbe, única e histórica, conformada por una infinidad de adoquines cúbicos de basalto extraídos de sus periferias volcánicas y que son conocidos popularmente como “sampietrinos”, ya que fueron usados por primera vez allá por el 1700 para cubrir la Plaza de San Pedro. n EFE
z El líder del PPP, Han Dong-hoon, instó a suspender “de inmediato” a Yoon de sus funciones. EFE
Siguen protestas en Corea
Zócalo |
El índice de aprobación popular para el Presidente de Corea del Sur, Yoon Suk-yeol, cayó hasta 13% tras la convulsión desatada por su declaración el martes de la ley marcial de emergencia, revocada horas después, según una encuesta de Gallup Korea. El sondeo, publicado este viernes y con participación de mil 1 personas mayores de 18 años, revela que la aceptación del líder del país es la más baja desde que este asumiera el
cargo de Presidente en 2022. Los surcoreanos valoran negativamente a Yoon en 75%, el porcentaje más alto de la historia para un Mandatario surcoreano. El 19% de los encuestados mencionó “preocupaciones económicas” y 16% se mostró “intranquilo” con la gestión de la situación derivada de la ley marcial, anunciada la noche del martes por Yoon para proteger el orden constitucional. El estado de excepción fue revocado unas seis horas después de que la Asamblea Nacional votara a favor de ello.
Zócalo | Jerusalén, Isr.
Al menos 48 palestinos murieron y otras 201 resultaron heridos por ataques israelíes en la Franja de Gaza a lo largo del último día, según el Ministerio de Sanidad del enclave, gobernado por Hamás. El número de fallecidos desde que Israel lanzó su ofensiva en Gaza en respuesta a los
ataques de los milicianos palestinos del 7 de octubre de 2023 asciende ya a 44 mil 580, de los cuales 70% son mujeres y niños, mientras que el total de heridos es 105 mil 739. Además, las autoridades recuerdan cada día que estos números excluyen los cerca de 11 mil cuerpos a los que los equipos de rescate no tienen acceso por estar atrapados entre los escombros de los edifi-
Efectúa España operativo
AGENCIAS Zócalo | Madrid, Esp.
La Policía Nacional de España detuvo a dos personas afines al Daesh (autodenominado Estado Islámico) que incitaban a la yihad en las redes sociales. El Ministerio del Interior in-

z El acceso al rescate de cuerpos en edificios se complica. cios bombardeados. Por su parte, el Gobierno estadunidense tachó ayer de “infundada” la alegación de la Amnistía Internacional de que Israel ha cometido y continúa cometiendo genocidio.
formó en su sitio web que entre los detenidos se encuentra una mujer de origen mexicano, que había sufrido una profunda radicalización que le llevó a defender los postulados más extremistas del yihadismo y a apoyar atentados. Tanto esta mujer, nacida en 1975, como el otro hom-
bre detenido en la operación de la Comisaría General de Información (CGI) de la Policía Nacional fueron puestos a disposición del Juzgado Central de Instrucción número uno y la Fiscalía de la Audiencia Nacional, donde se dictaminó prisión provisional para ambos.

Localizan huesos humanos en Fresnillo
Un cráneo y huesos de diferentes partes de un cuerpo humano fueron localizados en un predio ubicado en el entronque de la carretera estatal a Bañón, que conduce a la localidad de Chichimequillas en Fresnillo, Zacatecas. El hallazgo ocurrió al oriente de la cabecera municipal minutos antes de las 13:45 horas, mientras era sofocado un incendio de hierba seca que alcanzó a vehículos descompuestos que estaban en la misma zona.
De acuerdo con el reporte de las autoridades, una vez controladas las llamas, se observó cerca de estas unidades un cráneo y husos humanos, sin embargo, descubrieron que las osamentas tenían mucho tiempo en ese lugar.
n Agencias

Asesinan a hombre en Galerías de León
Un hombre fue asesinado a balazos en el estacionamiento de la Plaza Galerías Las Torres de Léon, Guanajuato. Dos hombres fueron detenidos en la zona norte de la ciudad y extraoficialmente se informó que serían los agresores. El ataque ocurrió alrededor de las 17:00 horas en la plaza ubicada sobre el bulevar Juan Alonso de Torres esquina con Hilario Medina. La víctima, Alejandro Rea, de 36 años, salió de su casa y se dirigió a la plaza, y mientras caminaba por el estacionamiento fue alcanzado por dos hombres que iban a bordo de una motocicleta; uno de ellos sacó un arma de fuego y disparó en varias ocasiones contra Alejandro. n Agencias

Acuchilla expareja a mujer en BCS
Una mujer en La Paz, Baja California Sur, fue atacada con un cuchillo por su expareja, quien logró lesionarle los dedos de la mano y tuvo que ser llevada para su atención de emergencia. La víctima se suma a las más de 700 mujeres que han sido lesionadas con dolo en lo que va del año, la mayor parte por hombres en BCS.
Según la víctima, Nicolasa “N”, su agresor fue Martín “N”, su expareja, quien fue a buscarla a casa de su hermana, donde ella se resguardó, luego de la separación.
Allí, el hombre acudió, le mostró un cuchillo que llevaba y la amenazó para que se fuera con él. Ella se negó y ocurrió la agresión directa contra su mano izquierda.
n El Universal
Huyen pobladores ante el temor de enfrentamientos entre 'El Machete' y 'Los Herrera'
EL UNIVERSAL
Zócalo | San Cristóbal de las Casas, Chis.
“El Machete” y “Los Herrera”, los grupos armados que se disputan el control del Ayuntamiento de Pantelhó, en la región de Los Altos de Chiapas, tienen a la población sumida en el miedo.
El martes, integrantes de “Los Herrera” quemaron viviendas en el poblado San José Tercero, bastión de las autodefensas “El Machete”, y han causado el desplazamiento de familias de la zona, denunció la Diócesis de San Cristóbal de las Casas. En respuesta, “El Machete” tomó la cabecera y el Palacio Municipal de Pantelhó ese mismo martes. Al día siguiente, hombres

z Durante la toma de la cabecera municipal de Pantelhó, gente de “El Machete” procedió a cortar las líneas eléctricas, con lo que la población quedó a oscuras y sin señal de telefonía convencional y celular.
armados de “Los Herrera” dispararon y desplazaron, de manera violenta, a pobladores de las comunidades San Francisco y El Roblar, colindantes con San José Tercero.
Durante la toma de la cabecera municipal de Pantelhó, gente de “El Machete” procedió a cortar las líneas eléctricas, con lo que la población quedó a oscuras y sin señal de
telefonía convencional y celular, lo que dificulta la comunicación con la zona. Muchos pobladores abandonaron sus hogares.
Hasta el jueves, integrantes de “El Machete” mantenían ocupada la Presidencia Municipal, mientras que “Los Herrera” se resguardaban en la cabecera local.
“El Machete” que desde el 21 de julio del 2021 mantuvo el control del Ayuntamiento, cuando irrumpieron y se llevaron a 21 hombres que aún no aparecen. “Por órdenes de las 65 comunidades de Pantelhó, hemos tomado la Presidencia”, dijo un sicario que se cubría el rostro con un lienzo al momento que los armados arribaron a la cabecera municipal.
Después, los miembros del Ejército Civil Indígena irrumpieron en la cabecera municipal, pero los miembros de “El Machete” habían huido. Una avioneta estuvo sobrevolando ayer jueves sobre Pantelhó, informaron habitantes de la región.

Deberán garantizar el pago de las liquidaciones que corresponden a los empleados afectados por la quiebra
AGENCIAS
Zócalo | Ciudad de México
Por acuerdo de la Junta de Coordinación Política (Jucopo), el pleno del Senado de la República aprobó la creación de la Comisión Ordinaria de la Guardia Nacional y una Comisión Especial para Revisar y Vigilar el Proceso de Quiebra de Altos Hornos de México.
La Comisión Especial para Revisar la Quiebra de la empresa coahuilense estará liderada por el senador Luis Fernando Salazar Fernández, de Morena.
El acuerdo establece que ambas comisiones desempeñarán sus funciones durante la presente Legislatura y, en específi-

z La Comisión Especial supervisará la venta de la empresa y sus activos, así como el cumplimiento de los pagos pendientes a acreedores.
co, la Comisión de Altos Hornos, tendrá como prioridad la defensa de los intereses de los trabajadores y extrabajadores. Una de sus principales tareas
será garantizar el pago de las liquidaciones que corresponden a los empleados afectados. Adicionalmente, la Comisión Especial supervisará la

venta de la empresa y sus activos, así como el cumplimiento de los pagos pendientes a acreedores, entre ellos Petróleos Mexicanos (Pemex), la Comisión Federal de Electricidad (CFE) y otros. La Comisión estará integrada, además de Luis Fernando Salazar, por los senadores Cuauhtémoc Ochoa, de Morena; por Geovanna Bañuelos, del PT; Lilia Margarita Valdés, de Morena; Julieta Ramírez Padilla, de Morena; Alfonso Cepeda, de Morena; Laura Itzel Castillo, de Morena; Virgilio Mendoza, del Partido Verde; Miguel Ángel Riquelme, del PRI y Luis Donaldo Colosio, de Movimiento Ciudadano.
La declaración
A principios de noviembre, una jueza federal declaró la quiebra de Altos Hornos de México (AHMSA) que, fundada en 1942, llegó a ser la mayor siderúrgica del país.
Las empresas de gas LP que cuentan con plantas e infraestructura de distribución en México solicitaron aumentar el margen comercial hasta 7.5 pesos por kilogramo.
Rocío Robles, presidenta de Amexgas, consideró que es necesario tener un margen mayor que les permita operar y también destinar recursos para invertir en el mantenimiento de la infraestructura. El margen comercial ha rondado 3.98 pesos por kilo, pero se busca que aumente de manera escalonada hasta 7.50 pesos, con el fin de garantizar la continuidad operativa. Dicha cifra ya se ha conversado con la Comisión Reguladora de Energía (CRE).
“Hubo diálogo con la CRE en donde se hicieron dos estudios, que tiene la misma Comisión, y que tienen como base cuál debiera ser el cálculo para un margen justo, y en esos términos se determinó y se acordó por la autoridad que sería de 7.50 pesos”.

z En el lugar, peluqueros y clientes –entre ellos el padre del niño que quedó atrapado en la balacera–, escaparon al momento de la ejecución.
Sigue la violencia en Sinaloa
AGENCIA REFORMA Zócalo | Ciudad de México
Los operativos federales contra la guerra por el narcotráfico en Sinaloa, y los hechos violentos, ahora apuntan a los Mochis, en el municipio de Ahome. Apenas este miércoles, un hombre fue ejecutado dentro de una barbería en el fraccionamiento Santa Teresa, sitio en el que otro sujeto resultó herido. El ataque ocurrió frente a un niño a quien, en ese momento, le cortaban el cabello. Sin tiempo para resguardarse, el menor sólo atinó a cubrir-
se la cara con la capa que le colocaron en la barbería. El ejecutado fue identificado como líder de una célula de “Los Zetas” de Sonora. En el sitio del ataque otro hombre resultó herido y el niño salió ileso. Un día antes, el martes 3 de diciembre, el Secretario de Seguridad y Protección Ciudadana (SSPC), Omar García Harfuch, reportó lo que destacó como el decomiso más grande de fentanilo en la historia, con el aseguramiento de aproximadamente mil 500 kilogramos de pastillas de dicho opioide en Guasave y Ahome.

z El accidente se registró a las 20:00 horas de este jueves.
Provoca caos vehicular
BRENDA BASALDÚA
Zócalo | Ramos Arizpe
Una camioneta se volcó después de chocar contra la base de un puente vehicular en el bulevar Miguel Ramos Arizpe, en esta ciudad, lo que ocasionó tráfico lento en la zona.
El accidente se registró a las 20;00 horas de este jueves, cuando Li Jun conducía a exceso de velocidad una Chevrolet Montana, con dirección al norte, acompañado de otra persona. A la altura del puente Ma-
nuel Acuña, el conductor se impactó contra el camellón, perdió el control de la unidad y terminó volcado en la lateral de la vialidad. Testigos alertaron a las autoridades. Elementos de Protección Civil que llegaron al lugar valoraron al conductor y a su acompañante, y los trasladaron a un hospital privado, mientras que Policía y Tránsito Municipal ordenaron remolcar la camioneta y esperar el arribo de la aseguradora para determinar responsabilidades.
Edición: Gerardo Alvarado
Coedición: Ricardo Alemán

Xolos sorprende con goleada al superlíder Cruz Azul; América hace lo propio con Toluca
AGENCIAS
Zócalo | Cd. de México
América y Cruz Azul carecen de gol en la ida de la Semifinal del Clásico Joven
AGENCIAS
Zócalo | Cd. de México
Tarde de sorpresas en la ida de los Cuartos de Final del Apertura 2024. La más llamativa se vivió, sin duda alguna, en el estadio Caliente, donde Xolos, séptimo de la tabla general, dio la campanada frente a un Cruz Azul que no esperaba el ataque de los comandados por Carlos Osorio, y aunado a la expulsión de Jorge Sánchez, los azules acabaron por caer 3-0.
América y Cruz Azul quedaron a deber en un duelo fundamental en cuanto a sus aspiraciones al título, los celestes y azulcremas carecieron de gol en la ida de la Semifinal, culminando el encuentro con un insípido 0-0 que deja el juego abierto para la vuelta.
Pero el primer resultado inesperado se dio en Ciudad de los Deportes, donde el América, que llegó como el último invitado a la Liguilla, defendió su bicampeonato al derrotar de forma sencilla 2-0 a los Diablos Rojos del Toluca, que pintaban como amplios favoritos.

z Comodines y enfrente tiene a unos Gigantes a modo.
Las Águilas en esta Liguilla no han sido el equipo que solían ser desde que llegó André Jardine al banquillo, ante Toluca les funcionó esperar al rival y atacarlo en contragolpes; con Cruz Azul por ahora no funcionó.
¿Y el superlíder?
Con el empate, el América, necesitado de un gol para evitar el pase de Cruz Azul a la Final debido a la ventaja por posición en la tabla, ambas escuadras se volverán a ver las caras el próximo domingo 8 de diciembre a las 19:00 horas en Ciudad de los Deportes. Atacan primero Los de Martín Anselmi fueron muy superiores, tuvieron la pelota y en más de una ocasión inquietaron el mar- co de Luis Ángel Malagón, quien una vez más demostró que está convertido en el mejor portero mexicano de la actualidad.
Los Xolos de Tijuana tuvieron un inicio soñado en la Liguilla del Apertura 2024 contra Cruz Azul, luego de que se pusieran en ventaja 3-0, durante el partido de ida de Cuartos de Final celebrado en el estadio Caliente. El equipo de Juan Carlos Osorio resolvió el partido en 45 minutos gracias al desconcierto celeste de Jorge Sánchez, y a las anotaciones de José Zúñiga, Efraín Álvarez y Emanuel Reynoso.
Para sorpresa de muchos, los de la frontera se fueron adelante, ya que llegó el primer gol del colombiano José Zúñiga apenas al minuto 11, pues “La Pantera” venció a Kevin Mier después de un error de Willer Ditta.
La Máquina fue el único que intentó, incluso en el primer tiempo; a los de Coapa les costó salir de su terreno de juego, perdían la pelota muy fácil y eso hizo que los celestes probaran de diferentes formas a Malagón.


Liga MX Semifinal / Ida


El Día de Acción de Gracias nos ofrecerá una triple jornada de enfrentamientos de la NFL, incluidos un par de enfrentamientos divisionales y un choque entre conferencias con importantes implicaciones para los Playoffs. Los Vaqueros, aunque no lo parezca, siguen con vida en esta temporada. Tras haber derrotado a Washington el pasado domingo, el equipo sin Dak Prescott y otros All-Pro buscarán sumar otro triunfo en busca del último boleto de Comodines.
En un encuentro lleno de tiros de esquina, y con algunas llegadas sin éxito, tanto América como Cruz Azul llegaron al medio tiempo sin hacerse daño.
La segunda mitad
En el segundo tiempo la historia fue la misma, sólo que por unos momentos América intentó un poco más, y un tiro de Alan Cervantes que casi se mete en el ángulo fue sacado de manera sublime por Kevin Mier.
Esa fue la única jugada en la que América mostró ham-
Minutos después comenzó el terror para los celestes, Efraín Álvarez clavó el segundo para la jauría, y es que al 18’, Gonzalo Piovi, dejó ir el esférico para aumentar la ventaja para el equipo local. Jorge Sánchez fue expulsado ante el Xolaje al 34’, el silbante marcó roja directa para el jugador mexicano tras un pisotón sobre “La Pantera” Zúñiga. La Máquina se quedó con 10 hombres, lo que fue un balde de agua fría para el conjunto celeste. Y antes de finalizar el primer tiempo, apareció “Bebelo” Reynoso, el jugador de Xolos hizo el tercero quitándose a dos defensores para vencer el arco de Kevin Mier y finiquitar la goleada de 3-0. Con este marcador, los diri-
Los alejan de Octavos
AGENCIAS
AGENCIAS
Zócalo | Cd. de México
Zócalo | Cd. de México
Al Real Madrid no le quedó ni suerte, ni épica, ni sobre todo futbol para competirle al mejor equipo de Europa, el Liverpool. La derrota, lógica, pero no por ello menos dolorosa, deja a los blancos en el borde de un sonrojo histórico: no meterse en Octavos de Final. Con seis puntos de 15 posibles, el Real Madrid ya está inmerso en la peor fase de grupos de su historia en la UEFA Champions League. Para su fortuna, es también la
Pachuca, León y Monterrey ya conocieron su destino en el Mundial de Clubes 2025. Los equipos mexicanos tendrán una dura disputa en la fase de grupos en el verano del siguiente año en la búsqueda del primer título del nuevo formato de este torneo con 32 clubes, mismo que se celebrará en Estados Unidos. La primera edición del nuevo formato del Mundial de Clubes será en Estados Unidos. Comenzará el 15 de junio y la Final será el 13 de julio. Es decir que tendrá una duración similar a la de una Copa del Mundo de mayores.
Los mexicanos
León fue el primer equipo sorteado. En medio de la polémi-
ocasiones ha eliminado el América al Toluca cuando la serie cierra en el Nemesio Díez, ¿será esta la primera?
0-0 VS AMÉRICA - CRUZ AZUL
gidos de Martín Anselmi buscarán la remontada en el estadio Ciudad de los Deportes este sábado en el partido de vuelta, donde necesitan al menos tres goles, de no ser así se despedirán del torneo.
Defienden el bi Cuando el América salió a la cancha del estadio de la Ciudad de los Deportes con su cuestionada línea de cinco zagueros, el descontento entre la afición azulcrema era evidente, sin embargo, las cosas se le dieron al América, que, sin Henry Martín ni Diego Valdés, pegaron primero y se llevaron 2-0 el capítulo inicial contra Toluca. Los sublíderes en la fase regular mostraron poca ambición ante unos azulcremas que lucían defensivos en su hogar. Con Zendejas, Fidalgo, Rodríguez y Aguirre en el ataque, los de Coapa dañaron considerablemente a unos irreconocibles escarlatas. Y fue precisamente el atacante uruguayo, el “Búfalo”, quien firmó su doblete (67’ y
bre de ganar este partido, porque después los cementeros volvieron a ser dueños del balón, y si bien ya no pusieron en aprietos a Malagón, controlaron por completo el juego. Sobre el final del encuentro Jardine le dio minutos a Víctor Dávila, quien no jugaba desde octubre por una lesión en el tobillo, y demostró que es un jugador que pueda brindar una solución para el duelo del próximo domingo en esta misma Ciudad de los Deportes. Al final, las Águilas del América no quisieron arriesgar y decidieron irse con el marcador en blanco a la vuelta, resultado que favorece totalmente a Cruz Azul, que con el empate le será suficiente. El empate sin goles mete en un poco de problemas a las Águilas para la vuelta, pues deben ganar sí o sí el encuentro para poder avanzar a la Final por tercera ocasión consecutiva, cualquier otro resultado le da el boleto a La Máquina, que fue el mejor del torneo.
más extensa, por lo que tiene tres partidos por delante para aliviar la herida.
Las acciones Los Reds dominaron la primera parte con claras ocasiones de gol, pero una defensa luchadora y una primera parte brillante del arquero belga Thibaut Courtois impidieron que se adelantaran los ingleses. Con los ingleses lanzados y los españoles hundidos en defensa, Mac Allister logró adelantar a su equipo con un derechazo cruzado ajustado superando la estirada del
ca sobre la multipropiedad y si podrá jugar o no el certamen, disputará la fase de grupos en el sector D, donde competirá ante el Flamengo de Brasil, el ES Tunis de Túnez y el Chelsea. Los Esmeraldas, además, abrirán el torneo contra los Blues. Por su parte, el Monterrey fue el segundo club mexicano que sortearon en la gala. Rayados se coló al grupo E junto con River Plate de Argentina, el Urawa Red Diamonds de Japón y el Inter de Milan de Italia. Rayados hará su debut ante el conjunto italiano. Finalmente, el Pachuca también tuvo un futuro complejo debido al rival europeo
Los escenarios z Un empate le basta a Cruz Azul en la vuelta para avanzar a la Final. z América sólo tiene la opción de ganar si quiere aspirar al tricampeonato.
Han pasado 25 años z La última vez que Cruz Azul dejó fuera a América en una Liguilla fue en Semifinal de 1999; con una victoria en la vuelta se acabaría la malaria cementera.
82’) para sellar un triunfo que no es definitivo, pero sí cómodo para ir el sábado al Nemesio Díez y tratar de regresar con el boleto a las Semifinales. El América y Jardine sorprendieron en la capital y, aunque la historia todavía tiene un segundo y más complicado capítulo, la ilusión de alcanzar el tricampeonato ha cobrado fuerza, cuando el panorama parecía oscurecerse para el todavía rey de Liga MX.
Dura baja z Cruz Azul no contará con Jorge Sánchez para la vuelta, pues fue expulsado al minuto 34.
minutos tiene América sin recibir gol en Liguilla (ida y vuelta contra Toluca e ida contra Cruz Azul)
73%
del control del balón en el estadio Caliente se fue para el lado de Xolos de Tijuana
Más que difíciles z Cruz Azul sólo tiene dos derrotas en los últimos 13 partidos, incluyendo la Liguilla; una derrota en la vuelta los dejaría fuera de la Liguilla.
¿Cuáles son los dos equipos que llegarán a la Final de la liga MX?
¿Cuáles son los dos equipos que llegarán a la Final de la Liga MX?



belga al 51’. la Premier League habían ases tado un duro golpe, los ma dridistas se repusieron y pro vocaron un penal tras derribar a Lucas Vázquez en el 58’. Pero, z Real Madrid.
Los encontronazos Los Leones (10-1), considerado por muchos el mejor equipo de la NFL esta temporada, reciben a unos Osos de Chicago (4-7) que no terminan por concretar su reconstrucción, pero iniciarán la jornada de Thanksgiving. Si bien es un duelo divisional, se trata de dos equipos que marchan en rumbos opuestos.
La jornada cerrará con los Empacadores de Green Bay recibiendo en casa a Delfines de Miami. Uno de los duelos a seguir será el que sostenga el corredor de Green Bay, Josh Jacobs, contra la defensa terrestre de Delfines. Jacobs corrió para tres touchdowns el domingo, mientras que los Delfines permiten la amplia cantidad de 106.9 yardas por tierra por juego.
En un encuentro sumamente peleado en el Ford Field, Leones de Detroit sacó una importante victoria de 34-31 frente a sus rivales de la NFC Norte, Empacadores de Green Bay, que significó su pase a la Postemporada por segunda temporada consecutiva. El ingreso a Playoffs no fue lo mejor, si no que los Leones ligan 11 victorias de forma consecutiva, superando el récord de la franquicia con más victorias seguidas, que era de 10, pues ayer impusieron nueva marca y aún pueden ir por más. El encuentro permanecía empatado cuando Jack Bates convirtió el gol de campo del triunfo para unos Leones que son, sin duda alguna, un fuerte aspirante a pelear por el Super Bowl, pues 11 victorias consecutivas en su espalda lo avalan.
La numeralia Jared Goff comandó a Detroit a una victoria sumamente significativa con 32 pases completos de 41 intentos para 283 yardas, dando como resultado 3 anotaciones y una intercepción. Por el lado de Empacadores, Jordan Love cerró con 12 de 20 para 206 yardas.

tarazo del neerlandés Gakpo dentro del área pequeña tras
junto de LaLiga se quedó conminatorios de playoffs (lugar 24) para los Octavos de Final del nuevo formato del torneo más importante a nivel de

León, Rayados y Pachuca ya conocen los clubes con los que compartirán grupo.
al que se medirá, ya que está en el grupo H con el Real Madrid de España, el Al Hilal de Arabia Saudita, así como el RB
Salzburgo de Austria. Los Tuzos jugarán su primer juego contra el RB Salzburg. Estos tres equipos mexica-
Jesús Martínez, dueño de Grupo Pachuca, anuncia que pretende acabar con multipropiedad
AGENCIAS
Zócalo | Cd. de México
Jesús Martínez, propietario de Grupo Pachuca, al que pertenecen León y Pachuca, pide que la FIFA respete el derecho de jugar el Mundial de Clubes, “ganado en cancha”, y anunció que el plan es vender al León, para acabar con la multipropiedad.
“Se los dijimos (a FIFA), en las últimas juntas de dueños de la Liga MX, hemos declarado que el León es el equipo del que vamos a tener que vender el control”, reconoció Jesús Martínez Patiño.
Pide que los dejen Pachuca y León están bajo investigación debido a que el Mundial de Clubes no permite la “multipropiedad” en sus regulaciones, por lo que ambos clubes deben compro-

z El León sería el club sacrificado por el Grupo Pachuca para acabar con la multipropiedad.
A venderlos
z La Liga MX aseguró que la multipropiedad tiene que desaparecer a más tardar en el año 2026.
bar que operan como entidades distintas, sin influencia de uno sobre otro. Ante eso, Jesús Martínez pide que se respete lo ganado en la cancha.
“Creo que ellos también están muy conscientes de eso, porque imagínate su afición,
los jugadores que lo ganaron dentro, el cuerpo técnico, todo eso, yo creo que eso, el fair play es muy importante”, comentó el titular de Grupo Pachuca. Pachuca ganó el derecho de ir al Mundial de Clubes gracias a que fue campeón de la Concacaf Champions Cup en el 2024, mientras que el León hizo lo mismo en el 2023. En ese momento se desconocía que la multipropiedad estaría prohibida en la competencia que se disputará en Estados Unidos.


Santos prepara el 2025
EL UNIVERSAL Zócalo | Cd. de México
De cara al Torneo Clausura 2025, Santos Laguna presentó al mexicano Javier Abella y al colombiano Cristian Dájome como refuerzos para los Guerreros. Esta será la segunda etapa de Abellla en el club de la Comarca Lagunera, pues sus inicios fueron en este equipo en 2009, donde se integró a la Cantera Guerrera con la categoría Sub-17. Abella fue clave en la consecución de los títulos del Clausura 2015 y Clausura 2018 en Primera División, así como de la Copa MX Apertura 2014
y el Campeón de Campeones en 2015.
El colombiano Por su parte Cristian Dájome, extremo colombiano, inició en su país natal con Bogotá FC y abarcó diferentes equipos, destacó con Atlético Nacional, donde fue multicampeón, logrando los títulos de la Copa Libertadores y Copa Colombia 2016, así como el Torneo Apertura y la Recopa Sudamericana en 2017.
En su nueva etapa con los Guerreros, José Javier Abella portará el número 13. Por su parte, el colombiano Cristian Dájome usará el 7 en la espalda.

Azul va por Chiquete
EL UNIVERSAL
Zócalo | Cd. de México
Chivas del Guadalajara podría desprenderse de uno de sus mejores hombres, mientras que Cruz Azul, en plena ronda de Semifinales, ya piensa en reforzarse de cara al próximo Torneo Clausura 2025. El zaguero Jesús Orozco Chiquete podría convertirse en nuevo jugador de La Máquina, y reportes señalan que las negociaciones entre celestes y rojiblancos van por buen puerto. Así lo indica información de TUDN.
Es de los llamativos Orozco Chiquete, de 22 años, se ha convertido en uno de los defensores más llamativos del futbol mexicano. Con grandes actuaciones se ha consolidado en el Guadalajara y también ya ha sido llamado por Javier Aguirre en el Tricolor. Debutó el 30 de julio de 2021, en un duelo contra el Puebla, y desde entonces ha crecido en el zaga del Rebaño; ya suma 97 partidos en Primera División. En esa posición, Cruz Azul cuenta con Gonzalo Piovi, Camilo Cándido y Rodolfo Rotondi.

Suman a Jheniffer Cordinali
AGENCIAS Zócalo | Cd. de México
Tigres Femenil tiene a su primera incorporación de cara al Clausura 2025, luego de que firmaron antes de terminar el Apertura 2024 a la delantera
Jheniffer Cordinali, quien llega tras una etapa en el Corinthians del Brasileirao Femenino. La jugadora de 23 años se desempeña como delantera, y arrancó su carrera como profesional con el Internacional de Porto Alegre, donde jugó de 2019 a 2020 y registró 18 juegos disputados y 12 goles.
Su palmarés Se unió al Corinthians en 2021, donde tuvo 53 encuentros y 27 goles, además de tener un paso exitoso al conquistar tres campeonatos del Brasileirao Femenino en 2021, 2022 y 2023, así como dos copas Libertadores Femenina, en 2021 y 2023. Jheniffer también es seleccionada brasileña y es medallista olímpica, luego de que ganó la plata en los Juegos Olímpicos de París 2024 el verano pasado, donde jugaron la Final ante Estados Unidos.

z Panteras Saltillo le puso la cereza al pastel alzando el título en la Liga
Dominan en San Pedro
GERARDO ALVARADO
Zócalo | Saltillo
El equipo de Formación y Futbol Panteras Saltillo se coronó campeón en la Liga San Pedro Fut-7, luego de que, durante toda la temporada brillara y ahora sólo le pusiera la cereza al pastel.
Fue la categoría 2016 la que se lució dentro de este certamen en la Sultana del Norte, en donde sorteó buenos rivales, pero poco a poco los fue eliminando hasta quedarse con el cetro de este año.
Los mejores
La Final la disputó en contra de Chivas Cumbres, con quienes se dio un buen agarrón en la cancha, pero logró sacar adelante el marcador, quedando 1-0, y de esta manera salir con el título en las manos. Antes, en la Semifinal, disputó el boleto por el juego

z El patronato de la 21K Coahuila ya prepara la edición 28 del medio maratón.
partir de hoy
NAHOMI JARAMILLO
Zócalo | Saltillo
La 21K Coahuila adelantó la Navidad para los corredores, anunciando la apertura de inscripciones en línea para la justa atlética del 2025 a partir de hoy.
Después de haber celebrado hace unos meses la edición 27 de la justa más grande de México, ayer por la tarde, el patronato de la carrera reapareció en las redes sociales con dicha noticia.
Revuelo runner
La publicación se compartió en breve entre las comunidades runners, quienes poco a poco se hicieron presentes, confirmando su asistencia a la edición 28 que se celebra en el verano, en Saltillo.
Dicho proceso, se realizará a través de la liga 21kcoahuila.org, donde los atletas conocerán el costo de inscripción para la modalidad Individual y por Relevos, así como el cupo de corredores que se permitirá.
La página hasta ayer se encontraba con el promocional de la edición 2024, por lo que la comunidad deportiva hoy tiene la esperanza de conocer la nueva imagen, fecha, diseño de playera y medalla.
SERÁ DEL 17 AL 19 DE ENERO
Vivirá la localidad la primera edición de la Copa Ciclista Coahuila con presencia nacional
NAHOMI JARAMILLO
Zócalo | Saltillo
Jugadores
z Estaban Rodríguez
z Joaquín Peña
z Luis Mario Enríquez
z Abraham Molano
z Mario Coronel
z Luis Ernesto Leza
z Luis Carlos Orta
z Rodrigo Núñez
z Juan Carlos Oviedo
z Ricardo Vielma
a la corona en contra del anfitrión, Rayados, con los que quedó 5-4.
Los ganadores de este certamen son Estaban Rodríguez, Joaquín Peña, Luis Mario Enríquez, Abraham Molano, Mario Coronel, Luis Ernesto Leza, Luis Carlos Orta, Rodrigo Núñez, Juan Carlos Oviedo y Ricardo Vielma. El entrenador es Héctor Gutiérrez y el director deportivo Josué Arriaga, “Zurdo”.
La primera edición de la Copa Ciclista Coahuila inaugurará la temporada nacional de competencias 2025 de la disciplina, esperando grandes pedalistas del país. Antonio Luna, director de Vitti Logistics, en compañía de Antonio Cepeda, director del Inedec; Miguel López, de la Secretaría de Pueblos Mágicos de Coahuila; Jesús Gámez, titular de la Dirección Deportiva Municipal; Raúl Rodarte, de la OCV; Fernando Torres, de Transportes LAIN; Alay Arreaga, de la Presidencia de Arteaga, y José Cossío, dio a conocer los pormenores de este evento.
Varios confirmados
El serial se celebrará del 17 al 19 de enero dentro de la vuelta, criterio, ruta y prólogo, mismas que se vivirán dentro de las instalaciones de Vitilogistics, y en carretera rumbo a Ciénega del Toro.
En esta edición se espera recibir a 700 ciclistas locales y nacionales, teniendo confirmados a Pato Bike, Calzada Kings, Noralba, Juquili-

Los pormenores
z FECHA: 17 AL 19 DE ENERO 2025
SEDES:
z Viernes – Vuelta 1: Criterum: Vitilogistics
z Sábado – Vuelta 2:Ruta, Restaurante Herradura a Ciénega del Toro. z Domingo – Vuelta 3: Prólogo: Vitilogistics
COSTO:
z $350 Una etapa z $600 Dos etapas y prólogo z $1200 Gran Fondo Bolsa económica: 250 mil pesos
Categorías:Juvenil A, Juvenil B, Juvenil C, Libre Femenil, Elite y MTB, Novatos, Gran fondo, ambas ramas y 30-39, 40-49, 50-59, 60+ Varonil.
ta Cycling Team, Ducks, Scott y Transportes Lain de Saltillo. Además de las vueltas, el sábado se realizará el Gran Fondo, al cual invitan a ciclistas del estado y la región a convivir, disfrutar de las vistas y cumplir con un reto personal.
Los costos
El costo de inscripción es de 350 pesos por etapa, 600 por dos días y mil 200 para el gran fondo, con lo cual tendrán derecho a diferentes beneficios,
mismos que están marcados en la convocatoria.
La venta de folios en Saltillo será en la tienda Velocup, Bike Tera-ffe, IL Giro, Kapital Bikes, además de Pro Paco Serrano Bike, en Monterrey, Elite Bike y Comarca Ciclyng, en Torreón. Este proyecto pretende ser una plataforma para que los ciclistas juveniles puedan ser vistos por equipos profesionales, además de ser un escenario de preparación para competencias nacionales.
A inscribirse
z Hoy se podrán conocer




Saúl Álvarez vuelve a negarse a pelear con el mexicoamericano
AGENCIAS Zócalo | Cd. de México
David Benavidez reveló que a Saúl “Canelo” Álvarez le ofrecieron 70 millones de dólares para que peleara con él, pero afirmó que al campeón del peso Supermediano lo que le interesa más, en estos momentos, es el dinero más que los desafíos.
“Ahora lo único que quiere es ganar dinero, no le importan los desafíos, pero la razón por la que digo que tiene miedo es que le ofrecieron 70 millones de dólares para pelear conmigo, eso antes del PPV. Imagínense cuánto ganaría con el PPV”, indicó David Benavidez en entrevista.
Están muy lejos “Canelo” Álvarez había declarado que él aceptaría un posible combate ante Benavidez si es que estaba de por medio una bolsa de entre 150 y 200 millones de dólares. Ante las negativas del campeón, David Benavidez ya descartó una pelea contra el ja-
Lo que sigue z David Benavidez espera enfrentarse al ganador de Beterbiev vs Bivol; de no ser así, va por “El Zurdo” Ramírez.
70 mdd
le ofrecieron a ‘Canelo’ pero él sólo aceptará una bolsa de entre 150 y 200 millones de dólares
lisciense y atribuyó que el monarca del Consejo Mundial de Boxeo, la Organización Mundial de Boxeo y la Asociación Mundial de Boxeo, tiene miedo.
“Esta pelea no se llevará a cabo porque él no quiere pelear conmigo porque me tiene miedo. Míralo, “Canelo” está en el lugar donde está porque ha peleado con los mejores y ahora está haciendo las bolsas más grandes”, declaró. Cabe recalcar que, si no se da una pelea entre el ganador de Artur Beterbiev y Dmitry Bivol II, David Benavidez buscará pelear contra el púgil azteca, Gilberto “El Zurdo” Ramírez.
ERNESTO ACOSTA
Zócalo | Saltillo
La Diócesis de Saltillo requiere de más de 150 mil pesos para acondicionar y amueblar la casa Esperanza de Belén, que dará posada, al menos a 12 mujeres embarazadas para brindarles apoyo médico, sicológico, espiritual, jurídico y capacitación para el trabajo, para evitar que aborten.
El sacerdote Vicente Eliamar Vega Carrales informó que ofrecerá servicios a cualquier embarazada, sin importar su religión.
“El objetivo es hacer una casa llamada Esperanza de Belén un medio de ayuda a mujeres embarazadas que tengan alguna dificultad para llevar adelante este proceso tan importante para la vida humana. A veces se critica, con pocos argumentos, que las acciones pro-vida no aportan nada práctico o eficiente para la ayuda de la mujer”.
Ubicación
La casa, que recibió en donación la Diócesis de Saltillo, se ubica en la colonia Satélite Sur, en el número 3480, a un costado del periférico Luis Echeverría Alvarez, y abrirá sus puertas en dos o tres meses más.
“La institución que más altruismo hace alrededor del mundo es la Iglesia católica y parte de eso es esta iniciativa que está en semilla, pero con la ayuda de toda la sociedad civil, de todos los creyentes, de medios de comunicación, sabemos que muy pronto este proyecto podrá estar ejecutando el servicio que pretende dar”.
Adviento, muy significativo
El anuncio del arranque formal del proyecto se da en el tiempo religioso de Adviento, que anuncia el nacimiento de Jesucristo, quien experimentó la dependencia de una madre que lo cuidara y acompañara para cumplir su misión de vida.
¿Desea apoyar?
z Llamar al 844 159 8477. Abrirá en 2 a 3 meses. ¿CON QUÉ CUENTA?
z La casa Esperanza de Belén, que contará con capilla, consultorio médico y ginecológico, nueve recámaras, cocina, comedor, sala, bodega, lavandería y jardín, requiere de trabajos de rehabilitación como instalación de cableado eléctrico, sistema hidráulico, pintura, impermeabilización, pintura, puertas, camas y demás mobiliario.
RESPALDO JURÍDICO
z Las mujeres recibirán respaldo jurídico y, si lo plantean, serán asesoradas para reclamar la pensión alimenticia al padre del bebé, para que pague los costos de alimentación, vestido, calzado, educación, salud y recreación, como lo establece la ley, en tanto sea menor de edad y luego estudie.
TRABAJO z “Habrá una capacitación para el trabajo, con una vinculación con las empresas de que aquí se les va a capacitar o se les va a llevar a talleres para capacitación, para que una vez que los días clave posteriores al embarazo hayan pasado, se facilite la contratación de estas mujeres en alguna empresa”, informó el responsable de la Pastoral de la Vida.
“Bienvenidas a partir de que tengan un embarazo y que tengan una dificultad para llevarlo adelante. Aquí recibirán el apoyo del albergue, el apoyo sicológico, médico y espiritual. Una vez que se dé el embarazo esperamos un tiempo prudente que puedan seguir albergadas aquí, valorando cada caso, estaríamos diciendo, dos o tres meses por estándar, más si hubiera necesidad esto se puede extender”.

el producto.
Se violenta con el aborto
El derecho fundamental a la vida: Iglesia católica
ERNESTO ACOSTA
Zócalo | Saltillo
El padre Vicente Eliamar Vega Carrales señaló que, lamentablemente, se mantiene activa la práctica del aborto, sobre todo en las clínicas de salud y en el Hospital General de Saltillo, sin importar que la vida inicia desde el momento mismo de la concepción, como está comprobado científicamente.
“¿A partir de qué momento hay una vida? Esto lo afirma la ciencia desde el momento mismo de la concepción: se inaugura un código genético nuevo, único, diferente e irrepetible y empieza el embrión, en un principio, luego el feto, el bebé”. En un embarazo, indicó, ocurren situaciones médicas maravillosas y asombrosas, por ejemplo, en el momento del parto, es el bebé, quien hormonalmente define el momento en que inicia el trabajo de parto y no la mamá.
“¿Por qué debe optar la mu-


Millones de fieles de todo el mundo admirarán el regalo de Coahuila para el Papa
JESÚS CASTRO
Zócalo | Saltillo Ya concluyeron la elaboración de la Villamagia coahuilense en El Vaticano, con una réplica del Nacimiento de la Plaza de Armas de Saltillo y que ahora será admirado junto con una imagen de la Catedral por millones de fieles de todo el mundo, en el interior de la Basílica de San Pedro. Esperan inauguración Desde inicios de noviembre, coahuilenses se encuentran en El Vaticano trabajando en la construcción de una réplica del Nacimiento, que se expone en Coahuila, y que para el día 21 de este mismo mes ya había tomado forma en la principal iglesia del catolicismo.
Todavía esta semana se afinaron los últimos detalles del Nacimiento, el cual, según dieron a conocer, ya está totalmente concluido y en espera de ser inaugurado por el go-

z El Nacimiento quedó concluido.
bernador Manolo Jiménez Salinas, quien informó desde el martes que viajará la próxima semana a Italia.
Manolo en cena navideña
En dicha gira de promoción, el Gobernador también participará en la Navidad mexicana y cena navideña que empresarios coahuilenses, el Gobierno del Estado y la Diócesis de Saltillo, en coordinación con la embajada de México en la Santa Sede, le ofrecen al papa Francisco. Fue la Diócesis de Saltillo
Otro espacio en La Herradura
REDACCIÓN
Zócalo | Saltillo
A proteger la vida
z Vega Carrales llamó a proteger la vida que nace en el vientre, no pensar en la interrupción del embarazo, pues hay la oportunidad de salir adelante, a pesar de que pueden presentarse situaciones adversas.

jer por el nacimiento del bebé? Primero, porque es el orden natural, porque ya decíamos, toda vida humana es digna, es valiosa, merece ser custodiada y porque todo aquello que atenta contra la vida humana abole, en consecuencia, cualquier otro derecho ¿no? Estamos en un tiempo en el que la bandera común son los derechos humanos”.
El alcalde José María Fraustro Siller cumplió con los vecinos de la colonia La Herradura y aledañas al inaugurar un Centro Comunitario en el sector que transforma y mejora la convivencia, y con el cual la red crece a 34 espacios en la ciudad.
“Esta obra nos la solicitaron en campaña y hoy estamos inaugurando un gran centro comunitario. Desde el inicio de esta Administración hemos trabajado unidos e invertido más de 675 millones de pesos en obras para mejorar la infraestructura, los servicios públicos y las condiciones de movilidad”, refirió el Alcalde. Es una realidad En representación del gobernador Manolo Jiménez, Gabriel Elizondo Pérez, coordinador general del programa Mejora Coahuila, señaló que todo lo que recibió en campaña el Alcalde mediante el programa Chema Te Escucha, hoy es una realidad.
“Toda obra al interior de las colonias es para mejorar
Un regalo para el Papa z En esta ocasión, es la primera vez que un estado, en este caso Coahuila, es el invitado para la instalación del Nacimiento, el cual, junto con una cena navideña, serán el regalo al Sumo Pontífice, por el inicio del Jubileo, y desde donde millones de fieles de todo el mundo verán Villamagia y la Catedral de Saltillo como fondo de dicha representación.
la que ayer publicó en sus redes sociales las más recientes fotografías del Nacimiento de Villamagia, tomadas por el sacerdote saltillense Héctor Pérez, quien se encuentra estudiando una especialidad en Roma.
Además, explicaron que cada año El Vaticano se engalana con luces y adornos para la Navidad con el Nacimiento y pino, tradición que comenzó en 1982 el papa Juan Pablo II, quien sostenía que estas representaciones eran “un signo de fe en Dios”.

Beneficiados
Chema Fraustro mencionó que la obra se llevó a cabo con el apoyo del gobernador Manolo Jiménez Salinas y brindará un espacio de convivencia sana para más de 12 mil personas de colonias como La Herradura, La Herradura Ampliación, La Herradura II y III, Jesús Cabello, Los Nogales, Los Nogales II y III, Lomas de San Javier, Colinas de San Francisco y Vicente Guerrero, entre otras.
Centro comunitario z 180 m2 de construcción z Equipamiento de cocina z Alacena z Servicios sanitarios z Un espacio para acondicionarse como oficina o consultorio z Explanada lateral con cubierta de malla sombra de aproximadamente 140 m2
Hallan mosquitos transmisores hogar en la basura o las acumulaciones de agua dentro de casa
DIANA RODRÍGUEZ
Zócalo | Saltillo
Con el inicio de las bajas temperaturas hay una posibilidad de que disminuyan los contagios de dengue en Coahuila, sin embargo, en las zonas donde existan factores que favorezcan la reproducción y crecimiento de los mosquitos, la enfermedad puede continuar propagándose.
“La enfermedad no se quita con el frío, el virus se propaga a través de la picadura de mosquito, pero al disminuir el crecimiento del mosquito por el clima, es uno de los factores que ayuda en que haya menos para transmitir”, explicó Roberto Cárdenas Zavala, jefe de la Jurisdicción Sanitaria Número 8.
Asimismo, advirtió que, pese a hacer las fumigaciones en lugares abiertos, en las escuelas, en los canales de desague, mantener cacharros acumulados, agua acumulada, agua que tienen estancada y no hay un tratamiento ni los cuidados necesarios, la reproducción puede seguir.
Población de riesgo Además del serotipo de den-

transmisores.
gue, otro factor que influye en que los casos se agraven son las comorbilidades de la persona que se contagia. Dependiendo de las condiciones físicas y de salud de las personas, dijo, puede condicionar una gravedad, pero no a cualquiera. “Hay pacientes que pueden ser hasta asintomáticos o con síntomas muy leves, hasta pacientes que puede ser un serotipo de los que se llama más benigno, pero si el paciente tiene algún tipo de deficiencia inmunológica, diabetes, hipertensión, cáncer, o su sistema inmunológico no muy adecuado, puede condicionar a ser un dengue grave”, advirtió.

Durante el 2024, el estado ha registrado 4 mil 663 casos de dengue y 34 defunciones: z Esto significa un aumento inusual en las cifras históricas, por lo que la Secretaría de Salud ha mantenido las fumigaciones. z En el caso de la Región Sureste, la cifra de contagios es de mas de mil 50 casos positivos y al menos cinco decesos, entre ellos el de un menor de edad.


z Se trata de una donación totalmente humanitaria por parte de la empresa.
Destinada a Facultad de Enfermería
DIANA RODRÍGUEZ
Zócalo | Saltillo
La delegación de la Cruz Roja Saltillo recibió la donación de un autobús que servirá para que la humanitaria institución siga ayudando a quienes más lo necesitan. El camión fue restaurado y entregado por parte de la empresa Atlas y será destinado a la Facultad de Enfermería. El equipo, que fue entregado a mediados de esta semana, servirá para que los alumnos en formación puedan asistir a clases, pero también que puedan emplearlo para trasladarse de forma segura a otras actividades que realizan en apoyo de la comunidad.

z La entrega
La delegación de Cruz Roja agradeció a la empresa por esta contribución que abonará a fortalecer los programas sociales de la humanitaria institución.

Defensor de varios casos difíciles...
Siendo estudiante preparatoriano, Roberto Medina Barragán se desempeñaba como impresor en el periódico Zócalo de la ciudad de Piedras Negras, cuando le nace la idea de estudiar leyes para convertirse posteriormente en un buen abogado, funcionario público y maestro universitario. Mucho tiene que agradecer a los señores Juaristi Septién por haberle dado facilidades para estudiar la preparatoria y, al mismo tiempo, ser el operario de aquella máquina de fabricar encabezados o titulares de los periódicos, denominada Ludlow, bajo un proceso de metal caliente para elaborar las placas metálicas en la impresión, no muy antigua; ahora todo se sustituye a través de la computadora. Medina Barragán nació en el año de 1946, un día 2 de julio, en Playa Azul, Michoacán, hijo de Ludivina Medina Barragán, quien lo trajo a Nuevo Laredo, Tamaulipas cuando tenía 6 años. Su educación primaria la cursó en la escuela Lauro Aguirre (llamada modelo por su alto nivel académico), y continuó con sus estudios en la Escuela Secundaria, cuyo director era el profesor Bonne, y ahí estuvo solo hasta el segundo año, para terminar en la Secundaria Número 1 Andrés Osuna, de la ciudad de Monterrey, Nuevo León. Aprendió el oficio de impresor muy joven y trabajó en el periódico El Porvenir, que dirigía don Rogelio Cantú, como ayudante de talleres. Ascendió como formador y cabeceador de Ludlow, de la cual se convirtió en un experto, que lo llevó a laborar en diversos periódicos, como El Sol de Tampico, de la Cadena García Valseca; El Tiempo y Más Noticias, de don Manuel L. Barragán; Tribuna, de Monterrey, y finalmente en el Zócalo de Piedras Negras, Coahuila, de los señores Juaristi Septién. Fue en esa ciudad fronteriza que Roberto Medina Barragán estudió su bachillerato y, al término, fue becado por el Municipio nigropetense debido a sus altas calificaciones. En el mes de agosto de 1971 arribó a la ciudad de Saltillo
para estudiar en la Escuela de Leyes que dirigía el licenciado Valeriano Valdés y donde fue presidente de la Sociedad de Alumnos en el período 73-74, sentando un precedente al liberar, siendo estudiante, al licenciado Juan Sánchez Segovia, la líder Lidia Hernández y varios presos políticos, cuando era agente del Ministerio Público el licenciado Francisco Javier Robledo Méndez, y Antonio Flores Melo procurador de Justicia del Estado. Medina Barragán fue invitado por el rector de la Universidad Autónoma de Coahuila, el licenciado Óscar Villegas Rico, para impartir el año de 1977 la cátedra de Fundamentos de Derecho Civil en la Escuela de Ciencias de la Administración, consolidándose como maestro fundador de la propia institución. Su vida profesional fue fructífera y activa, pues ocupó diferentes cargos en el Poder Judicial y ejerció su profesión libremente, destacándose en la defensa de los famosos Siete Magníficos, quienes fueron acusados del robo de una caja fuerte propiedad del empresario Marcos Espinosa y del homicidio de Enrique Ramos Dávila, así como del capitán Lugo, acusado de entregar a dos reos a la justicia americana por la cantidad de 80 mil dólares. Dentro de la vida deportiva, Roberto Medina fue jugador de futbol americano en el equipo de los Daneses del Ateneo Fuente, los Tigres de Leyes y head coach de dicho conjunto. En el balompié, participó en los equipos de Leyes e Impresos Mier Narro, y beisbol con el equipo del Foro de Abogados. Asimismo, como estudiante, participó en forma activa en el movimiento de la Autonomía Universitaria y cuéntese que el entonces secretario ge- neral de Gobierno, Óscar Villegas Rico, le pidió a Medina Barragán que la Facultad de Jurisprudencia no interviniese, que ya estaba elaborado el proyecto de la Autonomía, contestándole Medina Barragán: “No queremos que no la dé, queremos ganarla, y la Facultad no puede ni debe permanecer al margen”. Terminó su actividad profesional en el área de la investigación en la Procuraduría General de Justicia del Estado.

z Se estará trabajando hasta el último día para que la próxima gestión comience sin entretiempos.
Afina Alcalde
los últimos detalles para entregar una Administración limpia
ARTURO ESTRADA
Zócalo | Saltillo
La gestión de José María Fraustro Siller dejará una bolsa cercana a los 20 millones de pesos para que la Administración de Javier Díaz pueda iniciar con obras de pavimentación.
El edil saltillense garantizó que el siguiente Ayuntamiento podrá arrancar sin cargas y con dinero en bancos.
“Vamos a dejar las cosas todo bien, todo arreglado y con recursos para que inicie la siguiente Administración”,
comentó.
No dejará pendientes Los recursos del programa de la Regularización de Vehículos Usados de Procedencia
Extranjera de este 2024 se estarán aplicando hasta el siguiente ejercicio. “Tenemos obras aquí, en los ejidos, que no hemos entregado… Como pozos de agua, como situaciones de infraestructura para el ganado. Pero vamos a estar yendo allá la semana que viene. Hasta el día último vamos a estar trabajando”, afirmó. Fraustro Siller destacó que se han hecho esfuerzos importantes para no dejar pendientes ni problemas a la próxima Aministración, ya sean de carácter financiero, obras o programas inconclusos.
Hay muchas políticas que están establecidas; Javier conoce muy bien de eso. Así que no tenemos problema con este ejercicio de transición que ya está operando, que está bien”.
Chema Fraustro Siller Alcalde

Buscan alcanzar a trabajadores
ARTURO ESTRADA
Zócalo | Saltillo
Con la intención de ampliar los alcances de los diversos programas que se focalizan mediante la estrategia Mejora Coahuila, a partir de 2025 se estarán llevando campañas a los parques industriales para que los trabajadores coahuilenses puedan tener acceso a diversos beneficios.
El coordinador estatal de Mejora, Gabriel Elizondo Pérez, aseguró que se realizan esfuerzos para que, en el próximo año, se supere el medio millón de beneficiarios de los programas y actividades organizadas, en pro de los empleados y sus familias.
“Mucha gente sale a trabajar a las 8 de la mañana y regresa hasta las 8 de la noche a su casa. Es muy importante para nosotros la vinculación con las empresas para llegar a los puntos laborales con las brigadas y poder ejecutar esos programas”, comentó el coordinador estatal.
Beneficios
z En este 2024 se han impulsado mercados a bajo precio, operaciones de catarata, brigadas de salud, el programa alimentario, de tinacos, pintura, impermeabilizante, cemento, y demás acciones para apoyar la economía familiar.
480 mil
personas han sido beneficiarias este año
Mayor alcance
Recordó que hay casos como trámites de licencias de conducir, actas, plaqueo, vacunación, brigadas o mercados que, por cuestión de horarios, muchos trabajadores no pueden acceder a ellos. “Estamos buscando aquí en Saltillo parques, aprovechado el tamaño, pero no queremos interrumpir las labores, así que a lo mejor podríamos hacerlo en los recesos que se tienen, poder focalizar eso”, apuntó.
Usa a 29 menores en Frontera
JESÚS CASTRO Zócalo | Saltillo
Los detalles
Se aprobó como sanción una multa por 10 mil 857 pesos: n Deberá entregar a la Administración General de Ejecución Fiscal del Gobierno del Estado, en un plazo de 30 días hábiles.
El Tribunal Electoral de Coahuila multó al alcalde Roberto Piña, por usar a 29 menores de edad en su campaña electoral de redes sociales, sin el consentimiento de sus padres, cuando fue candidato para intentar reelegirse en Frontera. A seis meses de que concluyó el proceso electoral para renovar las 38 alcaldías, el Tribunal local todavía está resolviendo denuncias, y esta semana concluyeron el procedimiento especial sancionador por la denuncia de un ciudadano contra Roberto Piña Amaya, Alcalde de Frontera. Al analizar el caso, lo declararon culpable de la infracción, al acreditarse la difusión de la imagen de 29 niñas, niños y adolescentes, a través de cuatro publicaciones en los perfiles de Facebook del Alcalde.
ingresó


Mayra Valdés expuso los resultados durante el año y la erradicación de la violencia de género
LUIS DURÓN
Zócalo | Saltillo
En Coahuila el que agrede a una mujer se mete con todas las instituciones de Gobierno, así inició su comparecencia ante el Congreso del Estado
Mayra Lucila Valdés González, secretaria de las Mujeres, quien señaló que el gobernador Manolo Jiménez Salinas ha declarado su gestión como el Gobierno de las Mujeres. La secretaria expuso los resultados y las acciones que se han implementado durante el año a favor de las mujeres y la erradicación de la violencia de género, con la implementa-
Puntos violeta
z Una de las acciones más destacables, señaló la funcionaria estatal, fue la implementación de los puntos violeta en las tiendas Oxxo, los cuales cuentan con un botón de pánico para que las mujeres que se encuentren en riesgo puedan solicitar ayuda en los mismos, este programa es apoyado por la empresa Femsa.
ción de programas como becas a adolescentes embarazadas, programas para apoyar a mujeres emprendedoras, apoyo para que las mujeres concluyan sus estudios de bachillerato y hasta puedan iniciar una carrera.
Fiscalía de las Mujeres En el tema de combate a la

violencia de género, la secretaria expuso que durante el primer año de Administración del gobernador Manolo Jiménez se creó la Fiscalía de las Mujeres, donde se atenderán todos los delitos relacionados con la violencia de género como los feminicidios, la violencia familiar o la violencia sexual, entre otros.

Expresó que en 2024 se atendieron 10 mil 579 denuncias por violencia familiar, delito que tuvo un alza de 18% en la incidencia, en 2023 se atendieron 8 mil 904 denuncias por este delito. Señaló que los casos han sido canalizados a las instancias judiciales y se dio atención integral a las mujeres víctimas de violencia.
Educación En coordinación con la Secretaría de Educación, alrededor de 2 mil 500 mujeres pudieron cursar la preparatoria y obtuvieron su certificado, con lo que amplían sus oportunidades de obtener un trabajo formal y hasta cursar una carrera universitaria. Este programa también se llevó a los centros penitenciarios femeniles, donde 25 mujeres privadas de su libertad obtuvieron su certificado de bachillerato. Al finalizar su comparecencia, la secretaria pidió a las diputadas que trabajen en conjunto para implementar más acciones a favor de las mujeres y para erradicar la violencia de género, solicitud que fue aceptada por la diputada presidenta de la junta de gobierno Luz Elena Morales Núñez.
Urge un CJEM en la Carbonífera z Luego de su relatoría, la secretaria fue cuestionada por las diputadas que integran la Comisión de Igualdad, No Discriminación y Atención a Grupos de Personas en Situación de Vulnerabilidad, entre ellas la diputada Zulma Berenice Guerrero, de UDC, quien solicitó a la secretaria se instale un Centro de Justicia y Empoderamiento para las Mujeres en la Región Carbonífera.
Convivencia sana
ERNESTO ACOSTA
Zócalo | Saltillo
La Diócesis de Saltillo realizará la posada especial para los monaguillos y monaguillas, niñas, niños y adolescentes que ayudan en la celebración de las misas, sacramentos o momentos espirituales para mantener viva la fe entre los feligreses. Además, hay quienes, con el paso del tiempo deciden dedicarse al sacerdocio o transformarse en monjas. El festejo se realizará el próximo sábado 14 de diciembre, con la asistencia del obispo Hilario González, en las instalaciones del Seminario Diocesano de Saltillo, de 10 de la mañana a 2 de la tarde, para participar en una experiencia llena de fe y de convivencia fraterna. Habrá refrigerio, piñatas, juegos y obsequios, así como shows infantiles, con diversas actividades de recreación y esparcimiento para fomentar la sana convivencia.
“Hay parroquias que no tienen monaguillos, hay las que
LUIS DURÓN
Zócalo | Saltillo
Los dos feminicidios ocurridos recientemente en Sabinas y Múzquiz encendieron las alertas de la población, al tratarse de una bebé de 6 meses y una joven de 17 años, por lo que pidieron a las autoridades se instale un Centro de Justicia y Empoderamiento para las Mujeres en la Región Carbonífera.
Hay un proyecto
La diputada Zulmma Berenice Guerrero solicitó a la secretaria de las Mujeres, Mayra Lucila Valdés, que se refuercen las instancias a donde las mujeres puedan acudir a pedir ayuda en caso de encontrarse en una situación de vulnerabilidad.
Ante ello, la secretaria expresó que desde diciembre de 2023 se había presentado a la Federación el proyecto de la construcción de un Centro de Justicia y Empoderamiento para las Mujeres en Sabinas, sin embargo, este no fue aprobado. “Nos dijeron que no estaba autorizado, no porque no estuviera bien hecho, sino porque hay estados que no cuentan ni siquiera con un Centro de Justicia y Empoderamiento, lo que buscaban a nivel nacional era que por lo menos todos los estados contaran con un centro”.
Ante Federación
La funcionaria estatal señaló que el próximo año se presentará dicho proyecto de nuevo ante la Federación, con la intención de que las personas que viven en la Región Carbonífera ya no tengan que trasladarse hasta Monclova o Piedras Negras.
8,904 denuncias en 2023
10,579 denuncias por violencia familiar se atendieron en 2024
Registro z El padre Daniel Rodríguez García, promotor vocacional del Seminario de Saltillo, informó que la invitación es abierta y el evento es gratuito, será sencillo y lo único que se solicita es inscribirse con tiempo en un link que se publica en la página de Facebook del Seminario Diocesano de Saltillo, o bien, comunicarse al teléfono 844 344 1885. 6 centros en Coahuila z Coahuila es el estado que cuenta con más centros de Empoderamiento, con seis sedes en diferentes regiones, y con la construcción de uno nuevo en la Carbonífera tendrían cubierta prácticamente toda la entidad.

tienen muchos, las que tienen hasta 40 y asisten arriba de 300, y celebran un evento muy alegre, es una muy buena ocasión para que vayan”.
Arteaga, Parras y General Cepeda
Edición: Liz Hernández
Favorece control financiero con las oportunidades de inversión e industria
ARMANDO MONTALVO
Zócalo | Ramos Arizpe
Por pagar en este 2024 el total de la deuda que procedía de administraciones anteriores, el Ayuntamiento, encabezado por el alcalde Chema Morales Padilla, recibió la calificación crediticia de parte de la Agencia Internacional HR Ratings, quien ratificó la perspectiva estable del Municipio.
La institución financiera revisó al alza la calificación de HR A a HR A+, con perspectiva estable, al considerar que se cuenta con finanzas sanas que favorecerán mayores inversiones para servicios básicos y de mantenimiento en la ciudad.
“En septiembre de 2024, el Municipio amortizó el total de su deuda directa, la cual estaba compuesta por un crédito de largo plazo con Banobras. Se estima que el dinamismo industrial suscitado en el Municipio derivará en un alza de los Ingresos de Libre Disposición (ILD).
“Con esto, no se proyecta la contratación de deuda bancaria de corto o largo plazo durante los siguientes años, por lo que la razón de la Deuda Neta (DN) a ILD sería negativa entre 2024 y 2026”, señaló el comunicado emitido por la Agencia Internacional HR Ratings.
Gestión ejemplar
La austeridad y disciplina pre-


z Esta calificación deja ver que las dos gestiones de Morales Padilla dejaron avances significativos para el Municipio.
supuestaria aplicadas durante las dos administraciones del edil Morales Padilla permitieron saldar el pasivo en su totalidad y aumentar la calificación crediticia, en 2019, a HR A-, con perspectiva estable. Mientras que, en 2020, la evaluación mejoró a HR A con perspectiva estable, manteniéndose así hasta este 2024, en que se alcanza la calificación HR A+, que refleja la capacidad del Gobierno municipal para cumplir con sus obligaciones financieras y mantener una economía en mejoría y sana.

Gran cambio
Al cierre de 2018, el Municipio de Ramos Arizpe registraba una deuda histórica superior a los 98 millones de pesos: z Esto la colocaba con una calificación crediticia HRBBB+, misma que refiere riesgo de incumplimientos.

z Decenas de niños participaron en la actividad que fortalece las tradiciones decembrinas.
Llevan a cabo taller en centro comunitario Tepopa Fortalecen entre niños
Zócalo | Ramos Arizpe
En la biblioteca municipal Dolores González Valdés del centro comunitario Tepopa, ubicado en la zona poniente de la ciudad, comenzó un taller navideño para niñas y niños entre los 6 y 10 años, cuyo objetivo es fortalecer el origen tradicional de las festividades decembrinas.
“Nuestro principal propósito es fomentar en las familias el rescate de las tradiciones navideñas que vivimos en nuestro país, realizando un trabajo que eleva la creatividad de los participantes”, dijo Haydeé Aguirre Gutiérrez,

quien reconoció y destacó el apoyo de la Red Estatal de Bibliotecas. Los menores utilizaron distintos materiales para la elaboración de sus piñatas, tales como botellas recicladas

Remodelan letras con 819 mil pesos
ARMANDO MONTALVO
Zócalo | Ramos Arizpe
Un total de 819 mil pesos fueron destinados para la remodelación de la entrada sur a la ciudad, ubicada frente a la empresa Deacero, que conduce a Saltillo. Acompañado del director de Obras Públicas, Omar Limón Lara, y del secretario de Servicios Municipales, César Flores Jiménez, el Jefe de la Comuna constató la culminación de los trabajos que incluyeron la colocación de letras gigantes en 3D con el nombre del municipio. Fueron instaladas, de igual manera, lámparas arquitectónicas led, así como reflectores de 300 y 40 watts; se realizaron labores de pintura, reparación de concreto estampado y de pasto sintético, además de que se repusieron las bombas de la fuente ubicada junto a la estatua del Padre del Federalismo, Miguel Ramos Arizpe.
Es simbólico Morales Padilla destacó que se busca fortalecer la imagen de la ciudad, el sentido de identidad y pertenencia entre quienes viven en Ramos Arizpe,

Tenemos un alto flujo vehicular en esta zona, por lo que era necesario mejorar las condiciones de la entrada, la cual viene a complementarse con la Entrada Monumental que está frente al Aeropuerto Plan de Guadalupe”.
Chema Morales Padilla Alcalde

Creatividad
Cada menor elaboró su piñata de acuerdo con su creatividad: n Ello, teniendo la posibilidad de llevar su trabajo a su hogar, promoviendo el fortalecimiento y rescate de las tradiciones en diciembre
de diferentes tamaños, papel de china, pintura verde y blanca, diamantina, resistol blanco, papel crepé, yeso y pinceles, entre otros.

Sigue vigente evento del Buen Fin
ARMANDO MONTALVO Zócalo | Ramos Arizpe
El delegado de la Cámara Nacional de Comercio local, Mario Aguirre Rangel, informó que ya se repartieron 15 mil de 25 mil boletos que se mandaron a imprimir, entre las personas que compraron en los más de 200 negocios afiliados a esta agrupación, para participar en la rifa de 50 mil pesos el próximo 20 de diciembre.
Este evento comercial se preparó para seguir promoviendo el consumo local entre los negocios formales en Ramos Arizpe durante el pasado Buen Fin, celebrado en noviembre.
La mecánica para participar en este sorteo es comprar más de 300 pesos en productos y servicios en los comercios afiliados a Canaco.
Apoyan comercio local “Todos los ramosarizpenses y quienes deseen comprar en los negocios establecidos en
Nuestro objetivo es que las familias consuman siempre en lo local y que un ramosarizpense sea el ganador de los 50 mil pesos, porque en las últimas semanas muchos saltillenses y regiomontanos han visitado Dinolandia y visitan los comercios de la localidad”.
Mario Aguirre Rangel Delegado de la Canaco además de que se dejan claros los límites territoriales del municipio.
la ciudad todavía están a tiempo para participar”, dijo Aguirre Rangel. Agradeció al Ayuntamiento por aportar el apoyo económico para la celebración del sorteo que fue del agrado de las personas que compran en los negocios de la ciudad.
Sienta las bases
Jiménez Salinas para una gestión ordenada, a nivel local e internacional
REDACCIÓN
Zócalo | Saltillo
En el marco de su primer informe de resultados, el gobernador Manolo Jiménez Salinas dio a conocer que, a un año de trabajo, se tuvieron grandes resultados y que hoy Coahuila tiene rumbo y va pa’delante.
Jiménez Salinas recordó que, en conjunto con la Iniciativa Privada, la sociedad civil, la academia y los diversos organismos, se cumplieron las metas trazadas para este año, además de fortalecer la coordinación con los poderes Legislativo y Judicial, los municipios y la Federación.
A nivel nacional
El Gobernador de Coahuila recordó que hoy Coahuila se posiciona como uno de los tres estados más seguros de México gracias al fortalecimiento del modelo de seguridad, con más prevención, proximidad, inteligencia y fuerza y una gran coordinación con las policías municipales, el Ejército, la Marina y la Guardia Nacional.
En este año, se adquirieron 237 nuevas patrullas y vehículos tácticos, se construyen arcos de seguridad y nuevos cuarteles para las corporaciones de seguridad, blindando al estado para que las familias coahuilenses vivan seguras y en paz.
En el tema de desarrollo económico, destacó que Coahuila se posiciona como un gran estado para invertir, y que en sólo un año se lograron 59 nuevas inversiones, producto de la promoción económica que se ha dado, captando un monto histórico de 95 mil millones de pesos y la generación de 30 mil nuevos empleos.
Además, hoy Coahuila es líder nacional en producción

z El estado logró diversos galardones y reconocimientos desde encuestas que lo afirman como una entidad ejemplo.
de vehículos y autopartes y se encuentra dentro del top 3 de los estados con mayores importaciones del país.
Al alcance de todos
El Gobernador gregó que, durante su primer año, se desarrolló la estrategia Impulso Educativo, con la cual se distribuyeron 552 mil paquetes de útiles escolares en todas las escuelas públicas del estado, así como 95 mil uniformes y tenis gratuitos en todas las escuelas de nivel básico del área rural y más de 39 mil becas otorgadas. Desde su campaña, Manolo Jiménez se comprometió a llevar desarrollo parejo para todas las regiones, y lo está cumpliendo con grandes obras que generan una mayor competitividad y una mejor movilidad para las y los coahuilenses.
Inversiones necesarias
En este primer año de Gobierno, se invirtió en grandes obras en todas las regiones del Estado, entre las que destacan el bulevar Los Pastores y la prolongación del bulevar Nazario Ortiz Garza, en la Región Sureste; la modernización del libramiento Carlos Salinas, en la Región Cen-
tro; la ampliación del bulevar Chuy María Ramón, en la Región Norte; el gran programa de Pavimentación y el Giro Independencia, en La Laguna, y la remodelación de la autopista Premier. En las regiones Carbonífera y Cinco Manantiales, así como obras sociales de pavimentación, recarpeteo, agua, drenaje, electrificación e infraestructura educativa al interior de las colonias, barrios y ejidos.
Cerca de las familias Además, agregó que se han implementado acciones y programas a favor del cuidado del medio ambiente, agua, apoyo para las familias del campo, y una inversión histórica en el combate y prevención de incendios forestales. Siempre en cercanía con las familias coahuilenses, se impulsaron y fortalecieron diferentes programas, proyectos y obras sociales a través de la estrategia Mejora Coahuila, como los mercaditos, las brigadas de servicios, entrega de escrituras y un mega programa alimentario con el cual se benefició a más de 400 mil familias.
Otro de los grandes resultados que se tuvieron en el pri-
Aquí somos solidarios con las causas más sensibles de las familias coahuilenses”.
Las niñas, niños, adolescentes y jóvenes representan el presente y futuro de Coahuila, por eso estamos trabajando día a día para brindarles todas las oportunidades y que sean parte del desarrollo de nuestra entidad”.
Tuvimos un gran año en donde sentamos las bases para consolidar a Coahuila como el mejor estado para vivir, trabajar e invertir; con desarrollo económico, seguridad y calidad de vida, comenzamos cumpliendo y vienen grandes cosas para nuestras familias”.
Manolo Jiménez Salinas Gobernador
Indicadores
Además de que el estado destaca en el top 3 en Seguridad Nacional, también es reconocido en otros aspectos:
z 95 mil millones de inversión y 30 mil nuevos empleos.
z Segundo estado que más contribuye al desarrollo económico del país.
z Uno de los tres estados con mejor calidad de vida en México.
z El estado más seguro del norte del país.
z El estado con mayor porcentaje de formalidad del país y de trabajadores con prestaciones laborales.
z Líder nacional en la producción de vehículos y autopartes tradicionales y eléctricos.
z 2º estado con mayor desarrollo social de México. z 2º estado más exportador del país.
z 1er lugar en producción de leche, melón y cerveza del país.
z Uno de los 4 estados con mejor estatus zoosanitario para la exportación de ganado.
z Producimos los mejores vinos de México.
z Saltillo es la ciudad más competitiva de México.

mer año de esta Administración, es en el rubro de la salud con una inversión histórica en el programa de Salud Popular, en donde se entregó la Tarjeta de la Salud Popular a personas adultas mayores y con discapacidad severa que no cuentan con seguridad social, y con la que pueden acceder a consultas, medicamentos y estudios de laboratorios, entre otros. Además, se rehabilitaron 133 centros de salud, 14 hospitales generales y se inauguró el centro estatal de medicina, además de llevar 80 caravanas de la salud a colonias, barrios y ejidos para acercar los servicios a las comunidades más alejadas. Como parte de la atención integral para niñas, niños, adolescentes, jóvenes, mujeres y personas adultas mayores y con discapacidad, desde el DIF Estatal, presidido por Liliana Salinas Valdés, se ofrecen servicios de atención médica, entrega de aparatos auditivos y ortopédicos, así como el desarrollo pleno de quien más lo necesita, con acciones para atender, proteger y promover su participación en todos los sectores sociales.

Mientras que, desde la Oficina Inspira, que encabeza su esposa Paola Rodríguez López, se han desarrollado estrategias y programas enfocados a la salud mental, educación y el desarrollo integral de jóvenes y mujeres.

Refuerzan las fumigaciones contra dengue
El Gobierno municipal de Saltillo, en coordinación con la Secretaría de Salud de Coahuila, redobló sus esfuerzos en la lucha contra el dengue, a través de una campaña masiva de fumigación. Luis Alfonso Carrillo González, director de Salud Pública de Saltillo, informó que por instrucción del alcalde José María Fraustro Siller, y con el impulso del gobernador Manolo Jiménez Salinas, se refuerzan estas acciones a fin de evitar la reproducción del mosquito transmisor de la enfermedad. La jornada intensiva dio inicio en la escuela primaria Profesor Rafael Ramírez Castañeda, y consta de trabajo coordinado con la Jurisdicción Sanitaria 8, en el que cuadrillas recorrerán las colonias de la ciudad para fumigar los espacios públicos, así como brindar atención en los hogares para disminuir el riesgo de padecer la picadura del mosquito transmisor.


Derriba moto del hombre por accidente; él se molesta porque llama a emergencias
BRENDA BASALDÚA
Zócalo | Saltillo
Un hombre en estado de ebriedad supuestamente detonó un arma de fuego y amenazó de disparar en el rostro a una mujer que lo chocó, en la colonia Bellavista, donde se movilizaron soldados y autoridades municipales.
Hechos
De acuerdo con las investigaciones, alrededor de las 17:00 horas, Laura “N” estaba estacionada junto con su esposo, abordo de una Nissan XTrail con placas FBM-862-A al exterior de un consultorio, ubicado entre Pedro Aranda y Heroico Colegio Militar.
Según la mujer, avanzó de reversa en su vehículo y no se percató de que atrás estaba estacionado un motociclista, a quien derribó de un golpe, por lo que descendió de su camioneta y alertó al Sistema de Emergencias.
Agrede a la mujer
Cuando Laura llamó al 911 el conductor de la moto se molestó y la agredió verbalmente, supuestamente alegando que no debió pedir el apoyo de la Policía Municipal ni de las ambulancias.

z El incidente se registró en unos consultorios en la calle Pedro Aranda de la colonia Bellavista, frente a la 6a. Zona Militar.
Arrestan a agresor
z Elementos de la Policía
Preventiva arribaron, arrestaron al agresor y aseguraron la motocicleta para trasladarlos al Ministerio Público, en donde también acudió la afectada para interponer la denuncia correspondiente.

Dispara arma corta De acuerdo con los testigos, el hombre sacó un arma corta y comenzó a disparar al suelo, también a las dos llantas frontales de la camioneta y posteriormente apuntó a la mujer en la cara. Los elementos del Ejército Mexicano se percataron de las detonaciones y acudieron a detener al hombre, quien intentaba huir en su motocicleta, mientras la mujer estacionó la camioneta sobre Pedro Aranda.

Fueron 5 disparos z Extraoficialmente se informó que el arma que portaba el agresor era calibre .22, misma que fue disparada en al menos cinco ocasiones y que quedó resguardada por la Policía Municipal, junto con los casquillos.

z El hombre disparó a las llantas de la camioneta de la mujer.
Por no hacer un alto obligatorio y atravesar sin precaución el bulevar Jesús Valdés Sánchez, un automovilista ocasionó un accidente vial, en el que dos jóvenes que viajaban en una motocicleta resultaron heridos.
El percance se registró después de las 7:30 horas de ayer, y fue señalado el conductor de un Volkswagen Bora, con placas STE7070, identificado como Diego Alejandro Corral Rosas, de 29 años, quien al circular de sur a norte por la calle Ignacio de La Llave no hizo el alto en el cruce con Valdés Sánchez y se atravesó al paso de una motocicleta Itálika. Amurabi Ramos, de 20 años, y Sebastián, de 15, cayeron, por lo que sufrieron diversas lesiones. n Augusto Rodríguez

su ojo; le cae trozo de metal
DANIEL REVILLA
Zócalo | Saltillo
La falta de medidas de seguridad provocó que un hombre de 30 años, que realizaba reparaciones en su domicilio de la colonia Teresitas, perdiera el ojo luego de que un fragmento de este material se le incrustara. Los hechos ocurrieron la noche del miércoles, en un domicilio de la calle Parras, donde se encontraba el hombre realizando labores de mantenimiento a su hogar, para las cuales manipulaba un trozo de alambre y unas pinzas de corte. Se indicó que un pequeño fragmento de alambre salió disparado al momento del corte y se encajó en el ojo del lesionado, lo que le provocó un sangrado intenso que alarmó a su familia, por lo que de inmediato dieron aviso al 911.
Robo en restaurante
Grave daño z Pierde la vista: debido a que el metal se le incrustó, el globo ocular tuvo que ser extirpado, por lo que permanecerá internado para monitorear su evolución y así evitar alguna infección.
Una ambulancia de la Cruz Roja atendió la emergencia y determinó necesario trasladar al paciente al Hospital General donde los médicos rápidamente decidieron intervenirlo, sin embargo, poco se pudo hacer por él.
Se indicó que pese al esfuerzo de los galenos, el paciente perdió la vista y el globo ocular tuvo que ser extirpado, por lo que permanecerá internado para monitorear su evolución, a fin de evitar alguna infección.
ULISES JUÁREZ
Zócalo | Saltillo
Daños materiales de consideración provocó un taxista, mismo que por circular bajo los efectos del alcohol protagonizó un aparatoso accidente automovilístico la madrugada de ayer, sobre el bulevar Paseo de la Reforma.
El percance se presentó al filo de la una de la mañana, cuando el operador de un taxi Nissan Tsuru circulaba sobre la mencionada vía con dirección al oriente a una velocidad por encima del límite. Fue al ingresar al distribuidor vial El Sarape que el rulete-

Conductor detenido z Luego de entrevistarse con el responsable, quien apenas pudo articular algunas palabras, los efectivos llevaron a cabo su detención y posteriormente ordenaron el levantamiento de la siniestrada unidad para consignarla a un corralón.
ro no prestó la debida atención al camino, lo que lo llevó a subirse a un camellón, impactándose de lleno contra la división de carriles que conecta con el bulevar Fundadores y el perifé- rico Luis Echeverría Álvarez. El choque contra la base de concreto fue tal que la parte delantera del automóvil sufrió
severos daños, sin embargo, a pesar de lo anterior no se reportaron personas lesionadas.
Huyen acompañantes A decir de testigos que presenciaron lo ocurrido, tres hombres que acompañaban al conductor optaron por abandonarlo y huir de la escena.
DANIEL REVILLA
Zócalo | Saltillo
La Fiscalía General del Estado investiga el robo de más de 30 mil pesos en efectivo, perpetrado al interior de un restaurante en Plaza Patio, a donde llegó un par de ladrones para aprovecharse del descuido de los guardias, que les permitió apoderarse de la caja fuerte.
Hechos
Según la denuncia presentada ante la Fiscalía, fue alrededor de las 9:00 horas, cuando los empleados llegaron al establecimiento para comenzar su jornada laboral, pero se percataron de que la puerta principal estaba forzada y sin candado. Al entrar para revisar se sorprendieron al ver que no estaba la caja fuerte, misma que contenía poco más de 30 mil pesos, producto de las ventas de los últimos días, por lo que llamaron a sus superiores.
Inicia investigación
z La Fiscalía General del Estado inició las averiguaciones, las cuales serán complementadas por un proceso de inspección pericial, con el cual buscan encontrar indicios importantes que los lleven a la ubicación de los responsables.
Revisan cámaras
Los directivos del negocio dieron aviso al 911 alertando a las autoridades, y al revisar las cámaras de seguridad, se percataron de la presencia de dos hombres que ingresan después del cierre. En el análisis de los videos, se percatan de la actitud evasiva de los sujetos, quienes conocían la ubicación de las cámaras, por lo que se cree que pueden ser personas cercanas al establecimiento.

AÚN MUCHO
Anuncia ‘La Reina de los Niños’ sus shows de fin de año en Monterrey y CDMX
AGENCIA REFORMA
Zócalo | Monterrey, NL
A cuatro décadas de carrera y 30 años de ser “La Reina de los Niños”, Tatiana todavía tiene mucho por vivir, disfrutar, aprender y cantar.
Aunque tiene un público cautivo, la cantante busca reinventarse y proponer nuevos temas, como Navidad Rock, cuyo video lanzó en su canal de YouTube hace menos de dos semanas y ya superó el millón de vistas.
“Creo que necesito vivir todavía más cosas, quiero contar más todavía”, expresó la artista, quien promueve sus shows de la Arena Monterrey el 15 de diciembre y la Arena CDMX el 22 de diciembre.
“Me encanta ver cómo las adultas jóvenes reviven su infancia conmigo, se acercan, me saludan, se toman fotos conmigo. A lo mejor algunas son mamás. Que sigan poniendo mi música a través de las generaciones me encanta”.
Y por eso Tatiana se preocupa por presentar nuevas historias.
“Sigo sacando nueva música y sigo alimentando mi canal de YouTube, con nuevo contenido en mis redes, siempre componiendo nuevas canciones, videos. Hace más de una semana lancé el video de Navidad Rock y ya tiene más de un millón de vistas. Gracias por poner tantas veces mis canciones y mis videos”, agregó la regiomontana.
De su amplia discografía, destacó que su canción No me Quiero Bañar, que escribió inspirada cuando su hija Cassandra era una niña, rebasó un billón de vistas y recibió un reconocimiento de YouTube. Comentó orgullosa ser la primera mexicana solista en obtener este logro.
Contó que recientemente escribió el tema Gracias y

z La cantante se presentará el 15 de diciembre en la Arena Monterrey. Por Favor para que los niños aprendan esas palabras porque pareciera que ya nadie se las enseña. “Hice además una canción contra el ‘hate’ que se llama Más Amor, una balada, pero que habla de que hay que ser más empáticos, hay que darnos la mano, ayudar a nuestro prójimo. Que este es el único planeta que tenemos y hay que cuidarlo también. “No nada más voy a cantar para entretener, sino también quiero dejar huella y decir algo que además es congruente con lo que soy y cómo soy. Así trato de hacer mis canciones, no todas tienen un mensaje didáctico, positivo, algu-
Fallece Ze Luis a los 72 años
Agencias
Foto: Zócalo
nas son más para bailar, pero son sanas, divertidas, con calidad, sobre todo bien hechas”.
Como “La Reina de los Niños”, comentó que nunca se ha presentado ante el público infantil como una niña, más bien se considera su “súper heroína”, “su maestra” o “su tía”. Y preparar sus conciertos como el que presentará aquí y en la capital le permite a la artista revivir su infancia y ponerse en el lugar de los niños para entender qué es lo que les gustaría ver.
Así nació la idea de volar en el trineo junto a Santa Clos y hacer nevar, como lo hará en los conciertos Navidad con Tatiana 2024.
EL UNIVERSAL
Zócalo | Ciudad de México
El músico José Luis Gómez González, mejor conocido como Ze Luis, murió el pasado martes 3 de diciembre a los 72 años, como dio a conocer su familia a través de redes sociales; recordado por su autoría de la exitosa canción La Niña Fresa, el compositor pasó sus últimos días de vida en su natal Tamaulipas, al lado de sus seres más queridos. Fue a través de las redes sociales del autor que, desde hace años están a cargo de su familia, debido al estado de salud vegetativo en que se encontraba, que se dio a conocer la noticia de su deceso.
Con un emotivo mensaje, la familia Gómez despidió a Ze Luis, sin dejar pasar inadvertido el hecho de que su obra contribuyó significativamente a la industria musical: “Su música, su pasión y su legado permanecerán en nuestros corazones para siempre, que su música siga siendo fuente de inspiración y consuelo para todos aque-

z El músico tamaulipeco se encontraba en estado vegetativo.
llos que lo amaban y admiraban, descanse en paz, querido maestro Ze Luis, hermano, padre y tío, tu música vivirá por siempre, vivirás eternamente en tus obras”. Gómez González nació en

Llegará en 2025
El documental Becoming Led Zeppelin, que narra los inicios y el vertiginoso auge de la legendaria banda británica de rock, finalmente tiene una fecha de estreno.
Sony Pictures Classics anunció ayer que la película se lanzará exclusivamente en salas IMAX de EU el 7 de febrero de 2025. Por el momento se desconoce si la obra se exhibirá en México si llegará al territorio mediante plataformas de streaming. Dirigido por Bernard MacMahon, Becoming Led Zeppelin se presenta como un híbrido entre documental y concierto, que explora los orígenes de la banda en los años 60 con material nunca antes visto.
Lidera nominaciones
AGENCIAS Zócalo | Ciudad de México
La serie Shogun, de FX, sigue con su gran racha de éxitos, luego de que ayer consiguiera seis nominaciones para las categorías de televisión en la próxima edición de los premios Critics Choice. El reconocido show, ambientado en el Japón del siglo 17, obtuvo un récord en los Emmy al ganar 18 galardones en una sola temporada. Por su parte, Abbott Elementary, Disclaimer, Hacks, The Diplomat, The Penguin y What We Do in the Shadows, empataron con cuatro menciones cada una. En la categoría de Mejor Serie Dramática, Shogun se enfrentará a The Day of the Jackal, The Diplomat, Evil, In-
dustry, Interview With the Vampire, The Old Man y Slow Horses. Mientras, las series de comedia nominadas son Abbott Elementary, English Teacher, Hacks, Nobody Wants This, Only Murders in the Building, Somebody Somewhere, St. Denis Medical y What We Do in the Shadows. Disclaimer, de Alfonso Cuarón, y The Penguin, encabezaron las nominaciones a miniseries, y la categoría principal está compuesta por esos dos programas más Bebé Reno, Masters of the Air, Mr. Bates vs. the Post Office, Ripley, True Detective: Night Country y We Were the Lucky Ones. Las nominaciones a películas se anunciarán el 12 de diciembre, y la gala de premiación será el 12 de enero.

Publican imagen de Jenna
Netflix celebró el final del rodaje de la segunda temporada de Merlina con la publicación de una imagen de Jenna Ortega en el papel de la icónica hija de los Addams.
En ella, Ortega, de 22 años, aparece con su característico ceño fruncido y los brazos cruzados frente a un misterioso escenario que podría ser un cementerio.
“Jenna Ortega cierra el ataúd de Merlina temporada 2. Próximamente en 2025”, escribió la plataforma de streaming en redes sociales.
DAR n Agencias n Agencias
20 de febrero de 1952, originario de Río Bravo, Tamaulipas, desde muy temprana edad mostró interés en la música y, con sólo 12 años, aprendió a tocar la armónica sin ninguna instrucción formal.

Encabeza escuchas en Spotify
AGENCIA REFORMA
Zócalo | Ciudad de México
Por segundo año consecutivo, Taylor Swift fue nombrada la artista con más reproducciones a nivel global en Spotify, acumulando más de 26.6 mil millones de escuchas, según el informe anual presentado por la plataforma.
El top 5 lo completan The Weeknd, Bad Bunny, Drake y Billie Eilish.
El año pasado, la intérprete destronó a Bad Bunny, luego de que el puertorriqueño mantuviera el título por tres años consecutivos a partir de 2020.
En Estados Unidos, la lista es similar: Swift ocupa el primer lugar, seguida por Drake, Zach Bryan, Morgan Wallen y Kanye West.
En cuanto a los discos más escuchados mundialmente, nuevamente Taylor se alza como la reina con su The Tortured Poets Department. Detrás de ella le siguen Hit Me Hard and Soft (Billie Eilish), Short n’ Sweet (Sabrina Carpenter), Mañana Será Bonito (Karol G) y Eternal Sunshine (Ariana Grande).
Los álbumes fueron lanzados este año, con excepción

del de la cantante de Si Antes te Hubiera Conocido, que se estrenó a inicios del 2023. En cuanto a canciones, la más escuchada tanto a nivel mundial como en Estados Unidos fue Espresso, de Carpenter, con más de 1.6 mil millones de reproducciones.
Otras pistas que sonaron fueron Beautiful Things de Benson Boone, Birds of a Feather de Eilish, Gata Only de
FloyyMenor y Cris MJ y Lose Control de Teddy Swims.
El streaming representa la mayor parte del dinero generado por la industria musical: 84% en Estados Unidos, según la Asociación de la Industria Discográfica de América, y el 67.3% a nivel mundial, según un informe de 2024 de la Federación Internacional de la Industria Fonográfica, que rastrea las ventas globales.


z La actriz se volvió tendencia luego de que, por error, diversos
reportaran su deceso al confundir su nombre.
EL UNIVERSAL
Zócalo | Ciudad de México
La actriz Marcela Alcaraz se volvió tendencia en redes sociales hace unas horas cuando algunos medios la confundieron con la realizadora Marcela Alcázar, quien falleció por broncoasfixia tras aplicarle kambó, pomada creada con veneno de una rana.
La actriz, que ha participado en proyectos de televisión como Como Dice el Dicho, compartió a través de un video en su cuenta de Instagram, un video en el que habló de la confusión que hubo, que “la mataron” falsamente y cómo eso ha afectado a su familia, como a su hijo de cin-
Compite La Cocina Va Ruizpalacios por un Spirit
El realizador mexicano Alonso Ruizpalacios fue nominado a Mejor Director en los Spirit Awards, que se celebrarán el 22 de febrero del próximo año en Santa Mónica, California. Ruizpalacios fue considerado, para algunos de manera sorpresiva, por su película La Cocina, y se medirá en esta categoría a Sean Baker (Anora), Jane Schoenbrun (I Saw the TV Glow), Brady Corbet (The Brutalist) y Ali Abbasi (El Aprendiz).
Anora y I Saw the TV Glow fueron las más nominadas, con seis cada una.
n Agencias
co años.
Marcela lamentó que esta noticia que es completamente falsa se haya replicado tantas veces, por lo que pidió a los medios tener cuidado y checar sus fuentes y confirmar la información antes de difundirla.
La joven cineasta fallecida el pasado fin de semana luego de habérsele aplicado kambó en un diplomado espiritual, se llamaba Marcela Alcázar Rodríguez, Su hermana Mariana contó a El Universal que Marcela prácticamente produjo, editó y puso sonido a un video de aves, mientras laboraba en AIFA TV, el canal que pone contenido en el nuevo aeropuerto.



Anuncia segundo embarazo
Amber Heard se convertirá en madre ¡por segunda ocasión!
La noticia fue confirmada por un portavoz de la actriz a People, quien explicó que el embarazo está en sus primeras etapas, y prefieren no compartir más detalles por el momento.
“Aún es bastante pronto en el embarazo, por lo que comprenderéis que no queremos entrar en muchos detalles en esta fase. Basta con decir que Amber está encantada tanto por ella misma como por Oonagh Paige”, dijo el representante.
Hasta ahora, no se ha revelado si Heard, de 38 años, está esperando al bebé de manera natural o mediante una madre sustituta, como ocurrió con su primera hija, quien nació en abril de 2021.
n Agenciaz
Foto: Zócalo Agencias
Fallece princesa a los 87 años
AGENCIA REFORMA
Zócalo | Ciudad de México
La princesa Brígida de Suecia, segunda hermana del rey Carlos XVI Gustavo, falleció a los 87 años, informó el Palacio Real sueco en un comunicado oficial.
La noticia de su deceso fue recibida con gran pesar por parte del monarca, quien expresó sus condolencias a través de un mensaje de profunda tristeza.
“Con gran tristeza, hoy he recibido la noticia de que mi hermana, la princesa Brígida, ha fallecido. Mi hermana era una persona alegre y sincera que yo y mi familia extrañaremos profundamente. Junto con toda mi familia, envío mis condolencias a los hijos y nietos de la princesa Brígida”, se lee en el comunicado.
En homenaje, el rey ordenó que las banderas del palacio de Drottningholm y del palacio de Haga ondearan a media

AGENCIAS
Zócalo | Ciudad de México
Axl Rose, líder de Guns N’ Roses, llegó a un acuerdo con la exmodelo Sheila Kennedy para resolver la demanda por agresión sexual presentada en 2023. Ambos acordaron cerrar el caso de manera definitiva, sin posibilidad de reabrirlo, y asumir sus propios costos legales, según documentos obtenidos por Rolling Stone.
La denuncia, presentada bajo la Ley de Sobrevivientes Adultos de Nueva York, señalaba que el supuesto incidente ocurrió en 1989, en una suite de hotel en Manhattan, cuando Kennedy tenía 26 años.
Kennedy habría conocido al cantante en una reunión donde había sido invitada por una amiga para conocer a la banda. Tras conversar con él, fue invitada a una fiesta en su habitación de hotel, aunque su amiga no fue incluida porque, según Rose, “no era lo suficientemente atractiva”.
Ahí le habrían ofrecido drogas y alcohol. Inicialmente, Axl la habría empujado contra una pared y besado, y, aunque no rechazó el contacto en ese momento, aseguró que la interacción se tornó violenta más adelante.
El rockero la persiguió hasta la habitación del presentador Ricki Rachtman, la empujó al suelo, la agarró del pelo y la arrastró de vuelta a su suite, donde supuestamente ató sus manos con medias y la agredió sexualmente.

z La princesa será enterrada en el Cementerio Real de Hagarparken, en Estocolmo.
asta como muestra de respeto. La princesa Brígida nació en 1937 en el castillo de Haga, siendo la segunda hija del príncipe heredero Gustaf
Foto: Zócalo Agencias
Adolf y la princesa Sibylla de Suecia, según Daily Mail.
En 1961, contrajo matrimonio con el príncipe Juan Jorge de Hohenzollern, historiador de arte, con quien tuvo tres hijos: Carl, Desiree y Hubertus.
A diferencia de sus hermanas, Brígida conservó su título real al casarse con alguien de igual estatus, lo que fue un gesto distintivo dentro de la realeza sueca.
Formada en gimnasia en la Escuela Sueca de Ciencias del Deporte y la Salud, dedicó gran parte de su vida a su familia y a representar a la realeza en eventos oficiales.
Durante varias décadas, residió en Mallorca, donde disfrutaba de una vida tranquila y privada.
La princesa Brígida será enterrada en el Cementerio Real del Hagaparken en Estocolmo, en una ceremonia que se llevará a cabo en la intimidad de su familia, incluyendo a sus hijos y nietos.



Across
Horizontales
1. Femenino de Camilo.
1. Femenino de Camilo.
7. Aguardiente de graduación alcohólica muy elevada obtenido por la destilación de vinos flojos y añejado en toneles de roble.
a las personas a las que se dirige quien habla o escribe.
9. Nombre de la séptima letra del abecedario
10. Símbolo del sodio.
11. Prefijo que indica dirección, tendencia, proximidad, contacto, encarecimiento
7. Aguardiente de graduación alcohólica muy elevada obtenido por la destilación de vinos flojos y añejado en toneles de roble.
13. Ocupen por completo con algo un espacio vacío.
14. Limpia o impecable.
12. Casa señorial antigua.
13. Ocupen por completo con algo un espacio vacío.
15. Pasan la noche al cuidado de un difunto.
20. Sujeto a flatos.
16. Prefijo usado en palabras científicas con el significado de sobre.
17. Lirio.
26. Expresó su opinión.
14. Limpia o impecable.
27. Se apropiaron de algo que pertenece a otra persona.
18. Antigua medida de longitud que equivalía aproximadamente a un metro.
15. Pasan la noche al cuidado de un difunto.
28. Hacer sisas en las prendas de vestir.
20. Sujeto a flatos.
29. Altura desde donde se descubre mucho espacio de tierra o mar.
26. Expresó su opinión.
30. Tortillas de maíz enrolladas con algún alimento dentro.
19. Relativo al norte.
20. Que tiene resultado adverso al esperado.
21. Planta acuática de la familia de las Ninfeáceas que abunda en las orillas del Nilo.
22. Abastecer. Ser suficiente.

9. Nombre de la séptima letra del abecedario
Prefijo que indica dirección, tendencia, proximidad
Prefijo usado en palabras científicas con el significado 17. Lirio.
18. Antigua medida de longitud que equivalía aproximada metro.
32. Cada una de las mujeres que acompañaban a los revolucionarios.
23. Tanto o tan grande.
27. Se apropiaron de algo que pertenece a otra persona
24. Ahora.
25. Existo.
28. Hacer sisas en las prendas de vestir.
36. Ciudad Griega que en la antigüedad fue la más grande de la región de Beocia.
41. Farmacias o laboratorios de medicamentos.
31. Impedir o quitar el movimiento.
32. Hacer aire con el abano.
29. Altura desde donde se descubre mucho espacio de tierra o mar.
42. Aleación de hierro y carbono en diferentes proporciones.
30. Tortillas de maíz enrolladas con algún alimento dentro.
43. Persona que ama.
44. Arbusto tipo de la familia de las Rosáceas.
33. Título honorífico que se da a algunos religiosos cartujos y benedictinos.
34. Séptima letra del alfabeto griego que corresponde a la e larga del latino.
32. Cada una de las mujeres que acompañaban a los revolucionarios.
45. Que ama.
51. Áspero o intratable.
35. Pleito judicial.
37. Sonido que se oye de manera débil y confusa.

Que tiene resultado adverso al esperado. Planta acuática de la familia de las Ninfeáceas
36. Ciudad Griega que en la antigüedad fue la más grande de la región de Beocia.
56. Monedas árabes de oro equivalentes a la cuarta parte del cianí.
57. Severos en el semblante en el modo de mirar o hablar.
38. Peso de ocho onzas aproximadamente o sea dos tercios de la libra romana.
41. Farmacias o laboratorios de medicamentos.
39. Altar en que se ofrecen sacrificios.
40. Tronos o asientos con gradas y dosel.
46. Mugido del toro y de la vaca.
Verticales
42. Aleación de hierro y carbono en diferentes proporciones.
43. Persona que ama.
1. Piezas metálicas con cabeza y punta que sirven para asegurar una cosa a otra.
2. Símbolo del aluminio.
3. Primera sílaba de México.
47. Primeras dos letras del abecedario.
48. Símbolo del níquel.
49. Símbolo del tantalio.
44. Arbusto tipo de la familia de las Rosáceas.
4. “En” en inglés.
45. Que ama.
51. Áspero o intratable.
5. Forma que, en dativo, designa a alguien o algomencionado en el discurso, distinto de quien lo enuncia y del destinatario.
6. Prefijo, denota privación o negación.
7. Quia, para denotar incredulidad o negación.
50. Tercera persona singular presente indicativo de ser.
51. Carta de la baraja que lleva el número uno de cada palo.
52. Segunda nota de la escala musical.
53. Acudir a un lugar.
54. Séptima nota de la escala musical.
56. Monedas árabes de oro equivalentes a la cuarta parte del cianí.
55. Símbolo del cobalto.
8. Forma que en dativo o acusativo designa en España y ocasionalmente en América
57. Severos en el semblante en el modo de mirar o hablar.
Down
24. Ahora.
25. Existo.
31. Impedir o quitar el movimiento. Hacer aire con el abano.
1. Piezas metálicas con cabeza y punta que sirven para asegurar una cosa a otra.
2. Símbolo del aluminio
3. Primera sílaba de México
4. "En" en inglés.

5. Forma que, en dativo, designa a alguien o algomencionado en el discurso, distinto de quien lo enuncia y del destin atario
6. Prefijo, denota privación o negación
7. Quia, para denotar incredulidad o negación
8. Forma que en dativo o acusativo designa en España y ocasionalmente en América a las personas a las que se dirige quien habla o escribe
Relacione: colonias, poblados, ciudades, ríos, montañas, islas, lagos, volcanes, cabos, con el estado al que pertenece. Ejemplo, la solución No. 7

Título honorífico que se da a algunos religiosos
Cada letra representa un número del 1 al 7.
Para resolver
Séptima letra del alfabeto griego que corresponde
Sonido que se oye de manera débil y confusa. Peso de ocho onzas aproximadamente o sea dos
numerograma, ponga debajo de cada letra el número correspondiente y que al final coincida con las sumas de la derecha y de la parte inferior.
Como ayuda damos el valor de dos letras.
Altar en que se ofrecen sacrificios. Tronos o asientos con gradas y dosel. Mugido del toro y de la vaca
47. Primeras dos letras del abecedario
48. Símbolo del níquel
49. Símbolo del tantalio
50. Tercera persona singular presente indicativo de 51. Carta de la baraja que lleva el número uno de
52. Segunda nota de la escala musical
53. Acudir a un lugar

Séptima nota de la escala musical
Símbolo del cobalto


Editor: Christian García
Da cuenta la titular de la instancia sobre actividades realizadas en su primer año de Administración
CHRISTIAN GARCÍA
Zócalo | Saltillo
Tras 12 meses de trabajo al frente de la Secretaría de Cultura, la titular de la instancia, Esther Quintana Salinas compareció ayer ante legisladores en el Congreso del Estado, en el que repasó las actividades que a lo largo del 2024 estableció en las diversas regiones del territorio.
En esta ocasión, Quintana Salinas desglosó las 2 mil 818 actividades que gestionó y entre las que se encuentran conciertos, conferencias, obras de teatro, exposiciones y la Feria Internacional del Libro de Coahuila.
La secretaria de Cultura inició hablando sobre la celebración del bicentenario del Estado de Coahuila-Texas, en la que destacó hechos como la Cabina Fotográfica cuyas imágenes se resguardaron en la Cápsula del Tiempo, así como una gira musical titulada Country Sinfónico llevada a cabo por el grupo Black Cherry y la Orquesta Filarmónica del Desierto, junto al documental Coahuila 200 Años de Grandeza, en el que se repasa la historia que une a ambos estados.
En cuanto a la Feria Internacional del Libro, la actividad más importante en materia de cultura del estado luego de la desaparición de

encuentros como el Festival Julio Torri, Quintana Salinas señaló que en esta edición 26 de la fiesta literaria se contó con una cartelera de mil 113 actividades, y con la presencia de 320 escritores tanto internacionales, nacionales, estatales y locales; contando entre los primeros, autores provenientes de países como Perú, Colombia y Canadá, siendo este último el país invitado a la edición 2024 de la FILC; por otra parte las letras de Estados Unidos estuvieron presentes al ser Texas invitado especial al encuentro, dentro del marco del bicentenario de la fundación, mientras que Chihuahua participó como estado invitado.
es un evento “que debe continuar profesionalizándose”.
actividades se realizaron en 2024
Según añadió Quintana Salinas, se realizaron 74 conciertos que llegaron a un público conformado por 65 mil 500 espectadores, siendo los ejecutantes la Orquesta Filarmónica del Desierto y la Banda de Música del Estado. Las cuales no sólo se presentan en conciertos dentro de teatros, sino también en escuelas por medio de sus conciertos didácticos, los cuales buscan acercar la música de cámara a los niños.
Con 140 mil visitantes y 237 expositores, la Feria Internacional del Libro dejó una derrama económica de 20 millones de pesos, según señaló la funcionaria, y destacó que
En el área de Artes Escénicas apuntó que “El teatro en Coahuila continuó su desarrollo” con actividades como la convocatoria Proyectos de Producción Escénica que tuvieron presencia en la Región Laguna y Sureste. Asimismo la Muestra Estatal de Teatro Coahuila, la cual se realizó después de una presión

Foto:
de los artistas escénicos, así como la reapertura del Teatro de Cámara Jesús Valdés y el Festival de Monólogos de Coahuila. Al final se ahondó más en la forma en cómo se apoya el trabajo de los artistas, según cuestionaron los diputados durante la comparecencia, y se añadió que a esto se abrieron diversas convocatorias. Entre estas están las que se trabajan entre estado y federación como el Programa de Estímulos a la Creación y Desarrollo Artístico (Pecda), en el cual se dieron 43 estímulos con una bolsa total de 2.8 millones de pesos. Mientras que el otro es el Programa de Apoyos a las Culturas Municipales y Comunitarias (Pacmyc), con 11 proyectos, y una bolsa total de 1 millón 250 mil pesos. Otros temas sobre los que se habló fueron las redes de museos, siendo Coahuila el quinto estado con mayor centros de este tipo y la forma de continuar buscando públicos,

Fallece a los 42 años el poeta y escritor Horacio Warpola
AGENCIAS
Zócalo | Ciudad de México
El poeta, ensayista y editor Horacio Warpola falleció el miércoles a los 42 años. En redes sociales, familiares, amigos e instituciones (Secretaría de Cultura, Casa del Lago y publicaciones como el Periódico de Poesía, entre otras) se despidieron y lamentaron su deceso. Nació en 1982 en Atizapán de Zaragoza, Estado de México, y durante 20 años vivió en Querétaro. Entre sus obras destacan "300 versos para la construcción de un protocyborg" y "A dónde iremos cuando no quede bosque y los gatos estén durmiendo".
La página de Facebook del Fonca escribió que Warpola “colaboró, además, en proyectos de literatura electrónica, arte digital, cine experimental y arte contemporáneo”. En 2020 resultó finalista en el Premio de Literatura Digital Julio Torri, otorgado por el Gobierno de Coahuila, con su obra interactiva Tecnomineralia en la cual repasaba de forma poética y documental la historia de los minerales.
Presentan Ciudades de Luz
Más de 600 piezas de una treintena de museos y archivos españoles componen la próxima y ambiciosa exposición del Museo Arqueológico de Alicante (MARQ) Ciudades de Luz. Ákra Leuké, Lucentum, Laqant, que repasa la milenaria historia de la ciudad alicantina desde los cartagineses pasando por los romanos y los asentamientos islámico-medievales hasta los trabajos arqueológicos de la actualidad.

La muestra se presentó ayer en el Museo Arqueológico Nacional por el presidente de la Diputación Provincial, Toni Pérez, el director del MARQ, Manuel Olcina, y la directora del Arqueológico Nacional, Isabel Izquierdo, cuyo centro expositivo ha cedido una “bellísima” colección de monedas cartaginesas y estará partir del 20 de diciembre y hasta mayo de 2025.
Exponen arte sonoro n EFE
El Museo Helga de Alvear de Cáceres acoge desde ayer y hasta el 20 de abril de 2025 la muestra más completa hasta ahora del británico Ryan Gander bajo el título de Ryan Gander. Gruñidos, Silbidos, Gemidos, Ladridos y Gritos, en la que el artista experimenta con escultura, cine, escritura y hasta un proyecto de arte público por las calles del centro de la ciudad. La exposición aglutina un centenar de sus obras, algunas de hace más de 20 años y otras que se exhiben por primera vez en el museo cacereño. Gander señala que su trabajo “no se define por estilos, sino por historias e ideas”.
EL UNIVERSAL Zócalo | Ciudad de México
El reconocido arqueólogo y divulgador de la historia prehispánica, Eduardo Matos Moctezuma, recibió ayer el Premio Sescosse 2024, reconocimiento otorgado por el Icomos (Consejo Internacional de Sitios y Monumentos) Mexicano, instancia asesora de la Unesco en México.
“Su invaluable labor en el Proyecto Templo Mayor, así como su contribución al conocimiento, preservación y difusión del patrimonio prehispánico, lo convierten en un referente de la arqueología y el resguardo de la riqueza cultural de México”, dijo a este diario Saúl Alcántara, presidente del Icomos México. Alcántara señala que este premio busca reconocer a personas, instituciones o colectivos que luchan por el conocimiento, la difusión y la salvaguarda del amplio espectro de bienes culturales y ambientales de México.
“Este reconocimiento destaca la importancia de preservar el patrimonio histórico, artístico y natural como parte esencial de nuestra identidad y reafirma el compromiso de Icomos México y de la comunidad internacional por reconocer y fomentar acciones en favor de la protección del patrimonio cultural y ambiental”, señala Alcántara. “Reconocemos sus méritos profesionales y académicos, por lo cual el jurado lo seleccionó”, agrega el arquitecto. Sobre sus méritos, Alcánta-

z Eduardo Matos Moctezuma, director del Templo Mayor.
ra señala que esta premiación reconoce su trabajo en la comprensión del Templo Mayor y la Zona Arqueológica de Teotihuacán, así como su labor de divulgación de la cultura. “Es un erudito de la cultura mexica, el descubrimiento del Templo Mayor en la década de los setenta del siglo pasado lo posiciona. Así como su libro ‘Muerte al filo de la obsidiana’, que se ha publicado en muchos países. Además de eso, también tiene amplio conocimiento en la cultura teotihuacana, y fundó el programa de Arqueología Urbana”, apuntó.















SERVICIOS DE AGENCIA, UNICO DUEÑO,TODO PAGADO, IMPECABLE INFORME AL TEL 844100-48-81 VOLKSWAGEN
SCALA 2012 BLANCO STD AA EE BA MEN-










VENTA CASAS NORTE

CASA EN FRACCIONAMIENTO BRISAS PONIENTE 2 COCHERAS Y 4 RECAMARAS
$2,100,000.000 INFORMES CEL 844-280-9978 Y 844-416-15-15

COL. REPÚBLICA CASA GRANDE EN ÁREA COMERCIAL 4 RECAMARAS; COCHERA TECHADA (3) AUTOS. TERRENO APROX. 320 M2 CONSTRUCCIÓN 350 M2. $6,000,000 INFORMES 844-280-99-78 SUR

BONITA CASA UNA PLANTA EN FRACC. PARQUES DE LA CAÑADA 3 RECAMARAS CON DOS Y 1/2 BAÑOS COCHERA 2 AUTOS $4,000,000 INFORMES 844-280-99-78
ORIENTE





BONITA CASA COL. PRIVADAS CAMINO REAL $1,900,000 PREVIA CITA; 3 RECAMARAS, 2 ½ BAÑOS, COCHERA TECHADA, COCINA INTEGRAL, SE ACEPTA INFONAVIT INFORMA 844-280-99-78 CENTRO


CASA CENTRICA X CALLE ARTEAGA TERRENO 269 M2. CONSTRUCCIÓN 230 M2. 3 RECAMARAS, COCHERA (3) AUTOS $ 2,900,000.00 CEL 844-28099-78, Y 844-416-15-15

CASA ZONA CENTRO; PRIVADA COAHUILA DOS PLANTAS TERRENO 210 m2. 3 RECAMARAS, COCHERA 3 AUTOS 1-1/2 BAÑO, PATIO AMPLIO, $2,000,000.00 INFORMA TEL 8442809978 TERRENOS Y RANCHOS SUR COL. LANDÍN AL SUR TERRENO DE 882 M2. $2, 500,000.00 ESQUINA ESPECIAL PARA



SERVICIOS INMOBILIARIOS AVALÚOS

NO VENDAS A CIEGAS: SE HACEN AVALUOS ECONÓMICOS
PARA TRAMITES JUZGADO Y/O VENTA DESDE $1,500.00; INFORMES AL TELEFONO (S) CELULAR 844-280-9978 OFICINA 844-41615-15


.EMPRESA FUNERARIA SOLICITA
CHOFER DE 30 A 50
AÑOS, QUE CUENTE CON LICENCIA VIGENTE Y MANEJE VEHICULO ESTANDAR, AMPLIO CONOCIMINETO DE LA CIUDAD DISPONIBILIDAD DE HORARIO Y DE VIAJAR.
INTERESADOS
PRESENTARSE EN MIGUEL HIDALGO # 1228, CASI ESQUINA CON FRANCISCO COSS O COMUNICARSE AL 844-414-44-85

.EMPRESA IMPORTANTE SOLICITA SEPULTUREROS Y AUXILIAR DE LIMPIEZA DE PARQUE FUNERARIO, SEXO MASCULINO MAYOR DE 28 AÑOS CON DISPONIBILIDAD DE HORARIO Y ACTITUD DE SERVICIO. INTERESADOS PRESENTARSE EN MIGUEL HIDALGO
# 1228, CASI ESQUINA CON FRANCISCO COSS O COMUNICARSE AL 844-414-44-85
SOLICITO COCINERA PARA RESTAURANT HORARIO DE 6: 30 AM A 2:30 PM Y MESERO HORARIO DE 7:30 AM A 3:00 PM EXCELENTE SUELDO Y AMBIENTE DE TRABAJO, TEL. 844-272-29-63





VIDEO JUEGOS A COMISION, BUENAS GANANCIAS. 844-870-35-38
SERVICIOS DE HOGAR BÓILER

ARREGLO A DOMICILIO BOILER EN 2 HORASTIREN AGUA, NO CALIENTEN, NO PRENDAN, SARRO HIDRONEUMATICOS Y ARREGLO ESTUFAS 844-436-1218 Y 844-203-48-22
A DOMICILIO ARREGLAMOS LAVADORAS, SECADORAS, REFRIGERADORES AMERICANOS Y MEXICANOS SERVICIO EL. MISMO DIA. GARANTIZADO.844129-45-00 Y 844-72680-53
PLOMERÍA


VARIOS VENTA Y COMPRA DE TODO



ELECTRICIDAD

INSTALACIONES, REPARACIONES ELECTRICAS, HIDRONEUMATICOSY PLOMERIA INF. AL 844-417-16-27 Y 844-121-20-26 FUMIGACIONES
SERVICIO INTEGRAL
GARANTIZADO FUMIGACIONES Y SANITIZACIONES AL 844213-22-28

SERVICIO INTEGRAL
GARANTIZADO FUMIGACIONES Y SANITIZACIONES AL 844-213-22-28
A DOMICILIO PLOMERO AGUA DRENAJE GAS SE DESTAPAN DRENAJES TUBERIAS SIN EXCAVAR PRECIOS ECONOMICOS TELEFONO 844-28391-18
REFRIGERADORES Y CLIMAS

REPARACION DE REFRIGERADORES, LAVADORAS, PANTALLAS Y MICROS. SERVICIO A DOMICILIO EL MISMO DIA TEL. 844-141-3892 Y CELULAR 844128-48-34
VENDO ARTICULOS PARA EL HOGAR, TV LG 32”, ANTECOMEDOR DE 4 SILLAS, MESA TUBULAR CON VIDRIO, SALA 3 SILLONES, 1 CAJONERA CON 4 CAJONES, COLCHON MATRIMONIAL SEMINUEVO CON BASE , 1 SILLON RECLINABLE, 1 RECAMARA 6 PIEZAS DE MADERA BANAK, ALGUNAS PIEZAS DE LOZA FINA, INF. 844-415-97-38 OTROS

SE SOLICITAN DONADORES DE CUALQUIER TIPO PARA EDGAR
ZAPATA GARCIA. HOSPITAL IMSS 2 INFORMES AL 844-275-25-98





Buscaba reflexionar ante el poder
Deja un legado de exposiciones y movimientos sociales
AGENCIA REFORMA Zócalo | Ciudad de México
Antonio Gritón (1953-2024), el artista visual y activista que durante décadas utilizó el arte como un arma para denunciar las injusticias socia-
les, falleció la madrugada del miércoles. Hace unas semanas se confirmó que padecía cáncer y murió en su casa, acompañado de su familia. Sus hijos, Silvestre y Esmeralda Ortiz Unceta, compartieron mensajes en redes sociales, donde recordaron a su padre como un hombre comprometido.
“Hace unas semanas mi papá me dijo que había disfru-

tado el viaje, que se había divertido y que estaba contento con su vida. Hoy se fue dejando un legado humano sin igual”, publicó Silvestre. “La vida de mi papá estuvo igual de llena de color que todos sus cuadros. Me enseñó a luchar, a tener mis propias ideas, a siempre inten- tar ser feliz en la vida. Él fue un grandísimo ejemplo de rebeldía y el cielo ha ganado una gran persona”, escribió Esmeralda.
Nacido en la Ciudad de México el 24 de agosto de 1953, Antonio Ortiz Herrera “Gritón” se destacó por su amplia gama de expresiones artísticas, desde la pintura y la escultura hasta la instalación, el performance y el arte público.
Sus obras, siempre cargadas de un fuerte contenido político, abanderaron la lucha por los derechos humanos y la justicia social.
A través de su trabajo, Antonio Gritón invitaba al espectador a reflexionar sobre su entorno y a cuestionar el statu quo. Decía que no le interesaba atraer a los compradores adinerados sino motivar en el espectador una crítica reflexiva sobre su entorno.
Se asumía como “un vocero de los grandes sectores de la sociedad” y, por ello, su obra estaba en una “constante metamorfosis”.
Estudió Física en la Facultad de Ciencias de la UNAM; su carrera comenzó en 1979 como un artista autodidacta cuya obra, a decir suyo, tenía como rasgo continuo la transgresión de la autoridad.
Pero no sólo era un artista, sino también un activista comprometido. Organizó la toma de la Avenida Reforma en 2003 con más de un centenar de artistas para no dejar la política cultural solo en manos del Gobierno y la iniciativa privada.
Convocó a la comunidad artística a involucrarse políticamente en contra de la reforma petrolera y los festejos oficiales de 2010, además de vincularse con los movimientos que reclaman justicia en el caso de los 43 estudiantes desaparecidos de Ayotzinapa. Creadores, organizaciones e instituciones como las secretarías de Cultura federal y local lamentaron su muerte y reconocieron su legado.
Triste por la muerte de Antonio Gritón, la artista Mónica Mayer expresó su “enorme cariño y montón de admiración” por él.
“Siempre recordaré una larga conversación que tuvimos a partir del arte, cuando él, en 2012, realizó una potente instalación en el camellón de la calle de Orizaba llamada Tristeza infinita, sobre la violencia en nuestro país. Me conmovió tanto, que la repliqué en mi jardín”, narró Mayer en Facebook.
A la instalación se agregó la Antena para cambiar al mundo en el Pabellón 02, alterno a la 58 Bienal de Venecia, en la isla de Giudecca. En su memoria, la artista colocará nuevamente unos listones negros en el jardín. “Pero sé que siempre que piense en ti, sonreiré”, anunció.
La estrella de Stellantis, armada en Derramadero
JESÚS JIMÉNEZ ÁLVAREZ
Zócalo | Saltillo
La camioneta RAM, ensamblada en Derramadero, se convirtió en las más vendida de Stellantis en el mercado mexicano en noviembre. De las 8 mil 579 unidades que la marca colocó en las distribuidoras de nuestro país, 3 mil 508 fueron unidades saltillenses. Después de RAM, están
Jeep, con mil 643 unidades; Peugeot, con mil 563; Dodge, con mil 112; Fiat, con 615 y Alfa Romeo, con 38 vendidas. “Seguimos mejorando nuestra gama de productos y para cerrar el año presentamos el Jeep Commander, el cual ya está mostrando gran aceptación en el mercado mexicano”, dijo Antonio Camalich, director de Ventas de Stellntis México.

Para 2025 se fijó un incremento de salario mínimo de 12 por ciento, lo que implicará:
real ha crecido el salario promedio de las personas trabajadoras afiliadas al IMSS
8.5 millones de personas trabajadoras se verán beneficiadas
4.1 millones de personas salieron de la pobreza entre 2028 y 2022 por los incrementos al salario mínimo 23.3%
Fuente: STPS
Los incrementos al salario mínimo no pueden ser la única herramienta para mejorar la condición de los que menos ganan a largo plazo, también hay que aumentar la productividad y abatir el empleo informal.
n Página 2H
De las mejores para 2025
La revista Car and Driver incluyó a la RAM 1500 en su lista de los 10 Mejores Vehículos para 2025. Este reconocimiento aplica a toda la gama RAM 1500. “La competencia en el segmento de camionetas es feroz. Es un honor tener a la RAM 1500 como la única pickup en la lista 10Best para 2025”, dijo Chris Feuell, CEO de las marcas RAM y Chrysler.

3 mil 508 fueron RAM saltillenses.
JESÚS JIMÉNEZ ÁLVAREZ
Zócalo | Saltillo
Después de 13 años de operar bajo la franquicia Quality Inn, el Eurotel Saltillo será parte de la marca By Hilton, a finales de marzo o principios de abril de 2025, una vez que concluya su ampliación y remodelación total y esté listo para su reapertura.
El Eurotel, propiedad del grupo American Hotels Group, encabezado por el empresario
Karim Saade Charur, cerrará totalmente sus operaciones a partir del próximo fin de semana, para facilitar las obras de ampliación y reconstruc-
ción, que elevarán a 205 las habitaciones del complejo. “Será una remodelación total, y aunque nos vamos a llevar un buen tiempo, nos permitirá estar en mejores condiciones para atender la enorme demanda de hospedaje que exige el crecimiento industrial y dinamismo económico de Saltillo. Nos estamos preparando para el futuro”, dijo Saade Charur, presidente y director general del grupo hotelero. Mientras terminan los trabajos de remodelación, el personal del Eurotel será colocado en los demás hoteles del grupo aquí en Saltillo.

La de noviembre es la mayor baja para un mismo mes en más de 16 años
AGENCIA REFORMA
Zócalo | Ciudad de México
De enero a noviembre, el Instituto Mexicano del Seguro Social (IMSS) reportó el registro de 619 mil 252 plazas laborales, una reducción de 40.2% respecto al millón 36 mil 372 puestos inscritos en el mismo lapso del año anterior.
Además, esta cifra es menor al promedio de un millón 98 mil 48 empleos formales de los últimos tres años, añaden las cifras del IMSS.
Al 30 de noviembre, se tenían registrados ante el Instituto 22 millones 643 mil 638 puestos de trabajo, lo que implicó un incremento de 1.0%, su menor tasa anual en 43 meses.
“La buena señal es que existe generación de empleos formales, sin embargo arrancamos el primer trimestre con proyecciones de cerrar el año en unos 700 mil nuevos empleos y no será así”, afirmó Alberto Alesi, director general de ManpowerGroup México, Caribe y Centroamérica.
Alesi comentó que los años previos fueron récords donde se alcanzaron el pico de los 22 millones de trabajadores formales.
Agregó que este es un año atípico, lleno de incertidumbre que ha impactado en las expectativas de crecimiento que se tenían en todos los sentidos y que se encaminan ha-
Créditos, congelados
número de puestos de trabajo generados de enero a noviembre
cia expectativas más conservadoras, opinó. Sólo en noviembre se crearon 24 mil 696 plazas para ser la menor generación de empleos un mes de noviembre en 16 años. ManpowerGroup destacó que esta es la mayor baja para un mismo mes en más de 15 años. Citibanamex dijo en un reporte que con cifras desestacionalizadas el empleo disminuyó 0.1% mensual en
EDITH MENDOZA Zócalo | Saltillo
El incremento de 12% al salario mínimo, anunciado este miércoles por el Gobierno federal, no afecta a los usuarios del instituto que tienen sus créditos en VSM (Veces el Salario Mínimo), puesto que el pasado 11 de noviembre, el director general, Octavio Romero Oropeza, anunció que todos esos créditos están congelados; es decir, no van a subir ni su saldo ni su mensualidad en enero. Gustavo Ernesto Díaz Gómez, titular del Infonavit en
Coahuila dijo que todos los trabajadores deben sentirse seguros y protegidos, y recordó que luego del anuncio del congelamiento de créditos, en Coahuila automáticamente se cambiaron a pesos unas 25 mil cuentas, a quienes les queda una mensualidad igual o menor, pero por su condición, aún quedan pendientes unos 42 mil créditos. Tras reiterar que ya no suben en enero como en los años pasados, hizo énfasis en aquellos casos que no han cambiado su crédito a pesos, acudan a los diferentes cen-
noviembre, siendo la segunda contracción luego de tres meses estancado en el mismo nivel.
“Hay una clara desaceleración en la generación de puestos formales”, aseguró. Por sectores económicos, el mayor aumento en empleo formal fue en transporte y comunicaciones, seguido por comercio, así como electricidad, con 5.0, 2.8 y 2.0%, respectivamente.

z Las oficinas del Infonavit estarán abiertas los días hábiles de diciembre.
tros de atención para verificar la situación. Algunos presentan descuentos en su mensualidad y en otros casos, descuentos en sus saldos.
Las oficinas del Infonavit estarán abiertas los días hábiles de diciembre de 8:30 a 14:30, y los sábados de 10 de la mañana a 14:00 horas, donde el personal podrá brindar la asesoría necesaria sobre las diferentes alternativas.
Es una responsabilidad del sector patronal apostar por un mejor estilo de vida para sus colaboradores, dicen
EDITH MENDOZA
Zócalo | Saltillo
Aunque el sector industrial de la Región Sureste de Coahuila está muy lejos de pagar el mínimo a sus trabajadores, la Coparmex Coahuila-Sureste aplaudió el acuerdo tripartita que derivó en esta medida para el beneficio de los trabajadores y sus familias.
“Este incremento es un acuerdo tripartita entre los sectores empresarial, de trabajadores y el Gobierno. Por el lado de los empresarios demostramos nuestro compromiso en mejorar el ingreso de nuestras y nuestros trabajadores, mejorando a la vez las condiciones laborales”, dijo Alfredo López Villarreal, presidente de dicho organismo empresarial.
Recalcó que es una responsabilidad del sector patronal apostar por un mejor estilo de vida para los colaboradores, que constituyen la parte más importante del proceso productivo.
Continuaremos invirtiendo en nuestro país con una visión social, sosteniendo el compromiso de generar más y mejores empleos, mejorar la calidad de vida y de esta forma continuar fomentando el desarrollo económico de nuestro país. Cabe recordar que por consenso unánime, desde esta semana se decretó el incremento del 12% a los salarios mínimos en todo el país que entrará en vigor a partir del 1 de enero de 2025, mismo que beneficiará a 8.5 millones de trabajadores. Sin impacto en la Región Por su parte, la Canaco Saltillo consideró que la medida no tendrá un impacto significativo en el sector comercial de esta Región Sureste, donde la competencia por tener trabajadores ha presionado el nivel de ingresos, por lo que el pago mínimo supera dos sa-
Índice de Flotación

Por el lado de los empresarios demostramos nuestro compromiso en mejorar el ingreso de nuestras y nuestros trabajadores”.
Alfredo López Villarreal Coparmex Coahuila-Sureste
larios diarios. “El comercio local está en otro segmento… aunque hay casos en los que el atractivo son las comisiones, no hay casos en los que paguen únicamente el mínimo”, recalcó Alejandro Pepi de la Peña, presidente de dicha Cámara, quien señaló que el ingreso promedio en el comercio de la región Coahuila-Sureste, es de 560 pesos. En esta zona se estima que el comercio genera unos 110 mil empleados, todos con ingresos superiores al salario mínimo.
“El problema es que, segmentos que ganan no un salario sino dos, tres, cinco, para ellos no aplica. Los sueldos de este sector van a la baja, cada vez están más cercanos al mínimo del tabulador. Es un costo que paga la clase media cada vez más recortada”, señaló.
DARÍO CELIS ESTRADA
@dariocelise


z Los incrementos al salario mínimo no pueden ser la única herramienta para mejorar la condición de los que menos ganan a largo plazo.
Informalidad, otro lastre
‘Necesario’, también elevar

Avance significativo
Para la Coparmex Jalisco, el reciente ajuste al salario, que entrará en vigor el 1 de enero de 2025, representa un avance significativo para fortalecer la economía de las familias mexicanas y mejorar su calidad de vida.
El organismo indica que el aumento es un paso importante en la búsqueda de un desarrollo económico equilibrado, y es un reflejo del “compromiso conjunto de empleadores, colaboradores y Gobierno para impulsar el desarrollo económico equilibrado y sostenible en nuestro país”.
Desde 2016, Coparmex Jalisco ha promovido la Nueva Cultura Salarial, una iniciativa que ha permitido “garantizar que estas decisiones no comprometan la competitividad ni la generación de empleos”. (Con información de El Universal)

Los indicadores económicos recientes sugieren que la debilidad de la demanda interna en México, iniciada a fines de 2023, continúa siendo una preocupación.
La desaceleración del consumo privado, tanto de bienes como de servicios, está estrechamente vinculada a una menor creación de empleo en el sector industrial. Este fenómeno ha sido destacado en el informe de perspectivas económicas mundiales de la OCDE.
Uno de los factores clave que ha limitado el crecimiento de la inversión pública es la culminación de grandes proyectos de infraestructura en el sur del país.
Al mismo tiempo, se ha observado una disminución en la inversión privada, lo que añade una capa adicional de complejidad a la situación económica actual.
A pesar de estos desafíos, las exportaciones mexicanas han mostrado una notable resiliencia, impulsadas por la fuerte demanda de bienes duraderos en Estados Unidos.
Este aspecto positivo es crucial, ya que las exportaciones representan una parte vital del PIB de México y son un
motor importante para el crecimiento económico. Sin embargo, el organismo que encabeza Mathias Cormann considera que persisten riesgos inflacionarios, especialmente en el sector servicios, donde los precios han crecido un 5 por ciento. Estas presiones inflacionarias pueden dificultar la estabilización del llamado “impuesto de los pobres”, afectando desproporcionadamente a las familias de bajos ingresos. Para enfrentar estos retos, la OCDE recomienda una combinación de políticas fiscales y monetarias. Entre las prioridades destacan la consolidación fiscal, con el objetivo de reducir el déficit público de 5% del PIB en 2024 a 3.2% en 2025. Esto se lograría mediante una disminución en la inversión pública y ajustes en el gasto. Además, se sugiere mantener una política monetaria prudente, lo que implica continuar con la disminución gradual de las tasas de interés, actualmente en 10.25%, para estimular la inversión. Las proyecciones oficiales esperan que las tasas se sitúen en 7.5%
para finales de 2025.
La OCDE también prevé que un uso más sistemático de análisis costo-beneficio, la ampliación de la base impositiva sobre la renta personal, el aumento de la recaudación del impuesto sobre bienes inmuebles y la mejora de la eficiencia de la administración tributaria ayudarían a financiar un mayor gasto en educación e infraestructura.
HUBO HUMO BLANCO en la Confederación Patronal de la República Mexicana: Juan Jo- sé Sierra Álvarez fue elegido su nuevo presidente. Originario de Veracruz y con una destacada trayectoria como vicepresidente nacional de Centros Empresariales y Federaciones, asumirá el cargo el 1 de enero de 2025, sucediendo a José Medina Mora. Su mandato, que se extenderá hasta 2027, se centrará en abordar las preocupaciones de seguridad, Estado de Derecho e incertidumbre en inversiones, temas prioritarios para los empresarios mexicanos.
LA FINTECH MEXICANA Klar adquirió activos clave de Tribal para mejorar su oferta a
AGENCIA REFORMA
Zócalo | Ciudad de México
Los incrementos al salario mínimo no pueden ser la única herramienta para mejorar la condición de los que menos ganan a largo plazo, sino que también se debe aumentar la productividad y abatir la informalidad, consideró Brenda Flores, investigadora de análisis económico en México ¿Cómo vamos?.
Flores consideró que con los ajustes consecutivos al salario mínimo se podrá alcanzar la meta sexenal de cubrir 2.5 canastas básicas con un salario mínimo.
“Actualmente, con el salario mínimo se puede comprar 1.65 veces la canasta básica y en 2025 se cubrirán 1.85 veces, con esas alzas consecutivas puede ser alcanzable que se cubran 2.5 canastas básicas al final del sexenio.
“Lo que hará falta es que se siga justificando esos incrementos con mayor producti-
vidad en el País y no se recurra únicamente al salario mínimo como única herramienta para combatir la pobreza”, consideró.
Manifestó que la productividad en el país se ubica en niveles cercanos a 2008 o 2009, y se debe aumentar para que el beneficio sea a largo plazo.
“El salario mínimo no puede ser la única herramienta para incrementar el salario en el largo plazo, sobre todo lo más necesario es que la productividad en el País crezca, actualmente está en niveles cercanos a los de 2008-2009, si queremos que se vea como un aumento en ingresos a mediano y largo plazo tenemos que incrementar la productividad del trabajo, necesitamos mayor inversión y tecnología”, subrayó Brenda Flores.
Añadió que con los aumentos al salario mínimo sí se ha registrado un aumento en los ingresos promedio de los trabajadores, en particular en el mercado laboral formal.
Presidirá el periodo 2025-2027
AGENCIA REFORMA Zócalo | Ciudad de México
La Confederación Patronal de la República Mexicana (Coparmex) anunció que Juan Jo- sé Sierra Álvarez será su nuevo Presidente para el periodo 2025-2027. Álvarez iniciará funciones el 1 de enero del 2025 y sustituirá a José Medina Mora, quien previamente ocupo el cargo durante cuatro años. En su primer discurso, como Presidente electo, Juan José Sie-
rra advirtió que buscará el fortalecimiento de las micro, pequeñas y medianas empresas. “Las Mipymes son el tejido productivo de País por excelencia y tiene tanto retos como necesidades muy particulares, a las que buscaremos contribuir atendiendo con herramientas y soluciones”, manifestó.
También dijo que entre sus ejes de trabajo está el trabajar para reducir la pobreza y la desigualdad, a través del desarrollo inclusivo.

Pymes. Esta operación permitirá a la empresa de Stefan Möller integrar productos de Tribal bajo su marca, facilitando la interacción con nóminas y cuentas empresariales. Además, la financiera planea desarrollar productos financieros personalizados para pymes, aprovechando los datos financieros gestionados. Esta adquisición se enmarca en la estrategia de Klar de prepararse para una oferta pública inicial en 2026, buscando alcanzar ingresos mensuales de 40 a 45 millones de dólares y un retorno positivo sobre capital. EL OPERADOR DE torres de telecomunicaciones Telesites nombró a Gerardo Kuri Kaufmann como su director general. Kuri, quien dejó el cargo en febrero de 2022, retoma sus funciones tras haber sido reemplazado por un comité ejecutivo. Kuri ha ocupado diversos cargos directivos en empresas del Grupo Carso, propiedad de la familia Slim.
Su regreso a Telesites se enmarca en una trayectoria destacada, incluyendo su rol actual como director general de Minera Frisco desde 2020.
EN OCTUBRE, LA CDMX fue escenario de protestas inesperadas que revelaron una compleja trama de intereses corporativos. Lo que parecía un conflicto entre una desarrolladora y compradores insatisfechos, pronto mostró inconsistencias financieras y falta de denuncias legales. En medio de este escenario, surgieron alianzas como las de Global Businesses, liderada por Federico Cerdas, y fondos canadienses extranjeros como ICM Asset Management, manejada por Scott Salazar Myers y Oscar Ricardo Portillo Rojano. Lo que inicialmente fue un esfuerzo conjunto para revitalizar el mercado, hoy es una disputa que enfrenta a ambos socios, con acusaciones cruzadas sobre incumplimientos y conflictos de interés.
La política impositiva del Presidente electo de EU afectará directamente a empresas de su país, asegura un estudio
AGENCIA REFORMA
Zócalo | Monterrey, NL
Si el presidente electo Donald Trump mantiene su promesa de imponer aranceles del 25% a las exportaciones desde México, afectará directamente a empresas de Estados Unidos proveedoras de industrias como la automotriz, advirtió el Peterson Institute for International Economics (PIIE).
Un análisis elaborado por la investigadora Julieta Contreras describe que con base en la información aduanera que data desde antes del Tratado entre México Estados Unidos y Canadá, es decir, previo a elevar el contenido regional del sector automotriz, los insumos extranjeros incorporados a las exportaciones mexicanas hacia el vecino país representaron el 51 por ciento.
De ese total de importaciones de componentes extranjeros incorporados a los vehículos que se manufacturaron en México y luego fueron exportados, el 74% provino de empresas estadunidenses y el 3% de chinas.
“El cálculo de la participación de origen estadunidense en el valor agregado total de los vehículos importados por Estados Unidos desde México da como resultado alrededor del 38%, es decir, el 74% del 51% de contenido extranjero en los vehículos exportados a todos los destinos, y menos del 2% tiene su origen en China, el 3% del 51 por ciento”.
El PIIE señala que ante esta situación, los aranceles elevados a los vehículos no sólo subirían los precios y conmocionarán al sector automotriz mexicano y a sus trabajadores, sino que también costarían puestos de trabajo en Estados Unidos.

z Del total de importaciones de componentes extranjeros incorporados a los vehículos que se manufacturaron en México y luego fueron exportados, el 74% provino de empresas estadunidenses y 3% de chinas.
Es un ‘balazo en el pie’
JESÚS JIMÉNEZ ALVAREZ
Zócalo | Saltillo
A Estados Unidos es al que menos le conviene imponer aranceles a productos de México y Canadá, porque sería “darse un balazo en el pie, ya que una medida de esa naturaleza, generaría una inflación descontrolada en ese país, porque 72% de los productos que consume se generan en la región del T-MEC”, afirmó Orestes Gómez Rodríguez, experto en economía. El especialista en temas económicos, comerciales e industriales aseguró que las amenazas del Presidente electo de EU, son estrategias que le dan resultados, porque México ha tomado medidas y acciones inmediatas para frenar el paso de fentanilo.
“Los aranceles son un tema en que los tres países han estado presentes, y debemos de re-

z Alejandro Ruiz Rueda, presidente de Index Coahuila norte, explica si al presentar la información, falta algún dato, el trámite inicia desde cero.
HORACIO MARCHAND
hm@horaciomarchand.com
Pangea 2.0
Pangea fue un megacontinente que existió hace unos 335 millones de años, donde estaban unidos todos los continentes en un gigantesco bloque de tierra: una sola tierra, sin divisiones políticas. Ahora mismo, gracias a la migración y a la mezcla de razas, el mundo se encamina, con raspones y tumbos, hacia su destino: devolvernos a unir como uno, en un borroso desvanecimiento de las divisiones etnocentristas.
La humanidad se mueve: todos somos y venimos de migrantes. Se pueden mapear fácilmente las grandes migraciones y oleadas de diásporas, y con ellos, los movimientos económicos masivos.
Primero, los griegos, fenicios y venecianos comienzan a moverse por barco. Los uz-

bekos, turcos y mongoles en caballo. El comercio mundial dispara descubrimientos: tecnología, infraestructura y algo de paz en el camino. Todos quieren lo nuevo, lo remoto y lo exótico: desde especies para sazonar y vestidos de seda para lucir. Llega la era imperialista, con Portugal a la vanguardia. España no se queda atrás: llega a América con Colón y, apresurados, Europa entera se unen a la carrera. Pasan unos 700 años. Hoy en Madrid, el hotel donde me hospedo parece una versión de la ONU. El jefe de recepción es peruano, el de noche es chino-español, llamado Bruce y apoyado por una ucraniana y una mexicana. En el restaurante, el jefe de desayunos es marroquí, la chef argentina, el mesero, un atento cubano de ojos

z Al considerar los resultados hasta octubre, el comercio entre México y Estados Unidos repuntó 6.4% anual a 706 mil 898 millones de dólares.
Se consolida dependencia comercial
AGENCIA REFORMA
Zócalo | Ciudad de México
cordar que hoy en día, hay este tipo de impuestos especiales para ciertos productos como el whisky, el tequila de México y la miel de maple de Canadá, y que son contribuciones que impactan en las economías”, explicó el entrevistado.
Recordó que México es la principal fuente de exportación de autopartes y componentes a Estados Unidos; además de un importante número de productos agrícolas, porque lo sería muy dañino para la economía de ese país, pues provocaría una gran esfera inflacionaria.
“Hay que recordar que Trump hizo dos grandes promesas a los norteamericanos (durante su campaña), detener la migración ilegal y frenar el tráfico de fentanilo, y ya lo está cumpliendo, porque gracias a esas amenazas, en México ya se están tomando medidas muy concretas”, expresó,
De enero a octubre pasado, las ventas o exportaciones de México a Estados Unidos presentaron una pequeña mejora en su ritmo de crecimiento, ya que subieron 6.4% a tasa anual frente a 5.1% en el mismo periodo de 2023. Esto en medio de un incremento de 3.5% en las importaciones (compras) en 2024, luego de un leve traspié en enero-octubre del año anterior, de acuerdo con información del Departamento de Comercio de Estados Unidos.
En este contexto, la economía mexicana destinó un monto récord de ventas al mercado de Estados Unidos por 424 mil 377 millones de dólares, al tiempo que hizo compras sin precedentes en un periodo comparable por 282 mil 521 millones. Así, la diferencia entre las exportaciones e importaciones se reflejó en un superávit histórico para México por 141 mil 856 millones de dólares, después de anotar un alza de 12.8% anual de enero a octubre de este año. Al considerar los resultados hasta octubre, el comercio bilateral entre México y Estados Unidos repuntó 6.4% anual a 706 mil 898 millones de dólares. Lo anterior dio paso a que México conservara el primer puesto como socio comercial
El tramite ante SAT es tardado: Index
6.4% a tasa anual subieron las exportaciones a EU, frente a 5.1% en el mismo periodo de 2023
de Estados Unidos en los primeros 10 meses de 2024, secundado por Canadá, con 637 mil 112 millones de dólares, y por China, con 481 mil 846 millones. Solamente en octubre, el país vendió a Estados Unidos mercancías por 45 mil 492 millones de dólares, un máximo histórico, y le compró 29 mil 116 millones, lo que dio como resultado un superávit en la balanza comercial por 16 mil 377 millones.
Las exportaciones de México a Estados Unidos crecieron 6% anual en octubre y las importaciones disminuyeron 1.9 por ciento.
En el décimo mes del año en curso, México siguió como primer socio comercial de Estados Unidos, con un comercio bilateral por 74 mil 608 millones de dólares, acompañado por Canadá y China en el segundo y tercer puesto como socios de Estados Unidos, respectivamente.
Estados Unidos, México y Canadá forman parte del T-MEC, el cual entró en vigor en julio de 2020 como el acuerdo que sustituyó al Tratado de Libre Comercio de América del Norte (TLCAN).
SIBONEY ALVARADO
Zócalo | Piedras Negras
Al reconocer que hay un atraso por parte del Servicio de Administración Tributaria, en el pago de devoluciones de IVA a empresas que operan bajo el esquema de Immex, Alejandro Ruiz Rueda, sostuvo que puede ser un procedimiento tardado. El presidente de Index Coahuila Norte señaló que, en ocasiones, al momento de presentar la información, si falta algún dato comienza a correr el plazo desde cero y eso puede ocasionar atrasos en el pago de la devolución. “Esto hace el procedimiento tardado. Así se maneja a nivel nacional, por lo que cualquier cosa que necesiten las empresas, cuentan con el respaldo de Index Coahuila Norte no sólo a nivel local sino a nivel nacional”, dijo.
verdes con facciones de ascendencia africana. En la calle camina un rubio fornido con talante vikingo; su pareja, una mujer de baja estatura con facciones sudamericanas. El bebé de ambos: una belleza exótica. Al abordar un taxi, la conductora ecuatoriana, con acento madrileño, nos explica la problemática del tráfico.
Pareciera confirmarse que la época expansionista de Europa siembra las bases para que los conquistados, que hablan frecuentemente la lengua del conquistador, regresan por cientos de miles, o millones, a la madre patria en busca de mejores oportunidades.
¿La conquista de los conquistadores? Latinoamérica y Marruecos regresan a España, al tiempo que varios países árabes y africanos regresan a Francia, Holanda, Inglaterra y Alemania. Los alarmistas gritan que “Europa se pierde”. Lo mismo dicen Huntington y Trump de los migrantes mexicanos, que se con-
centran en estados que antes fueron territorio mexicano. La realidad los migrantes se asientan y se entrelazan. Tras generaciones, se fusionan y se diluyen. Los emplean. Envían remesas a sus respectivos países (casi 700 mil mdd; México recibe unos 67 mil mdd / Banco Mundial, 2023). Respecto al comercio global: en el 1900 representaba un 10% de la producción mundial; ahora ronda en el 25% y seguirá creciendo (UN Trade & Developement). Las medidas proteccionistas recientes son intermitentes: el mundo comercia, los recursos se mueven: dinero, tecnología, insumos y migrantes, lo quieran algunos políticos o no. Por último, quiero cerrar haciendo un contraste de dos tipos fundamentales de migración: La primera: la de los exploradores europeos cuya historia está generalmente romantizada. Ellos iban y “migraban” pero iban a la conquista; a dominar gente, territorios y comercio. A explotar recursos, buscar oro y plata y a esclavizar a pueblos
Señaló que por conducto de Index nacional se tiene contacto con diversas secretarías y eso beneficia a las empresas afiliadas, al tratarse del sector maquilador y manufacturero, uno de los más grandes del país. Sin precisar el número de empresas afectadas, consideró que todas las que trabajan bajo un esquema Immex, en algún momento han tenido atrasos.
nativos. Entiendo, ese era el zeigeist (espíritu de los tiempos) y no busco desgarrarme las vestiduras, tan sólo quiero resaltar la dinámica y contrastarla con la que sigue. La segunda: la de los migrantes que huyen por su vida, atrapados en la violencia imparable en sus países o incluso de guerras civiles. Salen también a perseguir un sueño de logro y de superación. Solos o con familia. Son un recurso invaluable, un bono demográfico en un mundo cuya población viene en decadencia. Contra todo, los migrantes siguen. Huyen de dictaduras, de gobiernos populistas y del desgobierno. Los superan todo; no se cansan. Persisten en su sueño. Los contratan, ponen empresas, salen adelante y enriquecen al país al que llegan. Se adaptan y se integran. El mundo viene del Pangea y todo indica que, cultural y comercialmente, volverá a él. La corriente es imparable, el tsunami global está vivo y activado. Respeto para los migrantes. Todos somos ellos.
‘A los ‘zurdos’ (políticos de izquierda) hay que regresarlos a la coladera de donde salieron’, dice ante líderes latinoamericanos
AGENCIAS
Zócalo | Ciudad de México
Desde Argentina el empresario Ricardo Salinas Pliego criticó al gobierno de Claudia Sheinbaum y al de Andrés Manuel López Obrador por acabar con la democracia e instaurar el régimen unipartidista.
El empresario mexicano se reunió con el presidente argentino Javier Milei y participó como orador en la Conferencia de Acción Política Conservadora, en Buenos Aires, donde llamó a defender la libertad, la seguridad financiera, la propiedad privada y la meritocracia, entre otros valores.
“Hay que tener cuidado cuando creemos que ganamos la batalla cultural porque siempre están ahí los zurdos de mierda y hay que regresarlos a la alcantarilla de donde salieron”, fue la dura crítica de Salinas contras el Estado mexicano.
“La libertad significa que existe el bien y el mal, la clave del mal es la igualdad y el subyacente es la envidia. Los zurdos no pueden ver que alguien tiene éxito porque ellos no han podido salir adelante, esa envidia no la pueden manejar y ahí viene el tema del robo y despojo, y como la gente no se deja despojar, viene el autoritarismo”, añadió, arrancando aplausos de los asistentes.

Poseer armas z Salinas Pliego se mostró en favor del derecho a poseer armas; “En nuestros países hemos sido muy laxos, hemos dejado la defensa de la vida y la propiedad en manos de autoridades corruptas… Debemos tener el derecho a tener armas y defendernos”.
“En México pensamos que ya habíamos llegado a una situación democrática. Había una competencia entre partidos, había una transición ordenada del poder, y resulta que ya regresamos al régimen del partido único, liderado por el hijo del gran líder y nos ha dejado totalmente indefensos, sin un Poder Judicial autónomo”, dijo.
Durante su discurso, ante lideres de Latinoamérica, consideró que “si el entorno donde estamos, se está viniendo abajo, como sucede en mi país en estos momentos, nuestros negocios también se van
nada’, dice a bitcoiners
AGENCIA REFORMA
Zócalo | Ciudad de México
El Presidente electo de Estados Unidos, Donald Trump, se atribuyó el hito de que el valor del bitcoin superara 100 mil dólares por primera vez.
Ayer, la criptomoneda logró cotizar a 102 mil 707 dólares en los mercados bursátiles, aunque al final de la jornada cerró en 99 mil 029, un aumento de 1.18% respecto al miércoles. “¡Felicidades bitcoiners! ¡100 mil dólares! ¡De nada! Juntos haremos Estados Unidos gran-
de otra vez”, escribió Trump en la red Truth Social. Desde el triunfo de Trump en las elecciones del 5 de noviembre, el bitcoin se ha apreciado más de 50 por ciento.
Expertos consideran que la elección de Paul Atkins, partidario de las criptomonedas, para ser el próximo presidente de la Comisión de Bolsa y Valores de Estados Unidos (SEC, por sus siglas en inglés) impulsó al bitcoin al récord histórico de 100 mil dólares, dado que una perspectiva de regulaciones más la-
Cierra en 20.20 pesos por dólar Peso suma 3 días de
EL UNIVERSAL Zócalo | Ciudad de México
La divisa mexicana en los mercados internacionales concluyó alrededor de 20.20 pesos por dólar, lo que significó una apreciación de 0.38% o 8 centavos respecto a la jornada anterior, hilando tres sesiones de ganancias, de acuerdo con información de Bloomberg. El dólar al menudeo terminó este jueves en 20.68 pesos a la venta en las ventanillas de las sucursales de Banamex, 0.58% o 12 centavos por arriba del cierre del miércoles.
para abajo”. Por ese motivo, exhortó a los empresarios a invertir en el “cambio cultural”, financiando a medios, intelectuales y causas valiosas. No hacerlo significa malentender el ahorro, enfatizó. “No podemos bajar la guardia, todos los días hay que sembrar la semilla del cambio cultural, defendiendo esta idea de libertad se crea la prosperidad”.
Asumir responsabilidad Ante un público en el que se encontraban empresarios, jóvenes y políticos, dijo que todo el mundo debe asumir responsabilidad en el progreso. “No son nada más los políticos, no sólo son los empresarios; todos somos responsables de sacar esto adelante”.
Finalmente dijo que a pesar de todo, se siente optimista, pues “somos países jóvenes y los jóvenes no se van a quedar cruzados de brazos esperando a que llegue alguien a resolverles la vida. Van a tomar la vida en sus manos y se van a formar una vida”.

xas entusiasmó a los operadores. El actual presidente de la SEC, Gary Gensler, tomó medidas enérgicas contra los activos digitales después de que la caída del mercado en 2022 sacara a la luz prácticas fraudulentas y provocara costosas quiebras.

desarrollar.
Simplificarían trámites
AGENCIA REFORMA
Zócalo | Ciudad de México
El Gobierno de México traza una nueva estrategia para captar mayores flujos de Inversión Extranjera Directa (IED) a través de una promoción más visible, menores trámites y una selección específica de proyectos a desarrollar, aseguró la Secretaría de Economía (SE).
“¿Cómo traer inversión al país? Tenemos una estrategia de salir a traer inversión, que no fue el enfoque recientemente. Estuve en Italia hace una semana viendo empresas que tienen proyectos en México que queremos ver cómo se desarrollan.
“De esa manera estamos construyendo esta nueva estrategia de salir a buscar proyectos de inversión para que se faciliten”, afirmó Vidal Llerenas, subsecretario de Industria y Comercio de la SE, en un seminario organizado por la Comisión Económica pa-
Tiene
La apreciación del peso sucede a la par del debilitamiento generalizado del dólar estadunidense de 0.41%, de acuerdo con el índice ponderado, pues el mercado se mantiene a la espera de la publicación de los indicadores laborales de EU hoy viernes, explicó Gabriela Siller, directora de análisis económico y financiero de grupo Base. En el mercado cambiario, la mayoría de las divisas ganaron terreno, siendo las más apreciadas: el rublo ruso con 4.01%, la corona checa con 1.07%, el zloty polaco con 1.01%, el florín húngaro con 0.83%, el rand sudafri-
cano con 0.81% y la corona danesa con 0.72 por ciento. El mercado de capitales cerró la sesión con resultados mixtos entre los principales índices bursátiles a nivel global. En EU, se observaron pequeñas pérdidas debido al nerviosismo del mercado sobre el reporte de empleo el día de mañana.
El Dow Jones perdió 0.55%, cayendo en tres de las últimas cuatro sesiones. El Nasdaq mostró una ligera baja de 0.18%, cortando una racha de cuatro sesiones al alza. Por su parte, el S&P 500 retrocedió 0.19%, rompiendo una racha de cuatro se-
ra América Latina y el Caribe (Cepal).
Explicó que se trabaja con los secretarios de Desarrollo Económico de cada entidad para emplear un mecanismo de coordinación que permita dar seguimiento a cada proyecto, conocer su estatus y ayudar a agilizar los trámites. “Muchas inversiones no se concretan, se alargan o no tienen la dimensión adecuada porque hay una serie de trámites federales y locales, así como tiempos. Podríamos hacerlo más rápido y la inversión sería mayor”, enfatizó. Llerenas expuso que una de las claves para captar mayor IED está en escoger el tipo de proyecto a desarrollar. “Nos gustaría que haya inversión en microprocesadores, en la cadena de baterías. Buscar otras áreas con grandes oportunidades, como dispositivos médicos y con alto contenido tecnológico, como aeroespacial o almacenamiento de datos”, detalló.
que ‘elegir equipo’
Debe
México definir posición ante China
AGENCIA REFORMA
Zócalo | Ciudad de México
Ante el nuevo Gobierno de Estados Unidos y un escenario polarizado, México debe definir su posición comercial ante China, de acuerdo con especialistas.
Roberto Zapata, exembajador de México ante la Organización Mundial del Comercio (OMC), apuntó que México tiene que aclarar su posición respecto a China para mostrarla a sus socios comerciales.
“Hay que definir otra serie de acciones, por ejemplo, en lo que hace al rol que debe jugar China en nuestra política comercial más amplia”, consideró.
Parte del éxito de la productividad de México responde a los insumos de origen chino, por lo que las acciones que se determinen deben tomarse con el análisis correspondiente y de manera escalonada para no encarecer costos en el país, dijo el también socio de Ansley Consultores Internacionales.
Juan José Gómez, exembajador de México en Canadá, señaló que ante el contexto geopolítico actual, México tendrá que hacer algo desagradable que es inclinarse hacía un jugador.
“México tendrá que hacer lo que no le gusta, que es tomar partido, tomar decisiones difíciles”, expresó Gómez Camacho. Relevancia comercial La postura de México acerca de China tendrá que tomarse desde la perspectiva de la relevancia comercial con su principal socio que es Estados Unidos y también con Canadá.
Roberto Velasco, jefe de la Unidad para América del Norte de la SRE, expresó durante su participación en un foro que uno de los objetivos es que tanto Canadá como EU entiendan que ellos han sido los principales beneficiados por las inversiones chinas y que México también puede participar de esa ventaja comercial.
“Las inversiones que llegan a EU y Canadá desde China son mucho mayores que las que llegan a México. Por eso creo que México podemos decir: ¿por qué es legítimo que ustedes se beneficien de estas inversiones?
“Serán necesarias muchas conversaciones en las que tendremos que analizar puntos muy sutiles y buscar puntos de entendimiento sobre algunas cuestiones”, consideró Velasco.

z El dólar al menudeo terminó este jueves en 20.68 pesos a la venta en las ventanillas de las sucursales de Banamex.
vel desde el 8 de noviembre. Al
siones de ganancias. En México, el Índice de Precios y Cotizaciones de la BMV cerró la sesión con una ganancia de 0.99%, ligando cuatro sesiones al alza, algo que no ocurría desde septiembre, llevando al índice a cerrar en su mayor ni-